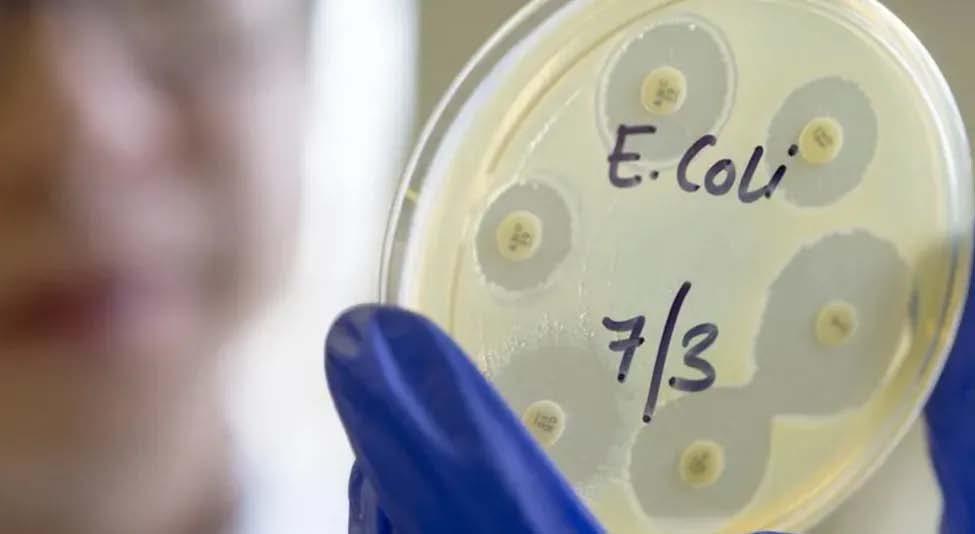

‡e_bvjMªxY Ges ‡÷cwb Avm‡b ivwebv Lvb‡K ‡fvU ‡`Iqvi Avnevb
‡W¯‹ wi‡cvU©t 4 RyjvB mvavib wbe©vP‡b ‡e_bvjM«xY Ges ‡÷cwb Avmb ‡_‡K wjev‡ij ‡Wgy‡µU c«v_©x ivwebv‡K ‡fvU w`b, we«wUk evsjv‡`wk ivwebv ev½vjx‡`i n‡q cvj©v‡g‡›U K_v ej‡eb, KwgDwbwUi K_v Zy‡j ai‡eb, me©`v
RbM‡bi cv‡k _vK‡eb Ggb c«wZk«ywZ e¨³ K‡i msev` m‡¤§jb K‡ib ivwebv Lvb| ivwebv Lv‡bi c‡¶ msev` m‡¤§j‡b Dcw¯’Z wQ‡jb KwgDwbwU ‡bZv wk¶vwe` nvmbvZ ‡nv‡mb GgweB, mv‡eK KvDwÝjvi AveRj wgqv, AvdRvj ‡nvmvBb wmwÏKx c«gyL| msev` m‡¤§j‡b ejv nq, ivwebv Lv‡bi i‡q‡Q Rb‡mev Ges KwgDwbwU A¨vW‡fv‡Kwmi AmvaviY ‡iKW© c«Pyi AwfÁZv Ges `¶Zv| ivwebv Lvb `xN© 12 eQi KvDwÝji wnmv‡e `vwqZ¡ cvjb K‡i‡Qb| wZwb ‡÷cwbi w¯§w_ w÷«U c«vBgvwi ¯‹yj Ges k¨vWI‡q‡ji gyj‡ewi Mvj©m ¯‹y‡ji ¯‹yj Mfbi« wnmv‡e KvR K‡i‡Qb| c«v³b nvDwRs K¨vwe‡bU m`m¨ wnmv‡e, wZwb ‡nvqvBUP¨v‡cj wfkb‡K ‡bZ…Z¡ w`‡qwQ‡jb, D‡j L‡hvM¨ msL¨K Ni wbg©vY K‡iwQ‡jb Ges Ikvb G‡÷U Ges e¨vKIqvj wi‡Rbv‡ikb gZ c«avb cybR©xeb c«Kí¸‡jv cwiPvjbv K‡iwQ‡jb| Zvi mnRjf¨Zvi Rb¨ cwiwPZ, ivwebv wQ‡jb Ab¨Zg mwµq KvDwÝji, D”P cwigv‡Y ‡KmIqvK© DÌvcb K‡iwQ‡jb| wZwb ‡U‡b›U, wjR‡nvìvi Ges M…ngvwjK‡`i AwaKv‡ii Rb¨ KvR K‡iwQ‡jb, bvBd µvB‡gi weiæ‡× c«Pvi K‡iwQ‡jb Ges wk¶vg~jK cwi‡lev‡Z c«‡e‡ki Rb¨ ZiæY‡`i Ges Zv‡`i cwievi‡K mnvqZv I DØy×

K‡i‡Qb| wZwb K÷ Ad wjwfs Ges ‡KvwfW19 Gi c«fve ‡gvKvwejv Kivi c«Kí¸‡jv cwiPvjbv K‡i‡Qb| ivwebv Lvb Zvi ¯^vgxmn ‡÷cwb‡Z 30 eQ‡iiI ‡ewk mgq a‡i emevm Ki‡Qb, Zvi mš—vbiv jÛb nvmcvZv‡j Rb¥M«nY K‡i‡Q| eZ©gv‡b wZwb GKwU P¨vwiwU AM©vbvB‡Rk‡b KvR K‡ib
Ges GKRb wd«j¨vÝ GbwmwU‡R ‡Mvì ÷¨vÛvW© mvsevw`K wnmv‡e KvR K‡ib| wdbvwÝqvj UvBgm, MvwW©qvb, Bqvû wbDR, BwÛ‡cb‡W›U, IqvwksUb ‡cv÷ mn Ab¨vb¨ Rbwc«q msev` gva¨‡g wZwb ‡jLvwjwL K‡i‡Qb| GKB mv‡_ wZwb GKRb ‡jLK Ges eZ©gv‡b wZwb evK©‡eK BDwbfvwm©wU‡Z GgG Ki‡Qb|
Bsj¨v‡Û
‡W¯‹ wi‡cvU©t ‡ewkifvM Bsj¨vÛ Ry‡o GKwU njy` Zvc ¯^v¯’¨ mZK©Zv Kvh©Ki n‡q‡Q, GB mßv‡n ZvcgvÎv 31 wWM«x ‡mjwmqv‡m (88 Gd) ‡cŠuQv‡bvi Avkv Kiv n‡”Q
BD‡K ‡nj_ wmwKDwiwU G‡RwÝ (BD‡KGBPGmG) Ges ‡gU Awdm
GB mZK©Zv Rvwi K‡i‡Q, hv e… n¯úwZevi weKvj ch©šÍ DËi-c~e© AÂj e¨ZxZ mg¯— GjvKvi Rb¨ Kvh©Ki i‡q‡Q|
GB mßv‡ni Rb¨ 31 wWM«x ‡mjwmqvm ch©š— D”P ZvcgvÎvi c~e©vfvm ‡`Iqv n‡q‡Q, Ges BD‡KGBPGmG
ÒAiw¶Z e¨w³‡`i g‡a¨ g…Z¨yi SyuwK e…w× Ges Af¨š—ixY cwi‡ek Lye
Dò nIqvi m¤¢vebv e…w×Ó m¤ú‡K© mZK© K‡i‡Q|
AviGbGjAvB, b¨vkbvj ‡Kv÷IqvP Bbw÷wUDkb Ges
Ab¨vb¨ Riæix cwi‡lev¸wj gvivZ¥K
VvÛv R‡ji kK m¤ú‡K© mZK© K‡i
ivwebv Lvb Rvbqvwi 2024 mv‡j Zvi
c«PviYv ïiæ K‡ib, hv ‡e_bvj wM«b
Ges ‡÷cwbi mg¯— 8wU IqvW© Kfvi K‡i| wZwb ‡fvUvi‡`i Kv‡Q ‡cŠuQv‡bvi ‡¶‡Î Ab¨vb¨ c«v_©x‡`i ‡_‡K A‡bK GwM‡q i‡q‡Qb| ivwebv Lvb e‡jb,Ò‡e_bvj wM«b Ges ‡÷cwb‡Z, Avwg mewKQy ‡`‡LwQ wmwUi m¤ú` ‡_‡K ¯’vbxq msM«vg ch©š—| Avgvi e¨w³MZ AwfÁZv¸wj Avgv‡K Ab¨v‡qi weiæ‡× jovB Ki‡Z ‡c«iYv ‡`q| GKRb gv wnmv‡e, Avwg eyS‡Z cvwi Avgv‡`i wkï Ges hyeK‡`i P¨v‡jĸwj, we‡klZ ‡Kvwf‡Wi c‡i| Avwg Avgv‡`i ZiæY‡`i Rb¨ AviI fv‡jv my‡hv‡Mi Rb¨ c«Pvi Ges c«‡Póv
Kie|
GKwU ‡QvU `j wnmv‡e, Avgiv ‡jevi Ges KbRvi‡fwUf cvwUi« ‡P‡q ‡ewk AR©b KiwQ| Avgv‡`i ‡fvUviiv Ggb G‡KKRb wi‡c«‡R‡›UwUf cv‡eb hviv Avgv‡`i cvwU© Ges msm` Df‡qi g‡a¨ cwieZ©b Avb‡Z cv‡ib| hLb Avgv‡`i KwgDBwbwUi c‡¶ `vuov‡bvi K_v Av‡m, Avwg c`‡¶c wb‡Z fq cvB bv| ZvQvov, Avgv‡K mv‡cvU© w`‡j Avcbviv Ggb GKRb Ggwc cv‡eb ‡h ‡e_bvj wM«b Ges ‡÷cwb wbe©vPbx GjvKvi ‡K›`«¯’‡j emevm K‡ib| Avwg 30 eQ‡iiI ‡ewk mgq a‡i GLv‡b evm KiwQ; Avgvi mš—vbiv jÛb nvmcvZv‡j Rb¥M«nY K‡i‡Q Ges ¯’vbxq
ZvcgvÎv 31 wWMªx ‡mjwmqv‡m ‡cŠuQ‡Z cv‡i, ‡`k Ry‡o njy`
mZK©Zv Rvwi

e‡j‡Q ‡h Mi‡gi w`‡b VvÛv nIqvi Rb¨ R‡j Svuc ‡`Iqv k¦vmK‡ói KviY n‡Z cv‡i |
AvenvIqv Awd‡mi AvenvIqvwe` wjqvg GmwjK e‡j‡Qb, ‡mvgevi Òc«Pyi ‡iŠ‡`«v¾¡j gš¿Ó Ges m‡e©v”P ZvcgvÎv 28 wWM«x ‡mjwmqvm mn
‡ewkifvM ﮋ AvenvIqv ‡`Lv hv‡e| g½jevi, cwðg ¯‹Uj¨vÛ Ges DËi Avqvij¨v‡Û cwiw¯’wZ ‡gNjv Ges
¯‹y‡j wM‡q‡Q| wjev‡ij ‡W‡gvKª¨vUiv `yBevi hy×weiwZi c‡¶ Ges Awej‡¤^ ¯^vaxb wdwjw¯Íb ivó«‡K ¯^xK…wZ ‡`Iqvi Rb¨ ‡fvU w`‡q‡Q| Avgv‡K wbe©vwPZ Ki‡j, Avwg c«wZk«ywZ w`w”Q ‡h UvIqvi n¨vg‡jU‡m me‡P‡q e¨¯— msm`xq mvR©vwi n‡e| nvDwRs, fvov, we‡kl Pvwn`vm¤úbœ wkï Ges c«vßeq¯‹, ¯‹yj Ges Awfevm‡bi wel‡q D‡ØM Avgvi Rb¨ Mfxifv‡e ¸iæZ¡c~Y©| GKRb KvDwÝji wnmv‡e Avgvi ‡iKW© wb‡RB K_v e‡j, Avwg me‡P‡q e¨¯— mvR©vwi cwiPvjbv K‡iwQjvg| GKwU `j wnmv‡e, Avgiv A‡bK wKQy AR©b Ki‡Z cvwi, wKš‘ GKwU KwgDwbwU wnmv‡e, Avgiv AviI ‡ewk wKQy AR©b Ki‡Z cvwi| ïaygvÎ MvRv m¤ú‡K©B bq, eis mKj ai‡bi RwUj ivR‰bwZK mgm¨vi e¨cv‡iB Avwg ‡mv”Pvi| Avgv‡`i RbMY Ges KwgDwbwU memgq Avgvi Kv‡Ri ‡K›`«we›`y‡Z i‡q‡Q GKRb wbe©vPbx Ggwc nIqv ïay GKwU `vwqZ¡ bq; GwU Avgvi A½xKvi|Ó wjev‡ij ‡W‡gvKª¨vU c«wZk«ywZmg~n: Avš—R©vwZK: ¯^vaxb wdwjw¯—b ivó«‡K Awej‡¤^ ¯^xK…wZ w`‡e| mnvqZv c«‡ek, wRw¤§‡`i gyw³ Ges `yBivó« mgvav‡bi AM«MwZi Rb¨ Awej‡¤^ wØcvw¶K hy×weiwZi AvnŸvb| hy×weiwZi c‡¶ ‡fvU w`b, Bmiv‡q‡j A¯¿ wewµ eÜ Kiæb Ges `yBRb Bmiv‡qwj gš¿xi Dci wb‡lavÁv Av‡ivc Kiæb| 2017 mvj ‡_‡K, wjev‡ij ‡W‡gvKª¨vU Ggwc jvqjv ‡gvivb, c«_g Ges GKgvÎ we«wUk wdwjw¯—wb Ggwc, wdwjw¯—b ivó«‡K ¯^xK…wZ ‡`Iqvi Rb¨ c«wZ eQi GKwU c«¯—ve DÌvcb K‡i‡Qb|
‡Nvjv‡U n‡q DV‡e e‡j Avkv Kiv n‡”Q|
wKQy e…wó n‡e DËi Bsj¨vÛ Ry‡o, Ges eR«cvZ n‡Z cv‡i, Z‡e ‡`‡ki evwK Ask ÒAv‡iv ‡iv`Ó ‡`L‡Z cv‡e Ges gvSvgvwS ‡_‡K D”P 20 wWM«x ‡mjwmqvm ch©šÍ ZvcgvÎv _vK‡e
wgt GmwjK e‡j‡Qb ‡h eyaevi `w¶Y c~‡e© m‡e©v”P 30 wWwM« ‡mjwmqvm mn GLb ch©šÍ me‡P‡q Dò w`b n‡Z cv‡i| e…n¯úwZevi mviv‡`‡k ‡gN I e…wói c«v`yf©v‡ei c~e©vfvm mn AvenvIqvi wech©q ‡`Lv w`‡Z cv‡i| AvenvIqvwe` e‡jwQ‡jb ‡h eR«SoÓ nIqvi m¤¢vebv i‡q‡Q| e…n¯úwZevi ZvcgvÎv Òe¨vcKfv‡e DòÓ _vK‡e e‡j Avkv Kiv n‡”Q, wKQy GjvKvq 31 wWM«x ‡mjwmqvm ch©š— D”PZv ‡`Lv hv‡”Q
evsjv msjvc wi‡cvU©t ‡jevi ‡bZv
‡Kqvi ÷vigvi e‡j‡Qb wZwb
c«avbgš¿x n‡j A‰ea evsjv‡`wk‡K
wbR ‡`‡k ‡diZ cvVv‡eb| MZKvj
`¨v mvb Av‡qvwRZ Bwg‡M«kb cwjwm wb‡q Av‡jvPbvi GK ch©v‡q ‡Kqvi ÷vigvi‡K c«kœ Kiv
n‡j wZwb evsjv‡`wk BwgM«v›U‡`i
D`vnib wn‡m‡e Zy‡j a‡i e‡jb
‡h mKj A‰ea BwgM«v›U G ‡`‡k
Av‡Q Zv‡`i‡K ‡diZ cvVv‡bv
n‡”Q bv| wZwb c«avbgš¿x nIqvi c‡ii w`b ‡_‡K G‡`i‡K wegvb K‡i ‡diZ d¬vB‡U cvwV‡q w`‡eb| ÷vigvi i“qvÛv w¯‹g evwZj K‡i w`‡eb| wgt ÷vigv‡ii evsjv‡`wk gvBM«v›U‡`i wb‡q ‡b‡MwUf gš— e¨ ‡ek mgv‡jvPbvi Rb¥ w`‡q‡Q| we«wUk evsjv‡`wk 4 Rb Ggwc eZ©gv‡b ‡jevi cvwU©‡Z Av‡Qb, ZvQvov KwgDwbwUi GKUv e…nr Ask ‡jevi cvwU©‡K mv‡cvU© K‡ib, Giv ‡Kvb wKQy ev` wePvi bv K‡iB ‡jevi‡K ‡fvU w`‡q _v‡Kb| AZP ‡mB ‡jevi ‡bZvi evsjv‡`wk‡`i wb‡q Giæc ‡b‡MwUf gš—e¨ ‡ek mgv‡jvwPZ n‡q‡Q| A‰ea BwgM«v›U‡`i kx‡l© _vKv BwÛqv, bvB‡Rwiqv, Pvqbv cvwK¯—vb, wR¤^vey‡q, Nvbv, Avj‡ewbqv g‡Zv

‡`k _vKvi ciI evsjv‡`k‡K ‡Kb ‡jevi ‡bZv ÷vigvi bR‡i Avb‡jb Zv c«kœwe×| ‡jevi ‡bZv ÷vigv‡ii e³‡e¨i mgv‡jvPbv K‡i‡Qb ‡e_bvj M«xY
I ‡÷cwb Avm‡bi wje‡Wg c«v_©x ivwebv Lvb| wZwb e‡j‡Qb, Avgv‡`i c~e© cyiæliv hviv G‡`‡k G‡m‡Qb
Zv‡`i A‡b‡KB ‡jevi cvwUi« mv‡_
wfmvq 18,000 BbKv‡gi ‡_«k‡nvì 29,000 cvD‡Û wba©vib K‡i‡Q KbRvi‡fwUf miKvi, cieZ©x eQi GUv AviI ‡e‡o c«vq 39000 cvDÛ n‡e, wje‡Wg BbKv‡gi ‡_«knì Zy‡j w`‡q 18,000 cvD‡Û wb‡q Avm‡e| d‡j ¯úvDm ev wW‡c‡Û›Uiv mn‡R ‡`k ‡_‡K Avm‡Z cvi‡eb| wg‡mm Lvb AviI e‡jb, Avgiv wje‡W‡gi c¶ ‡_‡K GKUv ‡dqvi Bwg‡M«kb cwjwm ivL‡ev, ‡hfv‡e ‡jevi ‡bZv evi evi evsjv‡`wk‡`i AvDU K‡i ‡`Iqvi K_v ej‡Qb ,Avgiv GUv Kie bv| Avwg Ggwc n‡j Avgvi evsjv‡`wk KwgDwbwU mn Ab¨ KwgDwbwUi hviv G‡`‡k G‡m‡Qb , GmvBjvg c«v_©x Av‡Qb Avwg Zv‡`i‡K msm‡` Zy‡j ai‡ev, ‡Kbbv c«‡Z¨‡Ki G‡`‡k _vKvi AwaKvi Av‡Q, Avwg GUv Zy‡j ai‡ev, Zv‡`i AwaKvi c«wZôvq jovB Ki‡ev , Kvib Avgiv KwgDwbwUi mevB‡K G‡K A‡b¨ Rvwb , Avgiv KvD‡K Qvo‡Z cvwibv , mevB Avgv‡`i AvcbRb, Zv‡`i cv‡k `vuov‡bv Avgv‡`i ‰bwZK `vwqZ¡| ivwebv e‡jb evsjv‡`wk, ‡mvwgqv mn Ab¨vb¨ KwgDwbwUi hviv GLv‡b Av‡Qb Zv‡`i cv‡k `vuov‡ev| evsjv‡`wk BwgMªv›U‡`i
m¤ú…³| ÷vigvi Bwg‡M«kb cwjwm wb‡q AvjPbv K‡i‡Qb, wKš‘ GLv‡b
evsjv‡`wk‡`i D‡jL K‡i wZwb wK eySv‡Z ‡P‡q‡Qb, ‡jevi cvwU©‡Z Avgv‡`i gvby‡li ‡Kvb `vg ‡bB?
Avgv‡`i evev gv hviv Av‡M G‡m‡Qb
Zviv we«wUk ‡mvmvBwU‡Z A‡bK
Kw›U«weDkb K‡i‡Qb| BD‡ivwcqvb fvB ‡evb hviv G‡m‡Qb ZvivI we«wUk
‡mvmvBwU‡Z Kw›U«weDkb K‡i‡Qb| ‡jevi ‡bZvi GB e³e¨ M«nb‡hvM¨ bv| ivwebv e‡jb, ‡jevi cvwU©‡Z A‡bK wmwbqi ‡g¤^vi Av‡Qb hviv evsjv‡`wk, UvIqvi n¨vg‡jU‡mi ‡e_bvj M«xY Ges ‡÷cwb Avgiv me mgq BwgM«v›U KwgDwbwU‡K ¯^vMZ Rvwb‡qwQ| wje‡Wg GKUv ‡dqvi Bwg‡M«kb wm‡÷g Pvq, cvwievwiK
wcª‡Ým A¨vwb nvmcvZv‡j fwZ©
‡W¯‹ wi‡cvU©t evwKsnvg c¨v‡jm Rvwb‡q‡Q, My‡P÷vikvqv‡i Zvi G‡÷‡U mvgvb¨ AvNv‡Zi c‡i wc«‡Ým iq¨vj‡K nvmcvZv‡j fwZ© Kiv n‡q‡Q|
wc«‡Ým A¨vwb, 73, Zvi M¨vUK¤^ cvK© G‡÷‡U GKwU NUbvi c‡i m¤ú~Y© Ges `ªyZ cybiæ×vi Ki‡eb e‡j Avkv Kiv n‡”Q, GKwU wee… wZ‡Z ejv n‡q‡Q|
wZwb Òch©‡e¶‡Yi Rb¨ mZK©Zvg~jK e¨e¯’v wnmv‡eÓ we«÷‡ji mvD_wgW nvmcvZv‡j i‡q‡Qb|
ÒivRv‡K Nwbôfv‡e AewnZ Kiv
n‡q‡Q Ges `ªyZ cybiæ×v‡ii Rb¨ ivRKygvix‡K Zvi wc«qZg fvjevmv Ges ïfKvgbv cvVv‡bvi Rb¨ cy‡iv ivRcwiev‡ii mv‡_ ‡hvM`vb
K‡i‡Q,Ó wee…wZ‡Z ‡hvM Kiv n‡q‡Q|
AvNv‡Zi KviY wbwðZ bq, Z‡e

GwU ‡Nvovi gv_v ev cv ‡_‡K m¤¢ve¨ c«fv‡ei mv‡_ mvgÄm¨c~Y© e‡j ‡evSv hvq| wc«‡Ým iq¨vj GB mßv‡ni ‡k‡l KvbvWv mdi ïiæ Ki‡eb e‡j Avkv Kiv n‡qwQj| KvbvwWqvb wgwWqv Rvwb‡q‡Q ‡h wZwb wbDdvDÛj¨v‡Û GKwU hy× ¯§…wZ‡mŠ‡a GKwU Abyôv‡b Ask ‡bIqvi K_v i‡q‡Q| mv¤cÖwZK wW-‡W ¯§i‡Y wc«‡Ým A¨vb d«v‡Ýi ‡e‡q· Iqvi Kei¯’v‡b c«exY Ges Zv‡`i cwiev‡ii mv‡_ ‡`Lv K‡iwQ‡jb| wc«‡Ým A¨vwb me‡P‡q K‡Vvi cwik«gx ivRcwiev‡ii GKRb wnmv‡e cwiwPZ, A‡bK e¨¯—Zv enb K‡ib|
‡bvbb‡mÝ c×wZi mv‡_ wgwjZ Zvi cvewjK wWDwUi Abyf~wZ RbgZ ‡cvj¸wj‡Z avivevwnKfv‡e D”P Aby‡gv`‡bi ‡iwUs mn me‡P‡q Rbwc«q ivRcwiev‡ii GKRb wnmv‡e Zvi gh©v`v‡K mnvqZv K‡i‡Q|
wZwb ‡Nvovi c«wZ Zvi AvM«n Ges Ak¦v‡ivnx µxovq Zvi K…wZ‡Z¡i Rb¨ cwiwPZ, 1976 mv‡j gw›U«‡j Awjw¤ú‡K c«wZØwb&ØZv Kivi Rb¨ ivRcwiev‡ii c«_g m`m¨ n‡qwQ‡jb|
wc«‡Ým A¨vwb n‡jb wØZxq GwjRv‡e_ Ges wc«Ý wdwj‡ci wØZxq mš—vb Ges 1950 mv‡j hLb wZwb Rb¥M«nY K‡iwQ‡jb ZLb wZwb wmsnvm‡b Z…Zxq wQ‡jb| wZwb GLb DËivwaKv‡ii mvwi‡Z 17 Zg| wZwb `yevi we‡q K‡i‡Qb| Zvi c«_g ¯^vgx, K¨v‡Þb gvK© wdwjcm, Zvi `yB mš—vb wcUvi Ges Rvivi wcZv| Zvui wØZxq ¯^vgx fvBmGWwgivj m¨vi wU‡gvw_ j‡iÝ|
hy³iv‡R¨ cª‡e‡ki D‡Ï‡k¨ d«v‡Ý Awfevmxiv Ô‡jevi miKv‡ii Rb¨ A‡c¶v Ki‡QbÕ
‡W¯‹ wi‡cvU©t DËi d«v‡Ýi Awfevmxiv ej‡Qb ‡h iæqvÛv w¯‹g evwZj Kivi Rb¨ miKv‡ii Rb¨ A‡c¶v Ki‡Q , m¨vi wKi ÷vigvi c«wZk«ywZ w`‡q‡Qb ‡h ¶gZvq ‡M‡j iæqvÛv w¯‹g evwZj Ki‡eb|
`¨ ‡UwjM«v‡di mv‡_ K_v ejvi mgq, wKQy Awfevmx e‡j‡Qb ‡h Zviv bZyb miKvi bv Rvb‡j ‡QvU ‡bŠKvq P¨v‡bj cvi nIqvi SyuwK ‡b‡e bv| ‡jevi ¶gZvq wRZ‡j m¨vi wKi Òc«_g w`‡bÓ iæqvÛv wbe©vmb d¬vBU evwZj Kivi c«wZk«ywZ w`‡q‡Qb|
WvbKv‡Ki« Kv‡Q Mª¨vÛ-wmš’ K¨v‡¤úi ‡ewkifvM Awfevmx hv‡`i mv‡_ `¨
‡UwjM«vd ‡hvMv‡hvM K‡iwQj Zviv
iæqvÛv w¯‹g m¤ú‡K© RvbZ Ges
e‡jwQj ‡h Zviv wbe©vm‡bi ûgwK wb‡q wPwš—Z|
hw`I ‡KD ‡KD e‡jwQj ‡h Zviv my‡hvM ‡c‡j µwms‡qi ‡Póv Ki‡e, Ab¨iv e‡j‡Q ‡h Zviv 4 RyjvB
AbywôZ nIqv wbe©vP‡bi c‡i
A‡c¶v Ki‡Z cQ›` Ki‡e|
Awfevmx‡`i gš—e¨ G‡m‡Q hLb
Fwl mybvK ‡mvgevi e‡jwQ‡jb:
ÒZviv ÷vigvi miKv‡ii Rb¨
K¨vjvB‡m mvwie×fv‡e `vuwo‡q
Av‡Q hv‡Z Zviv GLv‡b Avm‡Z cv‡i Ges GLv‡b _vK‡Z cv‡i|Ó
‡nvg Awd‡mi cwimsL¨vb ‡`Lvq ‡h iæqvÛvq wbe©vm‡bi AbywgZ c«wZeÜKZv m‡Ë¡I GB eQ‡ii c«_g
Qq gv‡m ‡iKW© msL¨K Awfevmx P¨v‡bjwU AwZµg K‡i‡Q|
GB eQi c«vq 12,901 Rb ‡jvK hy³iv‡R¨ ‡cŠu‡Q‡Q MZ eQ‡ii Zyjbvq 17 kZvsk ‡ewk Ges 2022 mv‡j Av‡Mi ‡iK‡W© AvU kZvsk ‡ewk| `¨ ‡UwjM«v‡di Rb¨ ‡jLv, ‡Rgm wK¬fviwj, ‡nvg ‡m‡µUvwi, e‡j‡Qb Awfevmx‡`i gš—e¨ c«_g c«gvY w`‡q‡Q ‡h Ò‡PvivPvjvbKvix `j¸wj
BwZg‡a¨ GKwU ‡jevi miKv‡ii Aaxi c«Z¨vkvq Zv‡`i Kvb wQu‡o‡Q hv A‰ea Awfevmx‡`i AfqviY¨ wbwðZ Ki‡eÓ|
wZwb e‡jwQ‡jb ‡h Awfevmx‡`i Avk«q `vwei AbygwZ ‡`Iqvi Rb¨ ‡jevi cwiKíbvi cwie‡Z© iæqvÛvi c«wZeÜKZv Ges hy³iv‡R¨ Avk«q `vwe‡Z GKwU eK w`‡q ‡bŠKv¸wj‡K _vgv‡bv ‡h‡Z cv‡i, hv ÒP¨v‡bj Ry‡o wec¾bK hvÎv
Kivi Av‡e`b‡K Awej‡¤^ evwo‡q
Zyj‡eÓ|

GQvovI `¨ ‡UwjM«v‡di Rb¨ ‡jLv,
B‡q‡fU Kycvi, Qvqv ¯^ivó« mwPe, e‡j‡Qb ‡h wgt mybvK hw` wek¦vm
Ki‡Zb ‡h iæqvÛv w¯‹g KvR Ki‡e,
Z‡e GKwU d¬vBU DÇq‡bi Av‡M
wZwb wbe©vP‡bi WvK w`‡Zb bv|
wZwb e‡jwQ‡jb ‡h GwU GKwU
ÒKbÓ hv ‡KejgvÎ GK kZvsk
Avkqc«v_©x‡K Kfvi Ki‡e, GKwU
Ò‡nv‡Uj mvaviY ¶gvÓ ‰Zwi Ki‡e, ‡hLv‡b Awfevmx‡`i Awbw`©óKv‡ji
Rb¨ ivLv n‡e|
wZwb c«wZk«ywZ w`‡qwQ‡jb ‡h
‡jevi-Gi bZyb mxgvš— wbivcËv
KgvÛ, 1,000 bZyb cywjk, Gg 15
‡Mv‡q›`v Kg©KZ©v Ges Z`šÍKvixiv ‡jvK-‡PvivPvjvbKvix `j¸wj‡K
aŸsm Ki‡e Ges e‡jwQ‡jb ‡h
Ab¨vb¨ BD‡ivcxq cywjk evwnbxi
mv‡_ bZyb wbivcËv Askx`vwiZ¡ Òc«_g ¯’v‡b ‡bŠKv¸wj‡K divwm
DcK~‡j ‡cŠuQv‡bv eÜ Ki‡e Ges ‡PvivKvievwi‡`i KvivMv‡i Avbyb|Ó
g½jevi Zv‡`i Awfevmb bxwZ wb‡q weZK© Kivi Rb¨ Gjwewm‡Z wbe©vPbx c«PviYvq c«_gev‡ii g‡Zv `yB ivRbxwZwe` gy‡LvgywL n‡”Qb|
‡mvgevi iv‡Z, wgt mybvK Avµg‡Y
wM‡qwQ‡jb, `vwe K‡iwQ‡jb ‡h ‡jevi A‰ea Awfevmb ÒmvaviY ¶gvÓ Ges BBDi mv‡_ ÒmyBUnvU© wWjÓ hy³ivR¨ gnv‡`k ‡_‡K AviI ‡ewk A‰ea Awfevmx‡`i wb‡q ‡h‡Z ‡`L‡e|
wZwb e‡jwQ‡jb: ÒZvB GB wbe©vP‡b GUvB ¯úó cQ›` i¶Ykxjiv, hviv
‡`wL‡q‡Q ‡h Zviv ‡PvivPvjvb P‡µi
g‡Wj ‡f‡½ Ges ‡bŠKv eÜ Kivi
Rb¨ c«‡qvRbxq mvnmx c`‡¶c
‡b‡e Ges ‡jevi, hviv Avgv‡`i big ¯ú‡k© cwiYZ Ki‡e| we‡k¦i A‰ea Awfevmb ivRavbx Ges Avgv‡`i ‡¯‹vqvi Iqv‡b wdwi‡q wb‡q hvb|
c‡ii mßv‡ni wbe©vPbwU µwms‡q c«Z¨vwkZ M«x‡®§i e…w×i Av‡M Av‡m, RyjvB, AvM÷ Ges ‡m‡Þ¤^i mvaviYZ m‡e©v”P gvm|
wgt mybvK 24 RyjvB iæqvÛvq c«_g
d¬vB‡Ui Rb¨ ‡cbwmj K‡iwQ‡jb
wKš‘ ‡jevi wbe©vP‡b 20 c‡q›U
GwM‡q Ges Gi weiæ‡× 12 wUiI
‡ewk AvBwb c`‡¶c ‡bIqvi mv‡_ mv‡_ GwU ‡bIqvi m¤¢vebv ¶xY ‡`Lv‡”Q|
DËi d«v‡Ý, AvBGmAvBGm Øviv
e›`x Biv‡Ki GKRb 43 eQi eqmx
‡ckgvM©v ‡hv×v `¨ ‡UwjM«vd‡K
e‡j‡Qb ‡h wZwb we«‡U‡b hvIqvi
Rb¨ wbe©vP‡bi ci ch©š— A‡c¶v
Ki‡Qb| wZwb e‡jwQ‡jb ‡h mš¿vmx
‡Mvôxi Øviv ‡M«ßvi I e›`x nIqvi
c‡i wZwb wZb gvm 17 w`b e›`x
Ae¯’vq KvwU‡q‡Qb|
Ò`yB mßvn A‡c¶v Kiv fvj, Avwg
`yB mßvn A‡c¶v Ki‡Z PvB,Ó wZwb ‡hvM K‡i‡Qb| ÒbZyb miKvi
bv Avmv ch©š— Avgv‡`i A‡c¶v
Ki‡Z n‡e| GwU [iæqvÛv] GKwU mwZ¨B Lvivc wm×všÍ, GwU AviI
ivRbxwZ Ges e¨emv| DØv¯—y‡`i
c«wZ GKUy KiæYv K‡iv|Ó
Av‡iKwU, GKwU 17 eQi eqmx
wmwiqvb ‡Q‡j ‡h GKwU e¨_© ‡bŠKv
j‡Â Zvi nvZ AvnZ n‡qwQj e‡j e¨vL¨v K‡i‡Q ‡h ‡m cQ›` Ki‡Z cvi‡j ‡`wi Ki‡e|
ÒAvgv‡`i hvIqvi wm×vš— ‡bB,
Avgiv ‡PvivKvievix‡`i AbymiY
Kwi, GUv Zv‡`i e¨vcvi| Z‡e Abyf~wZ wnmv‡e, n¨vu bZyb miKvi _ vK‡j `yB mßvn _vKv fvj, hv AviI wbivc`,Ó wZwb e‡jwQ‡jb|
Òhw` wm×vš—wU Avgvi mv‡_ _vKZ
Avwg [iæqvÛv ev` bv nIqv ch©šÍ] hve bv| ‡PvivKvievwiiv Avgv‡`i‡K gvbyl wn‡m‡e bq, A_©, e¨emv wn‡m‡e ‡`‡L|
ÒZviv Avgv‡`i GLb, Av‡M ev c‡i cvVv‡j wKQy hvq Av‡m bv| Zv‡`i ïay A‡_i« c«‡qvRb, Zviv ‡mw`‡K ‡Lqvj iv‡L bv| Z‡e G‡Kev‡i, Zviv cwiw¯’wZ Rv‡b Ges GwU Zv‡`i Rb¨ AviI fvj n‡Z cv‡i|Ó
µwms‡qi A_© msM«‡ni Rb¨ GKwU kwcs U«wjs ‡_‡K wmMv‡iU, cvbxqGes we¯‹yU wewµ Kiv GKRb eq¯‹ BivwK gwnjv e‡j‡Qb, wZwb cvi nIqvi Rb¨ ÒLye `xN© mgqÓ
A‡c¶v Ki‡Qb|
Ò‡hw`b Zviv iæqvÛv‡K aŸsm Kivi mwVK wm×všÍ bv ‡b‡e Avwg ZZ¶Y hve bv| Avwg bZyb miKv‡ii
A‡c¶vq AvwQ| hw` cwiw¯’wZ cwieZ©b nq, Avwg hve, ÒwZwb e‡jwQ‡jb|
Bs‡iwR Aa¨qbiZ my`v‡bi 24 eQi eqmx GKRb QvÎ e‡j‡Qb ‡h hw`I wZwb ‡f‡ewQ‡jb ‡h iæqvÛv c«KíwU
A‡bK Awfevmx‡K cvivcv‡ii wel‡q AviI kw¼Z K‡i Zy‡j‡Q, Z‡e my‡hvM ‡c‡j wZwb GKwU ‡bŠKv wb‡q hv‡eb KviY wZwb A‡±vei ‡_‡K A‡c¶v Ki‡Qb|
ÒGB iæqvÛvi cwiKíbv memgqAvgv‡K Pvc w`‡q‡Q| Avgiv c«v_©bv KiwQ iæqvÛvi GB cwiKíbv ‡hb ‡kl nq| hw` bZyb
c«avbgš¿x G‡m cwiKíbv eÜ K‡i ‡`b, Zvn‡j ‡mUvB n‡e,Ó e‡jb wZwb|
ÒhLb Avwg ïbjvg ‡h GB ‡jvKwU [wgt mybvK] c‡o hv‡”Q, Ges GB wbe©vP‡b wRZ‡e bv, ZLb Avwg g‡b Kwi, Avcwb Rv‡bb, GwU Avðh©RbK n‡Z P‡j‡Q, GwU Awek¦vm¨ n‡Z P‡j‡Q| iæqvÛv m¤ú‡K© Avgv‡`i f‡qi Kvi‡Y Avgiv ‡ewkifvMB GLbI GLv‡b AvwQ| Avgiv bZyb miKv‡ii Rb¨ c«v_©bv KiwQ|Ó
22 eQi eqmx GKRb Bivwb gwnjv kiYv_©x‡`i c«wZ b…ksmZvi Awf‡hvM K‡i‡Qb| ÒAvwg Biv‡b Qq eQi cov‡kvbv K‡iwQ, Avwg ‡mLv‡b [hy³iv‡R¨] fv‡jv wKQy Ki‡Z cvwi| Zviv Avgv‡`i‡K Acivax Ges gv`K e¨emvqx Ges cvPviKvix GKB ‡k«Yx‡Z iv‡L| Fwl mybvK, Avgiv Zv‡K cQ›` Kwi bv, ÒwZwb e‡jwQ‡jb| ‡KD ‡KD wek¦vm K‡iwQ‡jb ‡h Zv‡`i we«‡U‡b _vKvi m¤¢vebv GKwU Avk«q `vwei kw³i Dci wbfi« K‡i, iæqvÛv d¬vBU Pvjy ‡nvK ev bv ‡nvK|
ÒAvcwb hw` KvD‡K wRÁvmv K‡ib, ‡KD iæqvÛv m¤ú‡K© wPš—v K‡i bv| Avcwb hLb ‡mLv‡b [we«‡U‡b] hvb, ZLb mewKQyB Avcbvi gvgjvi Dci wbfi« K‡i,Ó e‡j‡Qb GKRb Bw_Iwcqvb e¨w³| Ò‡mLv‡b hvIqvi KviY wbfi« K‡i Avcwb Avcbvi ‡`k ‡_‡K cvwj‡q hvIqvi Kvi‡Yi Dci| miKvi hw` Avcbvi gvgjv M«nY bv K‡i Z‡e Avcwb wKQyB Ki‡Z cvi‡eb bv| mvivn ‡ewi, iæUm-Gi ‡Kvlva¨¶, DËi d«v‡Ý Avk«qc«v_©x‡`i mnvqZv c«`vbKvix GKwU `vZe¨ ms¯’v, e‡j‡Qb ‡h wZwb ÒGK gyû‡Zi« Rb¨Ó wek¦vm K‡ib bv ‡h miKvi cwieZ©b kiYv_©x‡`i c«fvweZ Ki‡e|
ÒiæqvÛv mdj nqwb, Aš—Zc‡¶ GwU N‡Uwb e‡jB bq Z‡e GwU Kvgbv Kivi Rb¨ AveviI wgwjqb wgwjqb LiP n‡q‡Q,Ó wZwb e‡jwQ‡jb| Òc«gvY GB ‡h gvbyl GLbI ‡Póv Ki‡Q, Ges ‡KD gviv hv‡”Q, hy³iv‡R¨ ‡cŠuQv‡bvi Rb¨|Ó
Z‡e D‡ØM i‡q‡Q ‡h d«v‡Ý GKwU KÆi-Wvb miKv‡ii wbe©vPb K‡Vvi Awfevmb bxwZi m~Pbv Ki‡Z cv‡i hv AviI µwms‡K DZ&mvwnZ Ki‡Z cv‡i|
‡W¯‹ wi‡cvU©t Fwl mybv‡Ki ‡KvwfW ÷vU©-Avc Znwej Ki`vZv‡`i FY cybiæ×v‡ii c«qv‡m K‡qK WRb ‡Kv¤úvwb‡K wjKyB‡Wk‡b ‡V‡j w`‡q‡Q|
fwel¨Z Znwej Av`vj‡Zi ‡iKW© Abymv‡i gnvgvix PjvKvjxb 32wU ‡Kv¤úvwbi Kv‡Q wcwUkb eÜ K‡i w`‡q‡Q|
A‡bK ‡¶‡ÎB Gi d‡j Av`vj‡Zi gva¨‡g e¨emv eÜ Kivi wb‡`©k ‡`Iqv n‡q‡Q Ges ‡Kv¤úvwb Zvi wewb‡qvM cybiæ×vi bv K‡i Znwej eÜ K‡i w`‡q‡Q|
fwel¨Z Znwej 2020 mv‡j wgt mybvK Øviv P¨vw¤úqb n‡qwQj hLb wZwb gnvgvix PjvKvjxb ‡jvKmvbKvix ÷vU©-Avc¸wj‡K mg_©b Kivi Dcvq wnmv‡e P¨v‡Ýji wQ‡jb, Z‡e GwU jvf Ki‡e wKbv Zv wb‡q c«‡kœi gy‡LvgywL n‡qwQj|
GwU wZb eQ‡ii k‡Z© 1191 ‡Kv¤úvwb‡K 1.1 wewjqb cvDÛ avi w`‡q‡Q, hLb e¨emv¸wj ÒAbymiYÓ wewb‡qvM evovq ZLb FY¸wj ‡kqv‡i iƒcvš—wiZ nq| hw` ‡Kv¤úvwb¸wj AviI wewb‡qvM bv

evovq Z‡e Zv‡`i F‡Yi wظY Ges my‡`i mv‡_ ‡diZ w`‡Z n‡e|
FY GLb cwic° nIqvi mv‡_ mv‡_, ZnwejwU 5 wgwjqb cvDÛ ch©š— wewb‡qvM cybiæ×vi Kivi Rb¨ wKQy ‡Kv¤úvwb‡K Av`vj‡Z wb‡q ‡M‡Q, wcwUkb Bm¨y K‡i GKwU ‡Kv¤úvwb‡K eva¨Zvg~jK wjKyB‡Wk‡b eva¨ Kivi c«‡Póv|
2022 mv‡ji ‡kl ‡_‡K 32wU gvgjvi g‡a¨, 23wU Ki`vZv-mgw_©Z ms¯’v¸wj‡K c«kvm‡b ivLv n‡q‡Q ev Aemvb Kiv n‡q‡Q
Zv‡`i g‡a¨ GAvBmj&f, GKwU fvPqvj wi‡qwjwU ‡Kv¤úvwb hvi cvIbv wQj 11.4 wgwjqb cvDÛ; wewb‡qvM A¨vc Wvej; Ges ‡Kv¤úvwb¸wj ‡bvfv Mªyc Øviv mgw_©Z, c«v³b ‡Um‡Kv em m¨vi ‡Uwi ‡jwn
Øviv mgw_©Z GKwU ÷vU©-Avc wewb‡qvM e¨emv ZnwejwU cwiPvjbvKvix we«wUk weR‡bm e¨vs‡Ki GKRb gyLcvÎ e‡j‡Qb, ÒKi`vZv‡`i ¯^v_© i¶v Kiv Zv‡`i KZ©e¨Ó| e¨v¼ e‡j‡Q ‡h GwU ‡ewkifvM ‡Kv¤úvwb‡K G·‡Ubkb gÄyi K‡i‡Q hviv Zv‡`i Aby‡iva K‡iwQj FY cwi‡kv‡ai `vwe bv K‡i|
Zv‡`i ‡gqv`c~wZi« Zvwi‡L FY e‡Kqv _vKv ‡Kv¤úvwb¸wji g‡a¨ c«wZwU ‡Kv¤úvwbB ‡gqv` evov‡bvi Rb¨ Av‡e`b K‡iwb,Ó GKRb wewewe gyLcvÎ e‡j‡Qb| Òhviv F‡Yi ‡gqv` e…w×i Rb¨ Av‡e`b K‡i‡Q, Zv‡`i me Av‡e`bB mdj nqwb|
ÒAvgv‡`i KZ©e¨ Ki`vZv‡`i ¯^v_© i¶v Kiv| hLb ‡Kv¤úvwb¸wj ‡gqv`c~wZi« Zvwi‡L ‡cŠu‡Q hvq Ges Zv‡`i FY¸wj e‡Kqv _v‡K, ZLb Avgiv Znwej
e‡jwQj ‡h Znwej b¨vh¨ g~‡j¨i wfwˇZ 289 wgwjqb cvDÛ nvwi‡q‡Q|
we`¨yr wew”Q‡bœi Kvi‡Y g¨vb‡P÷vi wegvbe›`‡ii mg¯Í d¬vBU evwZj
‡W¯‹ wi‡cvU©t g¨vb‡P÷vi wegvbe›`i Uvwg©bvj ‡_‡K mg¯— d¬vBU Ó we`¨yr KvUÓ Gi c‡i evwZj Kiv n‡q‡Q hv wekvj mvwi Ges jv‡MR c«wµqvKi‡Y e¨vNvZ NUvq|
iweevi we‡K‡j GKwU ‡mvk¨vj wgwWqv ‡cv‡÷, GgGwR Mªyc e‡j‡Q ‡h AvD‡U‡Ri c‡i ÒcieZ©x weÁwß bv nIqv ch©š—Ó Uvwg©bvj GK Ges `yB ‡_‡K ‡KvbI d¬vBU Qvo‡e bv, hv mKv‡ji c«_g w`‡K wm‡÷‡g AvNvZ K‡i| wegvbe›`‡ii GKRb gyLcvÎ e‡j‡Qb, Uvwg©bvj 3 Gi gva¨‡g DošÍ hvÎx‡`i ¯^vfvweKfv‡e wegvbe›`‡i Avm‡e, Z‡e wej‡¤^i gy‡LvgywL n‡Z cv‡i| GKRb gyLcvÎ e‡j‡Qb, Ò‡h e¨vKj‡Mi gva¨‡g KvR KiviÓ c«‡Póv Ae¨vnZ _vKvq wegvbe›`‡i BwZg‡a¨B Zv‡`i d¬vBU¸wj‡K AM«vwaKvi ‡`Iqv n‡e| wegvbe›`‡ii c«¯’vb ‡evW© evwZj wnmv‡e ‡`Lv‡bv hvÎvi msL¨v, ewnivMZ Aš—Z ga¨ we‡Kj ch©š— evo‡e e‡j Avkv Kiv n‡”Q|

wegvbe›`iwU wewewm‡K e‡j‡Q ‡h mxwgZ ¯’v‡bi Kvi‡Y Òwegvb¸wj DV‡Z cv‡i bvÓ KviY Aš— g©yLx d¬vBU¸wj‡K mwi‡q ‡`Iqv n‡qwQj| GwU wegvb‡K M«nY Kiv KwVb
K‡i Zy‡j‡Q, hv Ab¨Î cvVv‡bv n‡e, gyLcvÎ ‡hvM K‡i‡Qb| Gqvi‡cv‡Ui« e¨vKAvc cvIqvi wm‡÷g Pvjy nq hLb ‡gBb wm‡÷g WvDb n‡q hvq, wKš‘ ‡gBb‡mi we`¨yr GKvwaKevi
‡K‡U hvIqvi Kvi‡Y cwiw¯’wZ RwUj nq| GqvijvBbm e‡j‡Q ‡h jv‡MR c«wµqvKi‡Yi mgm¨v gv‡b M«vnKiv ‡Kej GKwU ‡Kweb e¨vM wb‡q Po‡Z cv‡i|
GKwU wee…wZ‡Z, ‡RU 2 e‡j‡Q ‡h n¨vÛjviiv weåv‡Ui Kvi‡Y ‡c‡b e¨vM ‡jvW Ki‡Z cv‡iwb| Gw`‡K BwR‡R‡Ui GKRb gyLcvÎ e‡j‡Qb ‡h e¨v‡MR wm‡÷‡g mgm¨vi Kvi‡Y hvÎxiv
‡Kej GKwU ‡Kweb e¨vM wb‡q Zv‡`i d¬vB‡U DV‡Z cv‡i| g¨vb‡P÷vi evwZj hy³iv‡R¨i Z…Zxq e¨¯—Zg wegvbe›`‡i M«x‡®§i QywUi gimy‡gi ïiæ‡Z GB e¨vNvZ N‡U, hv hvÎx‡`i Kv‡Q ¶gv ‡P‡q‡Q| wegvbe›`‡ii GKwU m~Î Rvbvq, we`¨yr wew”Qbœ n‡q hvIqvq ÒAv¶wiK A‡_©B mewKQy eÜ n‡q ‡M‡QÓ| GwU Av‡kcv‡ki GjvKvi Ab¨vb¨ e¨emv¸wj‡KI c«fvweZ K‡i‡Q, hvi g‡a¨ Av‡kcv‡ki c«avb jwRw÷K ms¯’v¸wj i‡q‡Q BD‡iv 2024 G Bsj¨vÛ ‡`Lvi Rb¨ ågY Kiv ewe n¨vWMª¨vd&U wewewm ‡iwWI g¨vb‡P÷vi‡K e‡j‡Qb ‡h wZwb Uvwg©bvj 1 Gi evB‡i Òwekvj mvwiÓ ‡`L‡Z weGmwU c«vq 4Uvq G wegvbe›`‡i ‡cŠu‡QwQ‡jb| ÒAvgiv DwØMœ wQjvg ‡h Avgiv Avgv‡`i d¬vBU wgm Kie,Ó wZwb e‡jb, we`¨yr weåvU wWm‡c ‡evW© Ges ¯‹¨vbvi¸wj‡K c«fvweZ K‡iwQj ZvB Kg©x‡`i mvB‡Ui Pvicv‡k hvÎx‡`i wb‡`©k w`‡Z n‡qwQj

‡W¯‹ wi‡cvU©t ‡h‡nZy hy³ivR¨
µgea©gvb ZvcgvÎvi gy‡LvgywL
n‡”Q, ZvB Avgiv Avgv‡`i
Ni¸wj‡K VvÛv ivL‡Z Kx Ki‡Z cvwi?
GwU Kiv ¸iæZ¡c~Y© hLb evB‡ii evZv‡mi ZvcgvÎv wfZ‡ii
Zyjbvq VvÛv _v‡K, GwU ivZvivwZ ev ‡fvi‡ejv K‡qK
N›Uvi Rb¨ _v‡K|
d¬¨vU¸wj‡Z, ‡h¸wji ïaygvÎ
GKcv‡k Rvbvjv _vK‡Z cv‡i, `iRv Lyjyb Ges evqyc«evn‡K DZ&mvwnZ Kivi Rb¨ GKwU d¨vb e¨envi Kiæb
Kwi‡Wv‡ii w`‡K hvIqvi Rb¨ ‡Lvjv `iRv¸wj‡K mvnvh¨ Ki‡eb bv, KviY ‡m¸wj GKwU
AwMœ wbivcËv e¨e¯’v|
Avcbvi evwoi wfZi ‡_‡K Mig evZvm DVvi mv‡_ mv‡_ GwU
c«vqkB AvU‡K ‡h‡Z cv‡i, Ges
Avcbvi hw` gvPv ev Rvbvjv _v‡K Z‡e Zvc wKQy ‡Q‡o

‡`Iqvi Rb¨ ‡m¸wj ‡Lvjv GKwU fvj aviYv| hw` Avcwb bv K‡ib, Zvn‡j
Mig evZvm wØZxq ZjvqAvU‡K ‡h‡Z cv‡i, ‡hLv‡b Avcwb Nygv‡bvi ‡Póv Ki‡Qb| jd&U
n¨vPwU ‡Lvjvi d‡j ‡eWiæg ‡_‡K evZvm AviI evo‡Z cv‡i|

ÒAvcwb wewb‡qvM Ki‡Z m¶g n‡j, Avcbvi evwo‡Z AwZwi³ wb‡ivaK Bb÷j Kiv M«x‡®§ Zvc‡K `~‡i ivL‡Z mvnvh¨ Ki‡e ‡mBmv‡_ kxZKv‡j Avcbvi GbvwRi« wej Ges e¨envi Kgv‡Z mvnvh¨ Ki‡e,Ó ‡Rvqvbv IÕ‡jvb e‡j‡Qb, GbvwR© ‡mwfs U«v÷ ‡_‡K w`‡bi Mi‡g Avcbvi Rvbvjv eÜ ivLv Ges LoLwo/c`©v eÜ ivLv fv‡jv we‡kl K‡i Avcbvi evwoi cv‡k ‡hLv‡b m~h© R¡j‡Q| f~ga¨mvM‡i Ni¸wj mvaviYZ Zvc ‡_‡K i¶v Kivi Rb¨ ‰Zwi Kiv nq| gvwUi Qv‡`i UvBjm ‡_‡K ïiæ K‡i mv`v ‡`qvj ch©š—| ‡QvU Rvbvjv ‡`LvI A¯^vfvweK bq KviY ‡jv‡Kiv hZUv m¤¢e mivmwi m~h©v‡jvK `~‡i ivLvi ‡Póv K‡i, we‡kl K‡i evwoi c~e© Ges cwðg w`‡K| Graphic showing windows and loft hatch open at night
evZvm evov‡bvi Rb¨ GKwU d¨vb e¨envi Kiæbt wg‡mm IÕ‡jvb e‡j‡Qb, d¨vb¸wj ÒevZvm PjvP‡ji Rb¨ GKwU A‡c¶vK…Z m¯—v Ges GbvwR© mvk«qx DcvqÓ Ges Avcbv‡K kxZj _vK‡Z mvnvh¨ Ki‡Z cv‡i| GbvwR© ‡mwfs U«v÷ Abymv‡i, GKwU wd«÷¨vwÛs d¨vb e¨envi
Kivi Rb¨ 24N›Uv a‡i GKUvbv e¨env‡ii Rb¨ c«vq 20 ‡cÝ40 ‡cÝ LiP nq|
GKwU ‡Lvjv Rvbvjvi mvg‡b d¨vb ivL‡j evB‡i ‡_‡K ZvRv evZvm‡K mviv N‡i c«evwnZ n‡Z DZ&mvwnZ Ki‡Z cv‡i hw` GwU evB‡i kxZj nq| Avcbvi w`‡K c«evwnZ evZvm‡K VvÛv Ki‡Z Avcwb d¨v‡bi mvg‡b ei‡di UyK‡ivI ivL‡Z cv‡ib| Ges Avcwb GKwU µm Kv‡i›U ‰Zwi Ki‡Z GKvwaK d¨vb e¨envi Ki‡Z cv‡ib| gvbe‡`‡ni we‡klÁ Aa¨vcK gvBK wUcUb e‡jb, kixi‡K VvÛv ivLvi m‡e©vËg Dcvq Lyu‡R
‡ei Kivi Rb¨ Kxfv‡e KvR K‡i Zv ‡evSv ¸iæZ¡c~Y©| Ògy‡L d¨vb jvMv‡bv Zvcxq Aviv‡gi DbœwZ K‡i, wKš‘ cy‡iv kix‡i d¨vb jvMv‡bv kix‡ii ZvcgvÎv AviI Kgv‡Z mvnvh¨ K‡i,Ó wZwb e‡j‡Qb| wKš‘ wZwb mZK© K‡ib hLb ZvcgvÎv 35 wWM«x ‡mjwmqvm Gi Dc‡i _v‡K ZLb d¨vb e¨envi Ki‡j Avm‡j kix‡i Zvc e…w× ‡c‡Z cv‡i
e¨env‡ii mgq Ges c‡i evwo‡Z c«Pyi Zvc wbM©Z K‡i| m¨vÛDBP Ges mvjv‡`i g‡Zv VvÛv Lvev‡i ‡j‡M _vKv, we‡kl K‡i w`‡bi me‡P‡q Mig mg‡q, Ac«‡qvRbxq Zvc ‰Zwi nIqv eÜ Ki‡Z cv‡i Ges kw³i we‡ji A_© mvk«q Ki‡Z cv‡i| Ab¨vb¨ hš¿cvwZ, ‡hgb Iqvwks ‡gwkb Ges wWkIqvkvi¸wjI Zvc Drcbœ Ki‡Z cv‡i ZvB hLb GwU me‡P‡q Mig nqZLb ‡m¸wj e¨envi bv Kivi ‡Póv Kiæb| ïaygvÎ ‡`qv‡j cvM Kiv hš¿cvwZ _vK‡j Zvc wbM©Z n‡Z cv‡i ZvB wbwðZ Kiæb ‡h AvB‡Ug¸wj e¨envi bv n‡j m‡K‡U eÜ Av‡Q|
D”P Av`«©Zv evZv‡m Av`«©Zv Zvc K¬vwš—I Avbv ‡h‡Z cv‡i ZvB evwo‡Z Av`«©Zv Kgv‡Z: ‡QvU Ges VvÛv Sibv wbb c…ô ‡_‡K AwZwi³ Rj gyQv wfZ‡ii MvQcvjv evB‡i mivb Tips for staying cool and safe wb‡R‡K VvÛv Kiæb nvjKv Sibv Avcbvi kix‡ii ZvcgvÎv VvÛv Ki‡Z mvnvh¨ Ki‡Z cv‡i, A_© Ges GbvwR© DfqB mvk«q K‡i| Z‡e c«‡dmi wUcUb Lye ‡ewk VvÛv bv nIqvi Rb¨ mZK© K‡i‡Qb: Ò‡KŠkjwU nj Z¡K‡K hZUv m¤¢e VvÛv Kivi ‡Póv Kiv Ges GwU‡Z me©vwaK i³ c«evn eRvq ivLv| ÒAZ¨waK VvÛv Ges kixi Z¡‡K i³ eÜ Ki‡e Ges kix‡i Zvc AvU‡K ivL‡e hv ‡ei nIqv KwVb K‡i Zyj‡e|Ó Avcbvi kix‡i ei‡di c¨vK ev VvÛv R‡ji ‡evZj ivL‡j ZvZ&¶wYK ¯^w¯—i Abyf~wZ cvIqv hvq|
Avevmb msKU Kgv‡Z Ges AvwZ‡_qZv LvZ‡K cybiæ¾xweZ Ki‡Z jÛb cwiKíbv ‰Zwi Ki‡Qb mybvK
‡W¯‹ wi‡cvU©t Fwl mybvK e‡jwQ‡jb ‡h wZwb Avevmb m¼U Kgv‡Z, Amy¯’ AvwZ‡_qZv LvZ‡K cybiæ¾xweZ
Ki‡Z Ges AviI ‡ewk ‡emvgwiK
Kg©Pvix‡K ‡nvqvBUn‡j wdwih‡q Avbvi Rb¨ Zvi jÛb cwiKíbv ‰Zwi K‡iwQ‡jb|
Nwoi KvuUv 4 RyjvB‡qi ‡fv‡Ui w`‡bi w`‡K GwM‡q hvIqvi mv‡_ mv‡_, c«avbgš¿x ‡Kb jÛbevmx‡`i ‡jevi‡K mg_©b Kivi cwie‡Z© KbRvi‡fwUf‡K ‡fvU ‡`Iqv DwPZ, ms¯‹v‡i m¨yBP Kiv DwPZ ev wjev‡ij ‡W‡gvKª¨vU ev wM«bm‡K mg_©b Kiv DwPZ ‡m wel‡q Zvi ÷j ¯’vcb K‡i‡Qb|
`¨ ÷¨vÛv‡Wi« mv‡_ GKwU mv¶vZ&Kv‡i, c«avbgš¿x e‡j‡Qb:
* MZ mßv‡n e¨vsK Ad Bsj¨v‡Ûi `yB kZvsk j¶¨gvÎv‡K g~j¨ùxwZ AvNvZ Kivi c‡i gi‡MR nvi kxN«B Kg‡Z ïiæ Ki‡e e‡j Avkv c«Kvk K‡i‡Q, hv A‡bK cwiev‡ii Dci Avw_©K Pvc Kwg‡q ‡`‡e|
* we‡kl K‡i jÛ‡b ‡i‡¯—vivu, evi, cve Ges w_‡qUvi¸wj‡K k¦vm‡iva K‡i Ò‡evSv, wewaweavb Ges jvj wdZviÓ KyVvi wb‡q hvIqvi c«wZk«ywZ w`‡q‡Qb, KviY Zviv GLbI Kvgov‡bvi LiPAd-jvBf m¼‡Ui mv‡_ ‡eu‡P _vKvi ‡Póv Ki‡Q
* ‡Rvi w`‡qwQ‡jb ‡h ‡emvgwiK Kg©Pvix‡`i we«‡U‡bi Ò‡WwjfviÓ Kivi Rb¨ ‡nvqvBUn‡j wd‡i Avm‡Z n‡e, we‡klZ Aí eq¯‹ Kg©x‡`i Rb¨ myweav¸wjI Zy‡j a‡ib|
* miKvi Ges mvw`K Lv‡bi g‡a¨ Avevmb Ges Aciva wb‡q msNv‡Zi ¯’weiZv Kgv‡bvi ‡Póv Kivi ‡KvbI j¶Y ‡`Lvqwb|
* wbe©vP‡bi Zvwi‡Li evwR
‡K‡j¼vwi‡Z Zvi jvB‡b AvU‡K ‡Uvwi‡`i Av”Qbœ K‡i, e‡j‡Qb ‡h `jwUi ‡h ‡KD A‰ea evwR a‡ib Zv‡K ÒeyU AvDUÓ Kiv n‡e Ges ÒAvB‡bi c~Y© cwiYwZiÓ gy‡LvgywL n‡Z n‡e|
* jÛ‡bi cwie‡Z© wbDBq‡K© e¨emvi ZvwjKv Kiv wb‡q D‡Ø‡Mi g‡a¨, wZwb ‡Rvi w`‡qwQ‡jb ‡h kniwU‡K GKwU
ÒDb¥y³, c«hyw³MZfv‡e DbœZ Avw_©K cwi‡lev LvZ n‡Z n‡e hv wek¦e¨vcx c«wZ‡hvwMZvg~jKÓ|
* e‡jwQ‡jb ‡h Zvi Òwek¦vmÓ wQj ‡h n¨vwi ‡K‡bi `j BD‡iv 2024G Zv‡`i wech©¯Í ïiæi c‡i mewKQy Nywi‡q w`‡Z cv‡i|
wgt mybvK jÛ‡bi Rb¨ Zvi `…wófw½i
iƒc‡iLv w`‡q‡Qb KviY ‡Uvwiiv ivRavbx‡Z c«vq 20wU Avmb i¶vi Rb¨ jovB Ki‡Q, Rwic¸wj civgk©

w`‡q‡Q ‡h Zviv PviwUi g‡Zv Avmb ‡c‡Z cv‡i|
÷¨vÛvW© kni Ry‡o mg¯— wbe©vPbx
GjvKvi GKwU B›Uv‡iw±f gvbwPÎ
msKjb K‡i‡Q, ‡c«vdvBj¸wj Zv‡`i
c«v_©x‡`i ZvwjKv, mxgvbv cwieZ©b
Ges ‡K wRZ‡Z cv‡i Zvi `…wófw½
mn|
‡KvwfW gnvgvixi c‡i jÛb GLbI mg¯— wmwjÛv‡i ¸wj Pvjv‡Z wd‡i
Av‡mwb, A‡bK Kg©x mßv‡n gvÎ K‡qK w`‡bi Rb¨ Awd‡m Av‡mb|
gš¿xiv wek¦vm K‡ib ‡h A‡bK ‡emvgwiK Kg©Pvix GLbI ‡nvqvBUn‡j ch©vß mgq KvUv‡”Qb bv|
Ògvbyl‡K mvgbvmvgwb ‡`‡L Avcwb ‡h myweav¸wj cvb, Avcwb ‡h ‡g›Uwis cvb, Avcwb ‡h ms‡hvM¸wj ‰Zwi K‡ib, Avcwb Ryg ev `j¸wji Dci c«wZwjwc Ki‡Z cvi‡eb bv,Ó wgt mybvK e‡jwQ‡jb|
ÒmyZivs c«_gZ Ges me©v‡M« GwU we‡klZ Zi“Y‡`i Rb¨ Awd‡m _vKv fvj Ges AviI we¯—…Zfv‡e Avgiv Ggb GKwU ‡c«vM«vg ‡c‡qwQ hv wbwðZ K‡i ‡h ‡jv‡Kiv Awd‡m wd‡i
G‡m‡Q|
ÒGwU ¸iæZ¡c~Y© hv‡Z ‡jv‡Kiv ‡`‡ki Rb¨ mieivn Ki‡Z cv‡i|Ó cve, evi, w_‡qUvi Ges ‡i‡¯— vivu¸wjI ÒjÛ‡bi A_©bxwZ Pvjbvi Rb¨ Acwinvh©,Ó c«avbgš¿x ‡Rvi w`‡qwQ‡jb|
Z‡e A‡b‡KB Kg©x‡`i NvUwZ, gnvgvix
PjvKvjxb ‰Zwi Kiv FY Ges Kg
M«vn‡Ki mv‡_ jovB Ki‡Qb|
Òmgm¨v Ab¨ me RvqMvi ‡P‡q jÛ‡b
AviI Lvivc,Ó c«avbgš¿x e‡jwQ‡jb|
Ò‡fb¨y¸wj ‡`‡ki evwK As‡ki Zyjbvq `ªyZ nv‡i eÜ n‡”Q|Ó myZivs, ‡Uvwim jvB‡mwÝs AvBb, cwiKíbvi wbqg Ges Ab¨vb¨ Òjvj
‡UcÓ Gi GKwU eo ch©v‡jvPbvi c«wZk«ywZ w`‡”Q hv Zviv e‡j ‡h
Ac«‡qvRbxqfv‡e iv‡Zi A_©bxwZ‡K
AvU‡K ivL‡Q|
Z‡e A‡bK AvwZ‡_qZv ‡m±‡ii c«avbiv ej‡Qb ‡h ‡e«w·U-BD‡ivcxq BDwbq‡bi bvMwiK we«‡U‡b KvR Ki‡Z
Avmv msL¨v K‡g hvIqvi c‡i Zviv ch©vß Kg©x Lyu‡R cv‡”Qb bv|
wgt mybvK GB PvKwi¸wj c~iY Kivi
Rb¨ we«wUk Kg©x‡`i c«wk¶Y ‡`Iqvi bxwZ‡Z AvU‡KwQ‡jb, hw`I GwU ¯úóZB h‡_ó `ªyZ NU‡Q bv|
ÒAvwg g‡b Kwi we«wUk RbM‡Yi KvR Kivi Ges wb‡R‡`i Rb¨ GKwU D¾¡j fwel¨Z M‡o ‡Zvjvi my‡hvM _vKv DwPZ Ges Avgiv AvwZ‡_qZv ‡m±‡i k~b¨c`¸wj c~iY Kivi Rb¨ wWRvBb Kiv GKwU we‡kl Kg©ms¯’vb Kg©m~wPi cvBjU KiwQ,Ó wZwb e‡jwQ‡jb|
ÒAvgv‡`i ‡`‡k Awfevm‡bi mvgwM«K gvÎv Lye ‡ewk Ges Avgv‡`i Zv‡`i bvwg‡q Avb‡Z n‡e, hv miKvix cwi‡levi Dci Pvc m…wó Ki‡Q,Ó wZwb ‡hvM K‡i‡Qb|
wKQy ‡Uvwi‡`i D‡Ø‡Mi g‡a¨, ‡h `‡ji
wbe©vPbx c«PviYv Z_vKw_Z Òjvj
c«vPxiÓ Ges jÛ‡bi KwgDUvi ‡eë
mn Òe IqvjÓ-G h‡_ó bq, c«avbgš¿x
e‡j‡Qb: ÒmevB, me©Î Ggb GKwU
miKvi Pvq hv A_©bxwZi e…w×, Zv‡`i
Ki Kgv‡bv Ges wb‡R‡`i Ges Zv‡`i cwiev‡ii Rb¨ AviI wbivc` fwel¨Z
M‡o ‡Zvjvi GKwU my¯úó cwiKíbv
‡c‡q‡Qb|
Ò‡jev‡ii 2000 cvDÛ g~‡j¨i U¨v·
wej w`‡q ‡jv‡K‡`i Rwg ‡`Iqvi cwiKíbv, Ges ‡Kvb U¨v· (Zviv hv‡”Q) evov‡bvi wel‡q mr bv nIqvUv wVK bq|
ÒAvgv‡`i GKwU cwiKíbv Av‡Q, GwU KvR Ki‡Q, ‡jv‡Kiv A_©‰bwZK w¯’wZkxjZvi wel‡q wPš—v Ki‡Q, gy`«vùxwZ j‡¶¨ wd‡i G‡m‡Q, A_©bxwZ evo‡Q, my‡`i nvi n«vm ‡hgb
Avgiv ‡`L‡Z cvw”Q GLb Zv‡`i c‡_ i‡q‡Q, eÜKx nvi n«vm|
Ò‡Kb Avcwb GB mg¯— AM«MwZ‡K SyuwKi g‡a¨ ivL‡eb?Ó wKš‘ ‡Uvwi‡`i `vwe ‡h GKwU k«g miKvi 2000 cvDÛ U¨v· wej w`‡q cwievi¸wj‡K AvNvZ Ki‡e Zv ‡U«Rvwi, ¯^vaxb d¨v± ‡PKvm© Ges BD‡K cwimsL¨vb bRi`vwi Øviv ¶ybœ
Kiv n‡q‡Q, cieZ©x gš¿xiv ¯úó bv Kivi Rb¨ GB cwimsL¨vbwU Pvi eQ‡ii ‡ewk| GKwU bv|
hw` Zvi `j GwU ¯úó K‡i e‡jwQj ‡h Zvi U¨v· AvµgY AviI KvU-_«y Ges Kg ‡eve¨vK ‡cZ wKbv, wgt mybvK e‡jwQ‡jb: Òbv, KviY Avwg g‡b Kwi GwUB ‡mB LiP hv ‡jv‡K‡`i Rvbv `iKvi|Ó
jÛb Ges mvD_ B‡÷ U¨v‡·i
AvNvZ BwZg‡a¨B eQ‡i 100 wewjqb cvD‡Û ‡cŠu‡Q‡Q Ges Bsj¨v‡Û ‡`Iqv DËivwaKvi U¨v‡·i A‡a©‡KiI ‡ewk GB `yB A‡ji G‡÷U ‡_‡K Av‡m|
k«g AvqKi, f¨vU Ges b¨vkbvj Bݨy‡iÝ evov‡bvi K_v A¯^xKvi K‡i‡Q Z‡e Ab¨vb¨ ï‡éi GKwU w÷«s bq|
wgt mybvK `vwe K‡i‡Qb: Òk«g Zv‡`i cwiKíbv cwi®‹vi K‡i‡Q, hw` Avcbvi mÂq _v‡K Z‡e Avcwb U¨v· e…w×i m¤§yLxb n‡”Qb|Ó
gwš¿cwil` gš¿x gvB‡Kj Mf ¯^xKvi K‡i‡Qb ‡h ‡`‡ki U¨v· wej e…w× cv‡e, AvqKi ‡_«k‡nv‡ì wngvwqZ nIqvi Kvi‡Y, ‡hB wbe©vP‡b wRZ‡e, hw`I, wZwb hyw³ ‡`b ‡h GwU k«‡gi Aax‡b AviI evo‡e| k«g Dc‡bZv A¨v‡Äjv ‡ibv‡ii Kg©‡¶‡Îi ms¯‹v‡ii wel‡q, hvi g‡a¨ wR‡iv AvIqvi Pyw³‡Z AviI wewawb‡la i‡q‡Q, c«avbgš¿x hyw³ w`‡qwQ‡jb ‡h Zviv ÒKvR e¨q Ki‡e Ges Avgv‡`i A_©‰bwZK cybiæ×v‡ii ¶wZ Ki‡eÓ| jÛ‡bi evwoi m¼‡Ui wel‡q, ‡Uvwiiv e‡j ‡h c¨vwim Ges ev‡m©‡jvbvi g‡Zv BD‡ivcxq
hw` Zviv 4 RyjvB Avevi Rqx nq, Zvn‡j jÛ‡bi ‡gq‡ii mv‡_ nvDwRs wb‡q AviI MVbg~jK m¤úK© _vK‡Z cv‡i wKbv, c«avbgš¿xi c«wZwµqv: ÒGUv ¸iæZ¡c~Y© ‡h mvw`K Lvb‡K Zvi ‡iK‡Wi« Rb¨ `vqx Kiv nq|
ÒwZwb Zvi wb‡Ri Avevmb j‡¶¨ AvNvZ Ki‡Z e¨_© n‡q‡Qb|Ó
Aciv‡ai wel‡q, wgt mybvK Rw¤^÷vB‡ji Qywi Ges Qywii Dci wb‡lavÁv mn Qywi AvBb K‡Vvi Kivi c`‡¶‡ci Dci ‡Rvi w`‡qwQ‡jb| ‡gqi‡K Ab¨ GKwU ‡mvqvBc K‡i wZwb ‡hvM K‡i‡Qb: Òmvw`K Lvb jÛbevmx‡`i e¨_© K‡i‡Qb Ges wZwbB ‡mB e¨w³ whwb Qywii Aciva e… w× ‡c‡Z w`‡q‡Qb hLb Avgiv ‡`‡ki evwK As‡k Qywii Aciva ‡gvKv‡ejvq AviI AM«MwZ KiwQ|Ó wKš‘ ‡fvUM«n‡Yi w`b gvÎ `k w`b evwK Av‡Q, Ges Rwic ‡`Lvq ‡h ‡Uvwiiv jÛ‡b gvÎ PviRb Ggwci mv‡_ ‡kl Ki‡Z cv‡i, wgt mybvK Kxfv‡e jÛbevmx‡`i Dci Rqx n‡eb?
ÒGwU ‡Kej cQ‡›`i wel‡q avivevwnKfv‡e ‡jv‡K‡`i mv‡_ K_v ej‡Q KviY GwU GKwU Lye ¯úó cQ›`,Ó wZwb e‡jb ‡nvg Uwi Ges k«‡gi wecixZ bxwZ¸wj, we‡kl K‡i… U¨v·, U¨v· Ges U¨v·| jÛbevmxiv GB Bfwbs ÷¨vÛvW© WvUv‡e‡m ivRavbx Ry‡o 75wU wbe©vPbx GjvKvi cvuPwU c«avb `‡ji c«v_©x‡`i weeiY Lyu‡R ‡c‡Z cv‡ib|
‡W¯‹ wi‡cvU©t hw` m¨vi ‡Kqvi
÷vigvi BBD ‡KvUv w¯‹‡g ‡hvM ‡`b
Zvn‡j 100,000 Awfevmx hviv
A‰eafv‡e BD‡iv‡c c«‡ek K‡i‡Q
Zv‡`i Rb¨ ‡jevi `iRv Ly‡j ‡`‡e, ¯^ivó« mwPe `vwe K‡i‡Qb|
‡Rgm wK¬fviwj e‡jwQ‡jb ‡h we«wUk RbMY hv ‡P‡qwQj Zvi ÒwecixZÓ
Ges `vwe K‡iwQj ‡h GwU Ò‡cQ‡bi
`iRv w`‡qÓ ‡e«w·U‡K wecixZ Kivi
Rb¨ m¨vi ‡Kqv‡ii cwiKíbvi
Ask|
hw`I ‡jevi GKwU we`¨gvb c«K‡íi gva¨‡g BBDi mv‡_ ‡hvM`v‡bi cwiKíbv A¯^xKvi
K‡i‡Q hvi Aax‡b ‡`k¸wj eQ‡i
120,000 Avk«qc«v_©x‡K M«nY K‡i, Z‡e e‡jwQj ‡h Zviv BD‡ivcxq BDwbqbe¨vcx wiUvb© Pyw³i Ask wnmv‡e BD‡ivc ‡_‡K Awfevmx‡`i M«nY Ki‡Z B”QyK| hvB‡nvK, wgt wK¬fviwj mZK© K‡i w`‡qwQ‡jb ‡h m¨vi ‡Kqvi ÒBBD‡Z
bZyb Qvo w`‡q AviI GwM‡q ‡h‡ZÓ ‡P‡qwQ‡jb| mvaviY wbe©vPbx c«PviYvq ‡Uvwi
Ges ‡jevi Df‡qi Rb¨ Awfevmb GKwU g~j hyׇ¶Î| MZ g½jevi
800 GiI ‡ewk Awfevmx P¨v‡bjwU
AwZµg K‡i‡Q, hv 18 gv‡mi
m‡e©v”P ‰`wbK ‡gvU|
wg÷vi wK¬fviwj e‡j‡Qb: Ò‡jevi
Bw½Z w`‡q‡Q ‡h Zviv Awfevm‡bi
Rb¨ GKwU BBD ‡KvUv w¯‹‡g ‡hvM ‡`Iqvi K_v we‡ePbv Ki‡Q| Gi
A_© m¤¢eZ hy³ivR¨ BBD ‡_‡K
AviI 100,000 A‰ea Awfevmx‡K
Avgv‡`i ‡`‡k wb‡q hv‡”Q we«wUk
RbMY hv Pvq Zvi wecixZ| gRvi e¨vcvi nj, Zviv GwU‡K mvg‡b Zy‡j

aivi Rb¨ Ges Zv‡`i Bk‡Znv‡i
GwU AvU‡K ivLvi Rb¨ h‡_ó mr wQj bv|
ÒGKmv‡_ Zv‡`i iæqvÛv c«wZ‡iva
Ges GKwU m¤¢ve¨ A‰ea Awfevmb mvaviY ¶gv evwZj Kivi cwiKíbvi mv‡_, Zviv A‰ea Awfevmx‡`i Rb¨
we‡k¦i big ¯úk© ivRavbx wnmv‡e
Avgv‡`i Ae¯’vb‡K kw³kvjx
Ki‡e|Ó Fwl mybv‡Ki cwiKíbvi Aax‡b, A‰eafv‡e hy³iv‡R¨ Avmv Awfevmx‡`i Zv‡`i Avk«‡qi `vwe c«wµqvKi‡Yi Rb¨ iæqvÛvqcvVv‡bv n‡e|
hv‡K KbRvi‡fwUfiv ÒA‰ea
Awfevmx‡`i Rb¨ mvaviY ¶gvÓ e‡j
AwfwnZ K‡i‡Q| wgt wK¬fviwj ‡hvM K‡i‡Qb:
ÒGLb ch©š— ‡Kqvi ÷vigv‡ii cwiKíbv¸wj we«wUk RbM‡Yi ‡fv‡Ui
GKwU `k©bxq wek¦vmNvZKZvi mgvb|
¯úóZB wZwb GLbI Zv‡`i
MYZvwš¿K wm×vš— ‡g‡b wb‡Z cvi‡Qb bv| wZwb GLbI BBD Gi
K¶c‡_ Zvi cwiwPZ A‡j wd‡i
Avmvi Rb¨ Avgv‡`i mg¯— bZyb cvIqv ¯^vaxbZv‡K `~‡i mwi‡q w`‡Z Pvb e‡j g‡b n‡”Q|Ó iweevi BD‡ivcxq BDwbqb ‡Q‡o hvIqvi Rb¨ ‡fv‡Ui Aóg evwl©Kx , hv ‡Uvwiiv ‡jev‡ii Dci avivevwnK
‡KvbI wiUvb© Pyw³i Ask wnmv‡e BBD ‡_‡K Avk«qc«v_©x‡`i ‡b‡e, Z‡e AvbyôvwbKfv‡e BD‡ivcxq
‡KvUv w¯‹‡g ‡hvM ‡`‡e bv| wg‡mm Kycvi e‡jwQ‡jb ‡h ‡jevi g~j f~L‡Ûi BD‡iv‡ci ‡jvK‡`i Pyw³i Ask wnmv‡e M«nY Ki‡Z
B”QyK n‡e hv miKvi‡K P¨v‡bj Awfevmx‡`i d«v‡Ý ‡diZ cvVv‡Z m¶g Ki‡e, hv ‡e«w·‡Ui ci ‡_‡K m¤¢e nqwb| Z‡e wZwb ‡Rvi w`‡qwQ‡jb
g‡bvwb‡ek Ki‡e Ges BBD
‡KvUv wm‡÷‡gi m`m¨ n‡Z mvBb Avc Ki‡e bv|
‡KvUv w¯‹‡gi Aax‡b, Dˇii ivR¨¸wj eQ‡i Kgc‡¶ 30,000 Awfevmx Ges 120,000 Avk«qc«v_©x M«nY Ki‡e, BZvwj Ges wM«‡mi g‡Zv µmf~ga¨mvMixq Awfevm‡bi Pv‡c _vKv ‡`k¸wj ‡_‡K| Gw`‡K, m¨vi ‡Kqvi ‡Rvi w`‡q e‡j‡Qb ‡h ‡jevi BBD, GKK evRvi ev Kv÷gm BDwbq‡b cybivq ‡hvM`v‡bi ‡Kvb cwiKíbv ‡bB| kwbevi c«Pvivwfhv‡bi c‡_ e³… ZvKv‡j, wZwb e‡jwQ‡jb ‡h wZwb BBDGi mv‡_ GKwU fvj evwYR¨ m¤úK© Ges M‡elYv I Dbœqb, wk¶v, wbivcËv Ges Ab¨vb¨ ‡¶‡Î ÒA‡bK ‡ewk mn‡hvwMZvÓ Pvb, ‡hvM K‡ib ‡h GwU meB Av‡jvPbvi welq| ÒZ‡e Avwg g‡b Kwi Avgiv BBDi mv‡_ AviI fvj Pyw³ ‡c‡Z cvwi, Ges hw` Avgiv miKv‡i wbe©vwPZ nB Z‡e Avgiv ‡mUvB Kivi ‡Póv Kie,Ó wZwb ‡hvM K‡i‡Qb| ‡jevi ¶gZvq ‡M‡j
hvB‡nvK, ‡jevi iæqvÛv w¯‹g evwZj Kivi c«wZk«ywZ w`‡q‡Q Ges Gi cwie‡Z© hviv ‡QvU ‡bŠKvqhy³iv‡R¨ AvMZ Zv‡`i BD‡K‡Z Avk«‡qi Rb¨ Av‡e`b Kivi AbygwZ ‡`‡e,
AvµgY Ges ‡e«w·‡U `‡ji ‡iK‡Wi« Rb¨ j c¨vW wnmv‡e e¨envi




Ki‡Q| m¨vi ‡Kqvi wk¶v, c«wZi¶v Ges wbivcËv welh‡q e«v‡mj‡mi mv‡_ Nwbô mn‡hvwMZvi AvnŸvb Rvwb‡q‡Qb| wZwb AviI e‡j‡Qb ‡h wZwb k«wgK‡`i AwaKvi Ges Lv‡`¨i gvb m¤ú‡K© BBD gvb ‡_‡K weP¨yZ n‡Z Pvb bv| KbRvi‡fwUfiv `vwe K‡i‡Q ‡h 15wU Dcv‡q ‡jevi cvwU© Ò‡cQ‡bi `iRv w`‡qÓ BBD‡Z cybivq ‡hvM w`‡Z Pvq| ZvwjKvq AviI i‡q‡Q ‡h ‡jevi e‡Ki mv‡_ evwY‡R¨i evav¸wj ÒwQbœÓ Ki‡Z Pvq Ges j¶ j¶ BBD bvMwiK‡`i mvaviY wbe©vP‡b ‡fvU ‡`Iqvi AwaKvi w`‡Z Pvq| MZ eQi, k¨v‡Wv ‡nvg ‡m‡µUvwi B‡fU Kycvi e‡jwQ‡jb ‡h we«‡Ub GKwU ‡jevi miKv‡ii Aax‡b ‡h



‡W¯‹ wi‡cvU©t Zviv mevB 30 eQ‡ii Kg eqmx, me‡P‡q Kg eqmx cvuP c«v_©x wewewm‡K e‡j‡Qb ‡Kb Zviv AvMvgx gv‡mi mvaviY wbe©vP‡b `vuov‡”Qb| MZ e…n¯úwZevi, ‡c‡`«v `v KbwmKvI Zvi P~ovšÍ G‡j‡fj cix¶vq e‡mwQ‡jb wKš‘ eÜy‡`i mv‡_ D`hvcb Kivi cwie‡Z© wZwb mivmwi c«Pv‡ii c‡_ wd‡i G‡mwQ‡jb|
18 eQi eq‡m, ‡c‡W«v whwb cwðg jÛ‡b ¯^Zš¿ wnmv‡e c«wZØwb&ØZv Ki‡Qb GB eQ‡ii wbe©vP‡b `vuwo‡q _vKv me©Kwbô c«v_©x e‡j g‡b Kiv n‡”Q wZwb GKwU m¤¢ve¨ fwel¨Z Kg©Rxeb wnmv‡e ivRbxwZ m¤ú‡K© wew¯§Z wQ‡jb – wKš‘ ‡g gv‡mi ‡k‡l hLb mvaviY wbe©vPb WvKv n‡qwQj ZLbB wZwb wm×všÍ wb‡qwQ‡jb ‡h wZwb Ggwc nIqvi Rb¨ c«wZØwb&ØZv Ki‡eb|
ÒAvgvi gv ‡f‡ewQ‡jb Avwg hLb
Zv‡K c«_g e‡jwQjvg ZLb Avwg gRv KiwQjvgÓ |
cZ©yMv‡j Rb¥M«nYKvix, ‡c‡W«v hLb wkï wQ‡jb ZLb Zvi gv‡qi mv‡_ hy³iv‡R¨ P‡j G‡mwQ‡jb Ges e‡j‡Qb ‡h msm‡` Aíeqmx ‡jvK‡`i Dc¯’vcbv wQj hv
Zv‡K `vuov‡Z Abyc«vwYZ K‡iwQj|
wZwb Zvi ivRbxwZ‡Z c«fve wn‡m‡e Zvi gv, GKRb GbGBPGm bvm©‡K D‡jL
K‡i‡Qb|
ÒAvwg Avgvi gv‡K GKRb Awfevmx wnmv‡e hy³iv‡R¨ Avm‡Z ‡`‡LwQ Ges mwZ¨B, mwZ¨B K‡Vvi cwik«g K‡i‡Qb,Ó wZwb e‡j‡Qb| ÒAvwg c«_g nvZ ‡`‡LwQ Awfevmx‡`i myweav Ges Zviv Kxfv‡e Avgv‡`i A_©bxwZ‡Z mvnvh¨ Ki‡Z cv‡i|Ó
‡c‡W«v miKvix cwi‡lev¸wj‡Z AviI wewb‡qvM Ges Qywii Aciva ‡gvKv‡ejvi c«‡Póv ‡`L‡Z Pvq|
wZwb ‡`‡L‡Qb ‡h Zvi wKQy mnKg©x Zv‡`i cwievi‡K mg_©b Kivi Rb¨ A_© DcvR©‡b gv`K Ges M¨vs‡qi w`‡K SyuK‡Q| wKš‘, wZwb e‡j‡Qb, A‡bK ivRbxwZwe` Zvi ev¯—eZvi ¯ú‡ki« evB‡i|
ÒAvcwb Kxfv‡e Avkv Ki‡Z cv‡ib ‡h e¨w³iv c«vB‡fUfv‡e wkw¶Z ev A‡bK ‡ewk eqmx Ggb GKwU mgm¨vi mgvavb Ki‡eb ‡hwUi mv‡_ Zviv m¤úwK©Z n‡Z cv‡i bv?Ó
Avw_©K mg_©b ev Zvi wcQ‡b GKwU `j Qvov ¯^Zš¿ wnmv‡e c«wZØwb&ØZv GKwU P¨v‡jÄ wQj| wZwb c«wZØwb&ØZvi Rb¨ 500 cvDÛ wW‡cvwRU Kfvi K‡iwQ‡jb hv GKRb
c«v_©xi 5% ‡fvU ‡c‡j ‡diZ ‡`Iqv nq
GKwU µvDWdvÛv‡ii gva¨‡g, ‡mBmv‡_ Zvi LÊKvjxb ‡i÷y‡i‡›Ui PvKwi ‡_‡K
DcvR©b e¨envi K‡i‡Qb|
gv_©v wZwb ¯^xKvi K‡ib ‡h Bwjs mvD_j,

GKwU wbivc` ‡jevi wmU Rqjvf Kiv
KwVb|
ÒZ‡e Avkv Kwi Avwg AviI ZiæY‡`i ivRbxwZ‡Z hy³ n‡Z Abyc«vwYZ Ki‡Z
cvie|Ó
MZ 45 eQi a‡i msm` m`m¨‡`i Mo eqm 50Gi KvQvKvwQ| ivR‰bwZK mvsevw`K gvB‡Kj wµK
e‡j‡Qb, Òme mgqB ZiæY c«v_©xiv wQ‡jbÓ, GBevi AviI ‡ewk wbe©vPb Kiv m¤¢e|
wZwb Zv‡`i 20Gi `k‡K ‡ek wKQy ‡jevi c«v_©xi w`‡K Bw½Z K‡i‡Qb hviv m¤¢ve¨ weRqx Avm‡b c«wZØwb&ØZv
Ki‡Qb| Ges hw` eZ©gvb wbe©vPb mwVK nq, wZwb e‡j‡Qb ‡h A‡bK bZyb ‡jevi gyL mn Ggwc‡`i GKwU eo Uvb©Ifvi n‡Z cv‡i|
GwU, wecyj msL¨K AwfÁ Ggwc‡`i c`Z¨v‡Mi mv‡_ wgwjZ, bZyb msm‡`i Mo eqm n«v‡mi A_© n‡Z cv‡i| ‡jevi c«v_©x gv_©v IÕwbj ‡mB bZyb gyL‡`i GKRb n‡Z Avkv Ki‡Qb| 26 eQi eqmx I‡qj‡ki GKwU bZyb Avm‡b `vuwo‡q Av‡Qb|
gv_©v Av¤§vb‡dv‡W© eo n‡q‡Qb, GKwU c«v³b Lwbi kni, Ges Zvi gv Zvi 10 eQi eq‡m Zvi evev gviv hvIqvi ci Zv‡K eo K‡iwQ‡jb|
ivó«xq mg_©‡bi Dci Zvi cwiev‡ii
wbfi«ZvB Zv‡K ivRbxwZ‡Z Avm‡Z Abyc«vwYZ K‡iwQj|
wek¦we`¨vj‡qi Rb¨ c«¯—yZ Kiv Zvi c«‡qvRbxq eB¸wj ‡Kbvi Rb¨ Zvi
wk¶vi i¶Yv‡e¶Y Aby`vb e¨envi K‡i,
gv_©v ‡Kgwe«‡R GKwU e…wË wR‡ZwQ‡jb
Ges GKRb miKvix Kg©Pvix wnmv‡e
KvR Ki‡Z hvb|
wZwb wek¦vm K‡ib ‡h ZiæY‡`i
Kv‡Q GKwU Abb¨ `…wófw½ i‡q‡Q hv
Zviv ivRbxwZ‡Z Avb‡Z cv‡i, Ges
K¨viwdiw`‡b wZwb GwUB Avkv K‡ib|
ÒAvgiv Zi“Y Kɯ^i‡K c¨vUdg© Kwi
Zv wbwðZ Kiv ¸i“Z¡c~Y© ‡h Avgv‡`i
GKwU MYZš¿ Av‡Q hv mwZ¨B mgM«
hy³ivR¨‡K c«wZwbwaZ¡ K‡i|Ó
jyK A¨vjvb ‡nvgm whwb KbRvi‡fwUf‡`i c‡¶ `vuwo‡q‡Qb |
‡c‡W«v
21 eQi eqmx GB hyeK e‡j‡Qb hLb ‡ewkifvM ‡fvUviiv Zvi eqmx KvD‡K msm‡` `vuov‡Z ‡`‡L ÒAvb›`RbKfv‡e wew¯§ZÓ n‡q‡Qb, ‡mvk¨vj wgwWqvq ‡KD
‡KD c«kœ K‡i‡Qb ‡h Zvi Ggwc nIqvi Rxe‡bi AwfÁZv Av‡Q wKbv|
ÒAvwg wek¦we`¨vj‡q hvBwb,Ó jyK e‡j‡Qb, hvi c~e©eZ©x Kv‡Ri g‡a¨ i‡q‡Q Zvi ‡U‡¯‹vi ¯’vbxq kvLvq
‡PKAvDU ÷vd Kiv Ges GBP Gg Avi wm Gi Rb¨ KvR Kiv| Ògvbyl‡K eyS‡Z n‡e ‡h Avm‡j wKQy hyeK Rxe‡b A‡bK
wKQyi ga¨ w`‡q ‡M‡Q Ges Zv‡`i Kv‡Q
A‡bK wKQy ‡`Iqvi Av‡Q|Ó
KvDw›U Wvinv‡g ‡e‡o IVv, jyK e‡j‡Qb ‡h wZwb Abyfe K‡iwQ‡jb ‡h GjvKvwU
‡jevi ivRbxwZwe`‡`i Øviv ÒgÄyi Kiv
n‡q‡QÓ|
wZwb ‡h gva¨wgK we`¨vj‡q wM‡qwQ‡jb
‡mwU‡K Ach©vß Ges `ye©j MYcwienb ‡iU ‡`Iqv n‡qwQj hvi A_© nj Zv‡K
K‡j‡R ‡h‡Z Wvinv‡gi KvQvKvwQ ‡h‡Z
n‡qwQj|
ÒAvwg ‡mB P¨v‡jĸwj‡K wb‡R
‡`‡LwQ,Ó wZwb e‡j‡Qb, ÒGes Avgv‡K GwU m¤ú‡K© wKQy Ki‡Z ‡P‡qwQj|Ó
2019 mv‡ji mvaviY wbe©vPb hv mwZ¨B
ivRbxwZ‡Z Zvi AvM«‡ni Rb¥ ‡`q, hLb KbRvi‡fwUfiv KvQvKvwQ wekc
AKj¨vÛ mn Bsj¨v‡Ûi Dˇi c«v³b
‡jevi `y‡Mi« GKwU w÷«s wR‡ZwQj|
jyK Zv m‡Ë¡I, jyK ¯^xKvi K‡i‡Qb ‡h
Wvinvg wmwU‡Z Ggwc nIqvi wel‡q Zvi
msi¶Y wQj| 2021 mv‡j KvDwÝji nIqvi ci ‡_‡K, wZwb e‡j‡Qb ‡h wZwb
AbjvB‡b Ges e¨w³MZfv‡e DfqB
Ace¨env‡ii m¤§yLxb n‡q‡Qb|
ÒAvwg gvSiv‡Z Avgv‡K wis K‡i‡Q
‡jv‡K,Ó ‡m e‡j| ÒA_ev ‡jv‡Kiv iv¯— vq Avgvi Kv‡Q Avm‡Q Ges Ac«xwZKi K_v ej‡Q|
ÒwKš‘ GUv GKUv KviY ‡h Avwg `vuov‡Z PvB KviY GUv ‡hb bv N‡U ‡mUv Avgv‡`i wbwðZ Ki‡Z n‡e|Ó
‡i‡eKv ‡RvÝ m‡egvÎ ivRbxwZ‡Z Zvi wWwM« ‡kl K‡i‡Qb Ges wjev‡ij ‡W‡gvKª¨vU‡`i c‡¶ `vuwo‡q‡Qb| wZwb e‡jb, A‡bK ivRbxwZwe` Zvi g‡Zv Zi“Y‡`i D‡ØM ‡ev‡Sb bv| wZwb Zvi fvov enb Ki‡Z m¶g nIqvi Rb¨ cov‡kvbvi cvkvcvwk GKwU wm‡bgvq LÛKvjxb KvR K‡iwQ‡jb| GLb c~Y©Kvjxb, wZwb e‡j‡Qb ‡h Zvi gRywii 60% GiI ‡ewk Avevm‡b hvq| 21eQieqmx Qv·`i RxebhvÎvi LiP Kfvi Ki‡Z mvnvh¨ Kivi Rb¨ i¶Yv‡e¶Y Aby`vb wdwi‡q Avbv ‡`L‡Z Pvq, ‡mBmv‡_ Amva¨ fvov ‡gvKv‡ejv Kivi c`‡¶c|
hw`I Zvi eqm wQj gvÎ 13 eQi hLb hy³ivR¨ BD‡ivcxq BDwbqb Z¨vM Kivi c‡¶ ‡fvU ‡`q, GwU Zi“Y‡`i Dci ‡e«w·‡Ui c«fve wQj hv Zv‡K ivRbxwZ‡Z wb‡q Av‡m|
16 eQi eq‡m wZwb wje ‡Wg‡m ‡hvM w`‡qwQ‡jb Ges 2019 mv‡ji mvaviY wbe©vP‡b `‡ji Rb¨ wjd‡jU K‡iwQ‡jb| 2022 mv‡j wZwb jÛ‡b ¯’vbxqKvDwÝji nIqvi Rb¨ ‡`Š‡qwQ‡jb Ges c‡ii eQi ‡Wf‡b `vuwo‡qwQ‡jb, ‡hLv‡b wZwb eo n‡q‡Qb|
wZwb wbe©vwPZ nIqvi Rb¨ gvÎ 18 ‡fv‡Ui Kg wQ‡jb Zv Avwe®‹vi Ki‡Z Òwbt¯^Ó n‡qwQ‡jb, wKš‘ wZwb Avevi c«wZØwb&ØZv Kivi Rb¨ `…Xc«wZÁ wQ‡jb Gevi n¨vKwb b_© Ges ‡÷vK wbDBsU‡bi Ggwc n‡Z Pvb| ‡i‡eKv
GKRb U«vÝ gwnjv wnmv‡e, ‡i‡eKv Rbmvavi‡Yi ‡Pv‡L ‡h Ace¨envi Avb‡Z cv‡i ‡m m¤ú‡K© fvjfv‡e m‡PZb| wKš‘ wZwb Ab¨vb¨ Zi“Y‡`i mg_©b Øviv DrmvwnZ n‡q‡Qb, we‡kl K‡i GjwRwewU m¤cÖ`v‡qi KvQ ‡_‡K|
Òhw` Avwg 10wU ‡fvU ev 10,000 ‡fvU cvB, ïaygvÎ GB Ávb _vKv ‡h Avwg KvD‡K MYZvwš¿K c«wµqvq AviI RwoZ n‡Z m¶g K‡iwQ Zv c«wZwU GKK g~j¨evb K‡i ‡Zv‡j|Ó GKRb ¯’vbxq KvDwÝji wnmv‡e, im K¬vK©‡K Zvi eqm Ges AwfÁ AbjvBb Ace¨env‡ii Kvi‡Y Aeg~j¨vqb Kiv n‡q‡Q|
21 eQi eq‡m wZwb mvD_ j¨vbviKkvqvi KvDw݇ji me©Kwbô m`m¨ wQ‡jb hLb wZwb `yB eQi Av‡M wbe©vwPZ nb, wek¦we`¨vj‡q µxov ‡KvwPs Aa¨qbiZ Ae¯’vq|
ÒAvcwb g‡b K‡ib ‡h Avcbv‡K ¸iæZ¡ mnKv‡i ‡bIqvi Rb¨ wb‡R‡K AviI wKQyUv c«gvY Ki‡Z n‡e,Ó im e‡j‡Qb| ÒKLbI KLbI Avwg hLb KvDwÝj wewìs‡q nvuUwQ ZLb ‡jv‡Kiv g‡b K‡i ‡h Avwg GKRb B›Uvb©|Ó
GLb 23 eQi eqmx, wZwb ¯‹wUk b¨vkbvj cvwUi« n‡q Ggb GKwU Avm‡b `vuwo‡q‡Qb ‡hLv‡b wZwb mviv Rxeb KvwU‡q‡Qb|
2014 mv‡ji ¯‹wUk ¯^vaxbZvi MY‡fv‡Ui mgq wZwb c«_g ivRbxwZ‡Z AvM«nx n‡qwQ‡jb, hLb wZwb ÒivMÓ K‡iwQ‡jb ZLb wZwb ‡fvU ‡`Iqvi Rb¨ Lye Kg eqmx wQ‡jb| wKš‘ KvDwÝji wn‡m‡e ivRbxwZwe`iv gvby‡li Rxe‡b ‡h cv_©K¨ Ki‡Z cv‡i Zv ‡`‡LB wZwb Ggwc nIqvi wm×vš— ‡bb| n¨vwgëb Ges K¬vBW f¨vwj wRZ‡j ‡h P¨v‡jĸwj mvg‡b _vK‡Z cv‡i ‡m m¤ú‡K© im fvjfv‡e Rv‡bb| im wZwb GmGbwci gvnvBwi e¨v‡Ki AwfÁZvi K_v D‡jL K‡i‡Qb, whwb 2015 mv‡j 20 eQi eq‡m wbe©vwPZ nIqvi mgq 300 eQ‡ii g‡a¨ me©Kwbô Ggwc n‡qwQ‡jb wKš‘ GB wbe©vP‡b `vuwoh‡q‡Qb| wZwb GB wm×v‡š— Ae`vb ivLvi Rb¨ ‡mvk¨vj wgwWqvi Ace¨envi Ges I‡q÷wgb÷v‡ii Òwelv³Ó Kv‡Ri cwi‡ek‡K `vqx K‡i‡Qb|
Zv m‡Ë¡I, im GLbI Zvi ‡miv kU w`‡Z `…Xc«wZÁ|
ÒZiæYiv ïay Avgv‡`i fwel¨r bq, Zviv Avgv‡`i eZ©gvbI, Ges Zv‡`i ‡mB wm×vš— M«n‡Yi c«wµqvq RwoZ nIqv `iKvi|Ó
W¯‹ wi‡cvU©t ‡cW wmgi“ Ges
I‡qjk wjev‡ij ‡W‡gvKª¨vU ‡bZv‡`i g‡Z, cieZ©x BD‡K miKv‡ii DwPZ `yBwkï ‡ewbwdU mxgv evwZj Kiv| wewewm I‡qjm wUwfi mvaviY wbe©vP‡bi weZ‡K© Zviv GB AvnŸvb Rvwb‡q‡Q| wje ‡Wg ‡Rb WWm e‡j‡Qb ‡h cieZ©x KbRvi‡fwUf ev ‡jevi miKv‡ii ‡ewbwdU mxgv evwZj Kiv DwPZ ÒKviY GwU cwievi¸wj‡K AviI `wi`« K‡i Zyj‡QÓ|
‡cB‡Wi iæb Gwc BIiIqv_© e‡j‡Qb m¨vi ‡Kqvi ÷vigvi n‡eb cieZ©x c«avbgš¿x Ges Zvi DwPZ ÒwbôyiÓ bxwZ Zy‡j ‡bIqv|
I‡qjk ‡jevi ‡bZv fb ‡Mw_s e‡j‡Qb ‡h m¨vi wKqvi ‡ewbwdU wm‡÷‡gi Òch©v‡jvPbvÓ Ki‡eb Ges, KbRvi‡fwUf‡`i Rb¨, I‡qjk ‡m‡µUvwi ‡WwfW wUwm ‡Wwfm e‡j‡Qb ‡h ‡ewbwdU wejwU Òbvg‡Z n‡eÓ|
widg© BD‡KGi Awjfvi jyBm e‡j‡Qb ‡h Zvi `j Ò‡ewbwdU KvU‡e bvÓ|

UyPvBì K¨vc, hv 2017 mv‡j Pvjy Kiv n‡qwQj, ‡ewkifvM cwiev‡ii c«_g `ywU wkïi Rb¨ PvBì U¨v· ‡µwWU Ges BDwbfv‡m©j ‡µwWU mxgve× K‡i|
Gi A_© nj cwievi¸wj AwZwi³ wkï c«wZ eQ‡i c«vq 3200 cvDÛ `vwe Ki‡Z cv‡i bv, ‡i‡RvwjDkb dvD‡Ûkb w_¼ U¨v¼ e‡j‡Q|
‡Rb WWm I‡qjk wjev‡ij ‡W‡gvKª¨vU‡`i ‡bZv Ges Zv‡`i GKgvÎ ‡m‡bW m`m¨| wZwb KvwW©‡d ÷ywWI `k©K‡`i e‡jwQ‡jb ‡h R¡vjvbx Ges Lvev‡ii `vg ÒMZ `yB eQ‡i cuwPk kZvskÓ ‡e‡o‡Q|
ÒGKwU eo KviY nj GLv‡b I‡qj‡m Avgv‡`i 29% wkï `wi`«|
ÒGes KbRvi‡fwUf Ges ‡jevi c«wZ Avgvi P¨v‡jÄ, Zviv ¶gZvq _vK‡j, Avcwb wK Avgv‡`i myweavi Dci `ywU wkïi K¨vc evwZj Ki‡eb KviY GwU Avgv‡`i cwievi¸wj‡K
miKvi 1.4 wewjqb cvDÛ g~‡j¨i wcwcB aŸsm K‡i‡Q
evsjv msjvc wi‡cvU©t c«vq 1.4 wewjqb cvDÛ g~‡j¨i e¨w³MZ myi¶vg~jK miÄvg (wcwcB) aŸsm Kiv n‡q‡Q ev evwZj Kiv n‡q‡Q hv gnvgvixi mgq me‡P‡q AcPqKvix miKvix Pyw³ e‡j ‡evSv hvq| wewewm Øviv c«vß cwimsL¨vb c«Kvk K‡i ‡h GbGBPGm mieivnKvix, dyj mv‡cvU© ‡nj_ ‡Kqvi Øviv mieivn Kiv wcwcBGi Aš—Z 1.57 wewjqb AvB‡Ug mwVK gv‡bi ‰Zwi nIqv m‡Ë¡I KLbB e¨envi Kiv n‡e bv| wWcvU©‡g›U di ‡nj_ A¨vÛ ‡mvk¨vj ‡Kqvi (wWGBPGmwm), ‡hwU ‡KvwfW wcwcB µq Ges weZi‡Yi Rb¨ `vqx, e‡j‡Q ‡h GwU c«vKwbe©vPb mg‡qi Kvi‡Y GKwU wee…wZ w`‡Z A¶g wQj| ‡jevi cvwU© Pyw³wU‡K Òwe¯§qKi AcPqÓ wnmv‡e eY©bv K‡i‡Q hLb wjev‡ij ‡W‡gvKª¨vUiv e‡j‡Q ‡h GwU ÒRbmvavi‡Yi Znwe‡ji e¨vcK
Ace¨enviÓ|
dyj mv‡cvU© ‡nj_‡Kqvi ‡dm gv¯‹, ‡imwc‡iUi, ‡Pv‡Li myi¶v Ges
A¨v‡c«vb mieiv‡ni Rb¨ Gwc«j 2020 mv‡j 1.78 wewjqb cvDÛ Pyw³‡Z m¤§Z n‡qwQj GwU GKwU GKK mieivnKvixi
KvQ ‡_‡K e…nËg ‡KvwfW wcwcB AW©vi, hv miKv‡ii ‡gvU e¨‡qi 13% Gi Rb¨ `vqx|
gnvgvixi Av‡M, b_©n¨v¤úUbkvqviwfwËK ‡Kv¤úvwb, ‡hwU BwZg‡a¨B wcwcBGi GKwU we‡klÁ c«¯—yZKviK wQj, Zv‡`i 25 Rb Kg©Pvix Ges
AviI `wi`« K‡i Zyj‡Q?Ó
ÒGwU 2024 mv‡j j¾vRbK,Ó wZwb ‡hvM K‡i‡Qb|
fb ‡Mw_s, dv÷© wgwb÷vi Ges I‡qjk ‡jevi ‡bZv, e‡j‡Qb ‡h hw` ‡jevi 4 RyjvB Rqx nq Z‡e GwU ‡ewbwdU wm‡÷‡gi ch©v‡jvPbv Ki‡e, ÒAvgv‡`i Dci cwi`k©b Kiv wewfbœ bxwZ¸wj eyS‡Z, KviY Avgiv gvby‡li Rb¨ GKwU b¨vh¨ Pyw³ PvBÓ|
ÒAvwg wbwðZ ‡h Avgv‡`i GKwU b¨vh¨ myweavi e¨e¯’v _vK‡e hv cwievi¸wj‡K

800,000 cvDÛ Gi evwl©K jvf wQj|
Pyw³wU c~Y© nIqvi ci ‡_‡K ‡Kvb jvf
Rvbv hvqwb KviY 2021 mv‡j mncwiPvjK, mvivn ÷yU,50, Ges Zvi
¯^vgx wiPvW©, 53, ‡MvcbxqZvi Kvi‡Y Rvwm©‡Z Ad‡kvi e¨emvi Dci wfwË K‡i|
Zviv Ges ‡Kv¤úvbx hy³iv‡R¨i mg¯—
U¨v· c«`vb Ki‡Z _v‡K| dyj mv‡cvU© ‡nj_ ‡Kqvi ev ÷ywUm ‡KDB AbywPZ
wKQy K‡iwb|
wewewm Z`š— GbGBPGm mvcvB
‡PB‡bi Kv‡Q Z‡_¨i ¯^vaxbZv AvB‡bi
Aax‡b Qq gvm ‡gqv‡` GKvwaK
Aby‡iva K‡i‡Q, hv ¯^v¯’¨‡mev cY¨ mieivn cwiPvjbv K‡i| c«wZwµqv¸wj c«Kvk K‡i ‡h c«vq 1.4 wewjqb cvDÛ g~‡j¨i dyj mv‡cvU© ‡nj_ ‡Kqv‡ii wcwcB e¨envi Kiv n‡e bv|
GB cwimsL¨v‡b c«vq 749 wgwjqb
AvB‡Ug Aš—f©y³ i‡q‡Q hv BwZg‡a¨B
ÒeR¨© ‡_‡K GbvwR© ØvivÓ cywo‡q ‡djv ev aŸsm Kiv n‡q‡Q Ges AviI 825 wgwjqb ‡h¸wj AwZwi³ ÷K wnmv‡e ‡k«Yxe× Kiv n‡q‡Q Ò‡hLv‡b wb®úwË Ges cybe¨©envi Kiv m¤¢e djvdjÓ| m¤ú~Y© mg_©b 2.02 wewjqb wcwcB AvB‡Ug mieivn K‡i‡Q, Z‡e, ïaygvÎ 232 wgwjqb AvB‡Ug Gb GBP Gm ev Ab¨vb¨ hZœ ‡mwUs‡m cvVv‡bv n‡q‡Q| Pyw³wU ‡KvwfW gnvgvixi me‡P‡q
AcPqKvix n‡Z c«vq wbwðZ| WvUv dvg© Uv‡mj, evwn¨K Øviv msKwjZ ‡WUv ‡`Lvq ‡h ïaygvÎ GKwU Pyw³ ‡ewk e¨qeûj wQj Ges GwU wgk« cwi‡lev c«`vbKvix mieivnKvix‡`i GKwU cwimi‡K c«`vb Kiv n‡qwQj| miKvi c~‡e© Abygvb K‡iwQj ‡h Pyw³i Aax‡b myiw¶Z 85 wgwjqb cvDÛ g~‡j¨i wcwcB e¨envi Kiv n‡e bv, hv c«K…Z ‡gv‡Ui c«vq 6%|
evsjv‡`‡ki MYgva¨‡g ‡`kwUi
cywjk m`m¨‡`i wb‡q c«KvwkZ
mv¤cÖwZK c«wZ‡e`b¸‡jv‡K
ÓD‡Ïk¨g~jK I AwZiwÄZÓ
e‡j AwfwnZ K‡i Gi c«wZev` Rvwb‡q‡Q cywjk mvwf©m
A¨v‡mvwm‡qkb|
ïµevi A¨v‡mvwm‡qk‡bi Zi‡d MYgva¨‡g GKwU wee…wZ cvVv‡bv nq|
hvi wk‡ivbvg wn‡m‡e D‡jL Kiv nq Òevsjv‡`k cywj‡ki mv‡eK I eZ©gvb m`m¨‡`i m¤ú‡K© MYgva¨‡g mv¤cÖwZK mg‡qi
c«KvwkZ ev c«PvwiZ AwZiwÄZ msev` c«m‡½Ó|
m¤cÖwZ mv‡eK AvBwRwc ‡ebRxi
Avn‡g‡`i ÒA‰ea m¤ú` I `yb©xwZÓ wb‡q msev` c«Kvk K‡i GKwU cwÎKv| cieZ©x‡Z Ab¨vb¨ MYgva¨‡gI G msµvš— wewfbœ Lei wk‡ivbvg nq|
K‡qKw`b Av‡M XvKv gnvbMi cywj‡ki mv‡eK Kwgkbvi AvQv`y¾vgvb wgqvi ÔA‡Xj m¤ú`Õ wb‡qI c«wZ‡e`b c«Kvk K‡i wewfbœ MYgva¨g|
cywjk mvwf©m A¨v‡mvwm‡qk‡bi
wee…wZ‡Z Kv‡iv bvg D‡jL Kiv nqwb| Z‡e ch©‡e¶Kiv g‡b Ki‡Qb, cywj‡ki GB `yB mv‡eK kxl© Kg©KZ©v‡K ‡K›`« K‡i GB wee…wZ ‡`qv n‡q‡Q|
cywjk mvwf©m A¨v‡mvwm‡qk‡bi (wewcGm G) mvaviY m¤úv`K ‡Mvjvg ‡gv¯—dv iv‡mj wewewm evsjv‡K e‡jb, Zviv ‡Kv‡bv GKwU wbw`©ó NUbv ev e¨w³‡K ÔwgbÕ (wb‡`©k) K‡i e‡jbwb|
eis ÔZ_¨m~Î I c«gvY QvovÕ c«PvwiZ ev c«KvwkZ ÔD‡Ïk¨ c«‡Yvw`Z I gvbnvwbKiÕ msev‡`i c«wZev` Rvwb‡q‡Qb e‡j `vwe Zvi|
Av`vj‡Zi wb‡`©‡k mv‡eK cywjk c«avb ‡ebRxi Avn‡g` I Zvi cwiev‡ii m`m¨‡`i wKQy m¤úwË I e¨vsK wn‡me GiB g‡a¨ Rã Kiv n‡q‡Q| GQvov `yb©xwZ `gb KwgkbI wÁvmvev‡`i Rb¨ wg. ‡ebRxi I Zvi cwiev‡ii m`m¨‡`i Zje K‡i‡Q| wKš— Zviv GL‡bv nvwRi n
Ab¨w`‡K XvKv gnvbM‡ii mv‡eK cywjk Kwgkbvi AvQv`y¾vgvb wgqv Ôwecyj m¤ú`Õ wb‡q msev`gva¨‡g Lei c«KvwkZ n‡q‡Q| hw`I G‡¶‡Î Av`vjZ Ges `yb©xwZ `gb Kwgk‡bi Zid

‡_‡K GL‡bv ‡Kvb c`‡¶c
Av‡mwb| evsjv‡`k cywj‡ki GKRb
mv‡eK gnvcwi`k©K ‡gv. byi“j
û`v wewewm evsjv‡K e‡jb, Ò‡ckvi gh©v`v mgybœZ ivLv
A¨v‡mvwm‡qk‡bi `vwqZ¡|Ó
ZvB, Ò‡Kv‡bv Z_¨ c«gvYnxb
Awf‡hvM hw` D‡V _v‡K, ‡mUvi
c«wZev` Zviv Ki‡ZB cv‡i|Ó
Ab¨w`‡K GB ‡c«m wiwjRUv‡KB
ÔD‡Ïk¨g~jKÕ ej‡Qb U«vÝcv‡iwÝ
B›Uvib¨vkbvj evsjv‡`k
(wUAvBwe) Gi wbe©vnx cwiPvjK
KZ©v e¨w³‡`i D‡Ïk K‡i ‡jLv|
Zv‡Z ejv n‡q‡Q, Òmv¤cÖwZK mg‡q wc«›U I B‡jKU«wbK wgwWqv Ges mvgvwRK ‡hvMv‡hvM gva¨‡g evsjv‡`k cywj‡ki mv‡eK I eZ©gvb m`m¨‡`i wb‡q avivevwnKfv‡e c«KvwkZ
c«PvwiZ AwZiwÄZ wi‡cvU© m¤ú‡K© evsjv‡`k cywjk mvwf©m
A¨v‡mvwm‡qk‡bi `…wó AvK…ó n‡q‡Q|
G ai‡bi AvswkK, D‡Ïk¨c«‡Yvw`Z I XvjvIfv‡e
Òwe‡`‡k cjvZK mvBevi mš¿vmxivIÓ mvgvwRK ‡hvMv‡hvM gva¨‡g Òwg_¨v I AwZiwÄZ Z_¨ c«Kvk K‡i cywjk Kg©KZ©v‡`i PwiÎ nb‡b e¨¯—Ó D‡jL Kiv nq wee…wZ‡Z| cywjk mvwf©m A¨v‡mvwm‡qkb g‡b K‡i, evsjv‡`‡ki ‡Kv‡bv ‡Kv‡bv MYgva¨g Zv‡`i(we‡`‡k cjvZK mvBevi mš¿vmx) ÒAbyKiYÓ Ki‡Q|
Gi Ask wn‡m‡e MYgva¨g¸‡jv, Òcywj‡ki eZ©gvb I c«v³b m`m¨ m¤ú‡K© D‡Ïk¨c«‡Yvw`Z
weewR©Z Ges AwZ Kw_ZÓ e‡jI `vwe Kiv nq wee…wZ‡Z| Gm‡ei g‡a¨ Ò‡Kv‡bv ‡Kv‡bv wgwWqv nvDRÓ Gi Òe¨w³MZ
Av‡µvk I wbR¯^ ¯^v_©Ó nvwm‡ji c«‡Póv i‡q‡Q e‡jI g‡b K‡i cywjk mvwf©m A¨v‡mvwm‡qkb| Òhv mvsevw`KZvi bxwZgvjv we‡ivax,Ó ej‡Q msMVbwU| Zviv ej‡Q, ÒKx Kvi‡Y, Kvi D‡Ïk¨ nvwmj Ges Kvi g¨v‡ÛU ev¯—evq‡bi Rb¨ KwZcq wgwWqv evsjv‡`k cywj‡ki wei“‡× G ai‡bi Kyrmv iUbvq wjß, ‡mB

W. Bd‡ZLviæ¾vgvb|
ÒG‡Z c«gvY nq evwnbxi g‡a¨B
`yb©xwZi myi¶vKvix GKUv Pµ
Av‡Q,Ó wewewm evsjv‡K e‡jb wZwb|
wee…wZ‡Z Kx ejv n‡q‡Q?
wewcGmGi mfvcwZ ‡gvt
gwbi“j Bmjvg Ges mvaviY
m¤úv`K ‡Mvjvg ‡gv¯—dv iv‡mj ¯^v¶wiZ wee…wZwU MYgva¨‡gi
c«PvwiZ/c«KvwkZ AwZiwÄZ wi‡cv‡Ui« Zxe« c«wZev` Rvbv‡”Q evsjv‡`k cywjk mvwf©m
A¨v‡mvwm‡qkb|Ó wee…wZ‡Z `vwe Kiv nq, ÒMYZš¿ I ‡`kwe‡ivaxP‡µi bvkKZv c«wZnZ Kivi Kvi‡Y Zviv cywjk‡K Òc«wZc¶Ó we‡ePbv K‡i ‡bwZevPK mgv‡jvPbvq wjß|
evsjv‡`‡k Gi Av‡MI cywj‡ki wewfbœ ch©v‡qi Kg©KZ©v‡`i `yb©xwZi Lei MYgva¨‡g c«KvwkZ n‡q‡Q|
Z‡e cywjk mvwf©m A¨v‡mvwm‡qkb‡K Ggb Ae¯’vb wb‡Z mPivPi ‡`Lv hvq bv| cywjk mvwf©m
Av‡Q, ‡Kv‡bv c«wµqv m¤úbœ nIqvi Av‡MB, ‡KD ‡KD `yb©xwZevR e‡j w`‡”Qb|Ó G Kvi‡YB wewcGmG wee…wZ w`‡q‡Q e‡j Rvbvb, ‡Mvjvg ‡gv¯—dv iv‡mj| wewcGmG Zv‡`i wee…wZ‡Z msev`gva¨‡gi wi‡cvU©‡K D‡Ïk¨c«‡Yvw`Z ej‡jI U«vÝcv‡iwÝ B›Uvib¨vkbvj evsjv‡`k wUAvBwei wbe©vnx cwiPvjK B‡dZLviæ¾vgvb, GB ‡c«m wiwjR ‡`qvUv‡KB ÒD‡Ïk¨g~jKÓ e‡j g‡b K‡ib| wewewm evsjv‡K wZwb e‡jb, Òeis Zv‡`i GB ‡c«m wiwjRUvB n‡”Q D‡Ïk¨g~jK| Awfhy³‡`i wei“‡× IVv Awf‡hvM¸‡jv‡K A¯^xKvi Kivi Aïf D‡Ï‡k¨B GwU Kiv n‡q‡Q|Ó Òwee…wZ`vZv Ges Awfhy³iv GKB ‡MvÎfy³Ó D‡jL K‡i wg. Bd‡ZLvi“¾vgvb e‡jb, ÒZviv Pv‡”Q Zv‡`i mn‡hvMx‡K myi¶v ‡`qvi Rb¨| Zviv c«gvY Ki‡Q Zviv Avm‡j `yb©xwZi mnvqK|Ó mv‡eK cywjk gnvcwi`k©K ‡gvt byiæj û`v ej‡Qb, mvwf©m G‡mvwm‡qk‡bi
gvbnvwbKi ‡bwZevPK msev` c«Kvk Ki‡Q, hv evsjv‡`k cywj‡ki fveg~wZ© ¶ybœ Kivi nxb D‡Ïk¨ e‡j c«Zxqgvb n‡”QÓ wewmwcGÕi Kv‡Q| Av‡iv ejv nq, ÒMYgva¨‡g c«KvwkZ G ai‡bi wi‡cv‡Ui« AwaKvsk ‡¶‡ÎB ‡Kvb Z_¨m~‡Îi D‡jL ‡bB|Ó wi‡cvU©¸‡jv‡K Òev¯—eZv
c«kœ DÌvcb Kiv A‡hŠw³K bq|Ó cywjk mvwf©m G‡mvwm‡qk‡bi mfvcwZ gwbi“j Bmjvg, whwb eZ©gv‡b cywj‡ki ‡¯úkvj e«v‡Âi c«avb| cywjk mvwf©m G‡mvwm‡qk‡bi mfvcwZ gwbi“j Bmjvg, whwb eZ©gv‡b cywj‡ki ‡¯úkvj e«v‡Âi c«avb| Ô‡c«m wiwjRUvB D‡Ïk¨g~jKÕ

Av`bvb Gj eyik,MvRv msev``vZv, wewewm A¨vivweK; cvuP gvm eqmx Ave`yj AvwRR Avj-‡nvivwb, DËi MvRvi AvjAvnwj nvmcvZv‡ji weQvbvq ï‡q Av‡Q, Zvi ‡QvÆ kix‡i
Acywói j¶Y ¯úó|
gvÎ 3 ‡KwR (6.6 cvDÛ) IR‡bi, Ave`yj AvwRR
m¤cÖwZ wbweo cwiPh©v BDwbU (AvBwmBD) ‡_‡K Qvo[v ‡c‡q‡Q| ‡mLv‡b Zv‡K ¸iæZi Acywói Rb¨ wPwKrmv ‡`Iqv n‡q‡Q|
Zvi gv ej‡Qb wZwb MvRvq Zvi c«‡qvRbxq Lvevi cv‡”Qb bv|
ÒGwU Avgvi GKgvÎ mš—vb|
Zvi IRb Kgc‡¶ 5 ‡KwR (11 cvDÛ) nIqv DwPZ Ges Avwg Zvi ¯^v‡¯’¨i Rb¨ LyeB DwØMœ, wKš‘ Avwg Zv‡K we‡`‡k wb‡q ‡h‡Z cviwQ bv KviY mxgvš— eÜ,Ó e‡jb wZwb|
Ave`yj AvwR‡Ri MíwU Aek¨ wfbœ wKQy bq| wek¦ ¯^v¯’¨ ms¯’vi wn‡m‡e, hy× ïiæ nIqvi ci ‡_‡K cvuP eQ‡ii Kg eqmx AvU nvRv‡iiI ‡ewk wkïi Zxe«
Acywó kbv³ nq Ges wPwKrmv Kiv nq Gi g‡a¨ 1,600 wQj LyeB SyuwKc~Y©|
MZ mßv‡n, WweDGBPIÕi gnvcwiPvjK ‡U‡W«vm Avavbg ‡N‡e«B‡qmvm e‡j‡Qb, ÒB‡Zvg‡a¨B Acywói Kvi‡Y 32wU g…Z¨yi NUbv N‡U‡Q, hvi g‡a¨ 28wUB cvuP eQ‡ii Kg eqmx wkï|Ó
Ry‡bi ïiæ‡Z, RvwZms‡Ni wkï ms¯’v BDwb‡md Rvbv‡q, MvRvi c«wZ 10wUi g‡a¨ bqwU wkï Zxe« Lv`¨ Afv‡ei m¤§yLxb, c«wZw`b `yB ev ZviI Kg iK‡gi Lvevi ‡L‡q ‡eu‡P Av‡Q Zviv| G‡Z ejv nq, Ògvme¨vcx Awfhvb Ges gvbweK mnvqZvi Dci wb‡lavÁvq Lv`¨ I ¯^v¯’¨ e¨e¯’v ‡f‡O c‡o‡Q, hvi d‡j wech©qKi cwiYwZ ‡`Lv w`‡q‡QÓ Ges wkï‡`i ÒRxebûgwKc~Y© Acywói SyuwK‡ZÓ i‡q‡Q|
k~b¨ evRvi
Avgvi Rb¥ MvRvq, Avwg Avgvi cwiev‡ii mv‡_ GLv‡b emevm K‡iwQ ‡de«yqvwi ch©š—I Avwg MvRv ‡_‡KB c«wZ‡e`b K‡iwQ| hy‡×i Av‡M, Avwg DËi MvRvi AvjZydvn ‡Rjv‡K nvRv‡iv ‡µZvi wf‡o RgRgvU GKwU ¯’vb wn‡m‡e RvbZvg, wKš‘ GLb hLb Avwg ‡mLv‡b _vKv ‡jvK‡`i ‡dvb K‡i cwiw¯’wZ m¤ú‡K©
Rvb‡Z PvB, Zviv Avgv‡K ‡h
Qwe cvVvq, Zv‡Z ‡`Lv hvq GwU
GLb c«vq Rbk~b¨|
ÒU‡g‡Uv ‡bB, kmv ‡bB, dj ‡bB, Ges iæwUI ‡bB,Ó evRv‡ii
GK eq¯‹ e¨w³ mvwjg kvevKv
e‡jb| wZwb Rvbvb ‡h ‡Kej wKQy e¨eüZ ‡cvkvK Ges mxwgZ cwigv‡Y wUbRvZ Lvevi wewµi
Rb¨ i‡q‡Q|

ÒAvgiv Ggb Rxeb KLbI
RvbZvg bv ‡Kbvi ev wewµi
Rb¨ wKQy ‡bB,Ó Av‡iKRb
we‡µZv ‡hvM K‡ib|
ÒAvgvi mvZwU mš—vb Av‡Q
Ges Avwg ‡Kv‡bv ÎvY mvnvh¨ cvBwb|Ó
c«wZw`b, ÒwU‡KqvmÓ ‡QvU
Lvev‡ii ÷j ‡hLv‡b webvg~‡j¨
Lvevi c«`vb Kiv nq, Zv‡`i mvg‡b `xN© mvwi ‡`Lv hvq|
A‡b‡KB DËi MvRvq wKQyUv
m”Qj e¨w³‡`i KvQ ‡_‡K
Avw_©K mvnvh¨ ‡c‡q _v‡K, wKš‘
mieiv‡ni NvUwZ Zv‡`i fwel¨r
AwbwðZ K‡i Zy‡j‡Q|
GLb GwU Ggb GKwU ¯’vb
‡hLv‡b wKQy wkï GKUy Mig
Lvev‡ii Avkvq wfo K‡i, Avi
cwieZ©bI ‡Pv‡L c‡o| Avi WweDGBPIi c«avb W. ‡U‡W«vm mZK© K‡i e‡jb ‡h, ÒLv`¨ mieivn e…w×i wi‡cvU© _ vKv m‡Ë¡I, eZ©gv‡b Ggb ‡Kv‡bv c«gvY ‡bB ‡h, hv‡`i me‡P‡q ‡ewk c«‡qvRb Zviv ch©vß cwigvY Ges ¸YMZ gv‡bi
Lvevi cv‡”Q|Ó wZwb AviI e‡jb, wbivcËvnxbZv Ges bvbvb wb‡lavÁvi d‡j, eZ©gv‡b ¸iæZi Acywó‡Z
Avµvš— ‡ivMx‡`i Rb¨ gvÎ `ywU wPwKrmv ‡K›`« Pvjy i‡q‡Q| wZwb mZK© K‡i‡Qb ‡h ¯^v¯’¨ ‡mev, weï× cvwb Ges m¨vwb‡Uk‡bi
Afve ÒAcyó wkï‡`i SyuwK D‡jL‡hvM¨fv‡e evwo‡q ‡`q|Ó
GB cwiw¯’wZi Kvi‡Y msµvgK wewfbœ ‡ivM, ‡hgb ‡ncvUvBwUm, Qwo‡q covi m¤¢vebvI ‡ewk|
yP¨yZ n‡qwQ, Ges c«wZw`b gvbyl gviv hv‡”Q|Ó
ÒAvgiv cïcvwL‡`i Lvevi ‡L‡qwQ, Ges Acywói Kvi‡Y wkï I bvixiv AÁvb n‡q co‡Q| ‡ivM Avgv‡`i kixi‡K ‡L‡q ‡d‡j‡Q|Ó wdwjw¯—wb Wv³vi ‡gvZv‡mg mvC` mvjvn, nvgvm cwiPvwjZ ¯^v¯’¨ gš¿Yvj‡qi Riæwi KwgwUi GKRb m`m¨, wbwðZ K‡i‡Qb ‡h c«wZw`b Acywói A‡bK¸wj NUbv wi‡cvU© Kiv n‡”Q, we‡kl K‡i wkï‡`i g‡a¨ Ges Mf©eZx I ¯—b¨`vbKvix gwnjv‡`i g‡a¨| wZwb e‡jb, A‡bK gvbyl, hviv BwZg‡a¨B `xN©¯’vqx ‡iv‡M fyM‡Q, Zviv GLb Ab¨vb¨ ¯^v¯’¨ cwiw¯’wZi mv‡_I msM«vg Ki‡Q|
nvgvm cwiPvwjZ ¯^v¯’¨ gš¿Yvjq ej‡Q ‡h, hy× ïi“i ci ‡_‡K 37,000GiI ‡ewk wdwjw¯—wb wbnZ n‡q‡Q, Ges AviI nvRvi nvRvi gvbyl AvnZ ev ev¯—yP¨yZ n‡q‡Q| MvRvi gvbyl wU‡K _vKvi Rb¨ gvbweK mnvqZvi w`‡K ZvwK‡q Av‡Q, wKš‘ ch©vß mieivn ‡mLv‡b ‡cŠuQv‡Z cvi‡Q bv| GKmgq MvRvi `w¶‡Y wgk‡ii mxgv‡š— ivdvn µwms wQj mnvqZvi c«avb c«‡ekc_, wKš‘ GLb Bmiv‡qj MvRvi cv‡ki µwmswU wbqš¿Y Ki‡Q, d‡j GwU eÜ n‡q ‡M‡Q| `w¶‡Y AviI i‡q‡Q Bmiv‡qj ‡_‡K ‡Lvjv ‡K‡ig kv‡jvg ‡MUI‡q, Z‡e hy‡×i Kvi‡Y GB iæ‡U mnvqZvi c«evn mxwgZ n‡q‡Q|

Ab¨iv `xN© c_ cvwo w`‡q ‡nu‡U cvwb Avb‡Z hvq| ¶yav I ‡ivM c«vq c«wZw`bB Avwg MvRvq _vKv AvZ¥xq Ges eÜy‡`i mv‡_ K_v ewj| Zv‡`i cvVv‡bv Qwe‡Z Avwg ‡`L‡Z cvB Zviv ïwK‡q hv‡”Q Ges Zv‡`i gy‡Li
‡ewkifvM nvmcvZvj Ges
wK¬wbK eÜ i‡q‡Q, Ges ‡h¸wj
GLbI Pvjy i‡q‡Q ‡m¸wj
¶wZM«¯Í Ges RbvKxY©|
ÒAvgiv G‡Kev‡i K¬vš— Ges kw³nxb,Ó e‡jb DËi MvRvi
Rvevwjqvi e…×v Dg dyqv` Rv‡ei| ÒAvgiv K‡qKevi ev¯—
gvbweK mnvqZvi P¨v‡jÄ hy× ïiæ n‡qwQj MZ eQ‡ii
7B A‡±vei, hLb nvgvm Bmiv‡q‡j AvµgY K‡i c«vq 1,200 gvbyl‡K nZ¨v K‡i Ges 251 Rb‡K wRw¤§ K‡i MvRvq wb‡qqAv‡m|
Lvivc AvenvIqvq ¶wZM«¯— n‡q GKwU gvwK©b fvmgvb ‡RwU K‡qKw`b a‡i eÜ Ae¯’vq wQj Ges c‡i Avš—R©vwZK mxgvbvq mvgwqKfv‡e miv‡bv n‡q‡Q| we‡k¦i wekwU Avš—R©vwZK mvnvh¨ ms¯’v mZK© K‡i e‡j‡Q ‡h ÒMvRvi g‡a¨ AwbqwgZ mnvqZv, GK ai‡bi gixwPKv ‰Zwi K‡i‡Q, hLb gvbweK mvnvh¨ c«wµqv c«vq ‡f‡O covi c‡_|Ó MZ mßv‡n, MvRvi nvgvmwbqwš¿Z miKvi Rvbvq ‡h c«wZw`b MvRvq 35wUi ‡ewk U«vK ‡cŠuQv‡”Q
Drm| wKš‘ 13 Ryb, Bmiv‡q‡ji gvbweK mgš^q KZ©…c¶ ‡KvMvU mvgvwRK gva¨g G‡· GKwU
wKQy Lv`¨ mnvqZv Dˇi bZyb µwms c‡q‡›Ui gva¨‡g cvVv‡bv n‡”Q, Z‡e RvwZms‡Ni cwimsL¨vb Abymv‡i 7B ‡g ‡_‡K mnvqZvi cwigvY `yBZ… Zxqvsk K‡g wM‡q‡Q, Ges wek¦ Lv`¨ Kg©m~wPi g‡Z `w¶‡YI mieivn n«vm cv‡”Q|
Kiv n‡q‡Q| MvRvq c«‡e‡ki Rb¨ gvbweK mnvqZvi ‡Kvb cwimxgv ‡bB, mg¯— ai‡bi IlyaI GLv‡b c«‡ek Ki‡Z cv‡i|Ó GKB w`‡b Av‡iKwU ‡cv‡÷ ejv nq ‡h, IB w`b 220wU mnvqZvi U«vK MvRvq c«‡ek K‡i‡Q| GwU Lv`¨ Ges Ab¨vb¨ mieivn weZi‡Y mvnvh¨ ms¯’v¸wji e¨_©Zv‡K `vqx K‡i e‡j‡Q ‡h c«vq 1,400 mnvqZv U«vK GLbI c«‡ek Kivi Rb¨ A‡c¶vq i‡q‡Q| RvwZmsN e‡j‡Q, ‡hme ÎvY c«‡ek Ki‡Q, ‡mUv wewj Ki‡Z wM‡q KvovKvwo, AvBbk…•Ljv ‡f‡O cov Ges Ab¨vb¨ Bmiv‡qwj wb‡lavÁvi Kvi‡Y gvivZ¥Kfv‡e GB mnvqZv evavM«¯— n‡”Q| ‡iveevi Bmiv‡qwj ‡mbvevwnbx `w¶Y MvRvi GKwU moK eivei AviI gvbweK mnvqZv c«‡e‡ki AbygwZ w`‡Z c«wZw`b GKUv ÒmvgwiK Kvh©Kjv‡ci ‡KŠkjMZ weiwZÓ ‡NvlYv K‡i‡Q| Z‡e Zviv ‡Rvi w`‡q e‡j‡Q ‡h, ‡Kvb hy×weiwZ ‡bB Ges ivdvn‡Z hy× Pj‡e| Bmiv‡qj e‡j‡Q ‡h ivdvn Zv‡`i Awfhv‡bi c«‡qvRb nvgvm‡K Zv‡`i Ò‡kl c«avb NvuwUÓ ‡_‡K DrLvZ Kivi Rb¨| RvwZms‡Ni GKRb gyLcvÎ GB ‡NvlYv‡K ¯^vMZ Rvwb‡q e‡j‡Qb, G‡Z GLbI mnvqZvi cwigvY ev‡owb| RvwZms‡Ni ms¯’v¸wj Gi Av‡MI mZK© K‡iwQj ‡h mwnsmZv Ae¨vnZ _vK‡j, RyjvB‡qi gvSvgvwS mg‡q MvRvq GK wgwjq‡biI ‡ewk wdwjw¯Íwb Zxe« Lv`¨vfv‡ei gy‡LvgywL n‡Z cv‡i|
‡W¯‹ wi‡cvU©t wdwjw¯—‡bi cwðg Zx‡i Awfhvb Pvjv‡”Q
Bmiv‡qwj ‡mbvevwnbx| GiB
g‡a¨ GB Awfhv‡bi GKwU wfwWI Qwo‡q c‡o‡Q mvgvwRK ‡hvMv‡hvM gva¨‡g, ‡hLv‡b ‡`Lv hv‡”Q Bmiv‡qwj ‡mbvevwnbxi
GKwU mvu‡Rvqv hv‡bi mvg‡b
‡eu‡a wb‡q hvIqv n‡”Q ga¨ eq¯‹ GK e¨w³‡K|
GB NUbvq Bmiv‡qwj mvgwiK evwnbx ej‡Q, Zv‡`i evwnbx cwðg Zx‡ii ‡Rwbb kn‡i Awfhv‡bi mgq AvnZ wdwjw¯— wb e¨w³‡K Zv‡`i Mvwoi mvg‡b ‡eu‡a wb‡q wM‡q ‡c«v‡UvKj j•Nb
K‡i‡Q|
NUbvwUi wfwWI avi‡Yi ci mvgvwRK ‡hvMv‡hvM gva¨‡g
Zv Qwo‡q co‡j Bmiv‡q‡ji c«wZi¶v evwnbx ‡mwU wbwðZ
K‡i|
Bmiv‡qwj c«wZi¶v evwnbx
Zv‡`i wee…wZ‡Z e‡j‡Q, Awfhv‡bi mgq ‡Mvjv¸wji mgq
IB e¨w³ AvnZ n‡q‡Qb| wZwb G NUbvq GKRb m‡›`nfvRb wQ‡jb|
Z‡e AvnZ e¨w³i cwievi ej‡Q, AvnZ nIqvi ci hLb
Zviv GKwU A¨v¤^y‡jÝ ‡P‡qwQj
ZLb Bmiv‡qwj evwnbx Zv‡K
AvUK K‡i Ges c‡i mvu‡Rvqv hv‡bi e‡b‡Ui mv‡_ Zv‡K ‡eu‡a wb‡q hvq|
cieZ©x‡Z Aek¨ IB e¨w³‡K wPwKrmvi Rb¨ ‡iW wµ‡m‡›U ¯’vbvš—i Kiv n‡q‡Q e‡j

Rvbv‡bv n‡q‡Q| GK wee…wZ‡Z Bmiv‡qwj c«wZi¶v evwnbx Rvwb‡q‡Q, G NUbvi Z`š— Kiv n‡e| c«Z¨¶`k©xiv evZ©v ms¯’v iqUvm©‡K Rvwb‡q‡Qb, AvnZ e¨w³i bvg gyRvwn` AvRwg| wZwb ‡mLvbKvi ¯’vbxq evwm›`v e‡jI kbv³ K‡i‡Qb Zviv| wee…wZ‡Z Bmiv‡qwj c«wZi¶v evwnbx e‡j‡Q, Òkwbevi Iqvw` eyiwKb GjvKvq m‡›`nfvRb‡`i ai‡Z mš¿vmwe‡ivax Awfhv‡bi mgq mš¿vmxiv Bmiv‡qwj ‡mbv m`m¨‡`i j¶¨ K‡i ¸wj Pvjvq| Rev‡e cvëv ¸wj Pvjvq
Bmiv‡qwj ‡mbvevwnbx
Ges GB e›`yK hy‡×i mgq m‡›`nfvRb‡`i g‡a¨ GKRb AvnZ I ‡M«ßvi n‡q‡Q|Ó
wee…wZ‡Z AviI ejv nq, ÒAW©vi I ÷¨vÛvW© Acv‡iwUs bxwZ j•Nb K‡i m‡›`nfvRb e¨w³‡K
GKwU Mvwoi Dc‡i ‡eu‡a ivLv n‡qwQj|Ó
ÒIB NUbvi wfwWI‡Z hv ‡`Lv
hv‡”Q, Zv Bmiv‡qwj evwnbxi AvPiY Ges g~j¨‡ev‡ai mv‡_ m½wZc~Y© bq,Ó e‡jI Rvbv‡”Q
Bmiv‡qwj c«wZi¶v evwnbx ev AvBwWGd|
GB NUbvwU Z`š— K‡i ‡m
Abyhvqx e¨e¯’v ‡bIqv n‡e e‡jI Rvbv‡bv nq IB wee…wZ‡Z|
Gw`‡K, nvgvm e‡j‡Q MvRv kn‡ii feb¸‡jv‡Z `yÕwU Bmiv‡qwj wegvb nvgjvi NUbvq Kgc‡¶ 38 Rb wbnZ Ges Av‡iv ‡ek K‡qKRb AvnZ n‡q‡Q| Z‡e Bmiv‡qwj mvgwiK evwnbxi `vwe, IB hy×wegvb nvgv‡mi mvgwiK AeKvVv‡gv‡Z nvgjv Pvwj‡q‡Q Ges G wel‡q c‡i AviI we¯—vwiZ Rvbv‡e e‡jI Rvwb‡q‡Q AvBwWGd| MvRvi ‡emvgwiK KZ©…c‡¶i
GKRb gyLcvÎ e‡j‡Qb, MvRvi HwZnvwmK kiYv_©x wkwei¸‡jvi g‡a¨ GKwU AvjkvwZ GjvKvi AvevwmK e‡K GB nvgjvq ‡ek K‡qKRb AvnZ n‡q‡Qb| nvgvm cwiPvwjZ miKvwi MYgva¨g ej‡Q, Av‡iKwU nvgjvq AvjZydvn ‡Rjvi evwoNi‡K j¶¨e¯—y Kiv n‡q‡Q| nvgjvi NUbvi wKQy wfwWI dy‡U‡R ‡`Lv hv‡”Q, ‡jvKRb AvnZ‡`i mwi‡q wb‡q hv‡”Q Ges aŸsm¯—~‡ci g‡a¨ ‡eu‡P _vKv gvbylR‡bi mÜvb Ki‡Qb A‡b‡K| nvgjvi ci iv¯—v, evwoNi ay‡jv I ‡avuqvq Av”Qbœ
wQj| nvgv‡mi GKRb wmwbqi Kg©KZ©v‡K j¶¨ K‡i GB wegvb nvgjv Pvjv‡bv n‡Z cv‡i e‡j `vwe K‡i‡Q Bmiv‡qwj MYgva¨g| MvRvi ‡emvgwiK KZ©…c‡¶i gyLcvÎ ‡nv‡mb gynvB‡mb GGdwc‡K e‡j‡Qb ‡h GB nvgjvi c«fve c«ej f~wgK‡¤úi
Kivi AvnŸvb Rvwb‡q‡Qb wee… wZ‡Z|
n‡¾i mgq Kgc‡¶ 1,301 Rb gviv ‡M‡Qb- ‡mŠw` Avie
‡W¯‹ wi‡cvU©t n‡Ri mgq Kgc‡¶ 1301 Rb gviv ‡M‡Q, ‡mŠw` Avie ej‡Q, ‡ewkifvM
Abby‡gvw`Z nRhvÎx hviv Zxe« Mi‡g `xN© `~iZ¡ cv‡q ‡nu‡UwQ‡jb|
GB eQ‡ii n‡R GKwU Zvcc«ev‡ni mgq n‡qwQj, ‡hLv‡b ZvcgvÎv KLbI KLbI 50 wWM«x ‡mjwmqvm Qvwo‡q wM‡qwQj miKvwi ‡mŠw` evZ©v ms¯’v GmwcG Rvwb‡q‡Q, hviv gviv ‡M‡Q Zv‡`i wZbPZy_©vs‡kiI ‡mLv‡b _vKvi AvbyôvwbK AbygwZ ‡bB Ges Zviv ch©vß Avk«q QvovB mivmwi m~h©v‡jv‡Ki wb‡P ‡nu‡U‡Qb| hviv gviv ‡M‡Qb Zv‡`i g‡a¨ K‡qKRb eq¯‹ ev `xN©¯’vqx Amy¯’ wQ‡jb, ms¯’vwU ‡hvM K‡i‡Q| ¯^v¯’¨gš¿x dvn` AvjRvjv‡Rj e‡j‡Qb ‡h Zv‡ci Pv‡ci wec` Ges nRhvÎxiv Kxfv‡e GwU
c«kwgZ Ki‡Z cv‡i ‡m m¤ú‡K© m‡PZbZv evov‡bvi c«‡Póv Kiv n‡q‡Q| ¯^v¯’¨ myweav¸wj c«vq Aa© wgwjqb
nRhvÎx‡K wPwKZ&mv K‡i‡Q, hvi g‡a¨ 150,000GiI ‡ewk
hv‡`i Kv‡Q AbygwZ ‡bB, wZwb e‡jwQ‡jb Ges ‡KD

‡KD GLbI Zvc K¬vwš—i Rb¨
nvmcvZv‡j i‡q‡Qb| ÒAvjvn ¶gv Kiæb Ges g…Z‡`i c«wZ ing Ki“b| Zv‡`i cwiev‡ii c«wZ Avgv‡`i Avš— wiK mg‡e`bv RvbvB,Ó wZwb e‡jb|
‡mŠw` Avie nR‡K wbivc` Ki‡Z AviI wKQy bv Kivi Rb¨
mgv‡jvwPZ n‡q‡Q, we‡kl K‡i
AwbewÜZ nRhvÎx‡`i Rb¨
hv‡`i kxZvZc wbqwš¿Z Zvuey Ges Awdwmqvj nR cwien‡bi g‡Zv myweavi A¨v‡·m ‡bB| ‡mŠw` Avi‡ei RvZxq AvenvIqv
‡K›`« Abymv‡i, g°vq ZvcgvÎv 51.8 wWwM« ‡mjwmqvm ch©š—
‡e‡o‡Q|
wek¦Ry‡o ‡`k¸wj Zv‡`i bvMwiK‡`i g…‡Zi msL¨v m¤ú‡K©
Avc‡WU w`‡”Q, Z‡e ‡mŠw` Avie iweevi ch©š— g…Z¨yi wel‡q c«Kv‡k¨ gš—e¨ K‡iwb ev miKvix ‡Uvj c«`vb K‡iwb| evZ©v ms¯’v GGdwc GKRb Avie K~UbxwZ‡Ki D×…wZ w`‡q Rvwb‡q‡Q ‡h 658 wgkixq gviv
‡M‡Q| B‡›`v‡bwkqv e‡j‡Q ‡h Zvi 200 R‡biI ‡ewk bvMwiK c«vY nvwi‡q‡Q, ‡hLv‡b fviZ 98 R‡bi g…Z¨yi msL¨v w`‡q‡Q| cvwK¯—vb, gvj‡qwkqv, RW©vb, Bivb, ‡m‡bMvj, my`vb Ges Biv‡Ki ¯^vqËkvwmZ Kyw`©¯—vb AÂjI g…Z¨yi welqwU wbwðZ K‡i‡Q|
nR nj cweÎ bMix g°vq gymjgvb‡`i Øviv Kiv evwl©K nRhvÎv| Avw_©K I kvixwiKfv‡e m¶g mKj gymjgvb‡K Zv‡`i Rxe‡b Aš—Z GKevi nRhvÎv m¤úbœ Ki‡Z n‡e| G eQi c«vq 1.8 wgwjqb gvbyl Ask wb‡q‡Q, ‡mŠw` Avie Rvwb‡q‡Q| g…Z¨yi msL¨v, we‡klZ Abby‡gvw`Z nRhvÎx‡`i RwoZ ‡_‡K djc«m~ n‡”Q| kwbevi, wgkixq c«avbgš¿x ‡gv¯—dv gv`‡eŠwj 16wU ch©Ub ‡Kv¤úvwbi jvB‡mÝ ‡K‡o wb‡q‡Qb Ges Zv‡`i cwiPvjK‡`i g°vq A‰ea nRhvÎv m¶g Kivi Rb¨ c«wmwKDUi‡`i Kv‡Q ‡idvi K‡i‡Qb| ïµevi RW©vb e‡j‡Q ‡h Zviv ‡ek K‡qKRb U«v‡fj G‡R›U‡K AvUK K‡i‡Q hviv g°vq gymwjg nRhvÎx‡`i AbvbyôvwbK åg‡Y mnvqZv K‡iwQj| Gw`‡K wZDwbwmqvi ‡c«wm‡W›U KvBm mvB` ag©gš¿x‡K eiLv¯— K‡i‡Qb| nR cviwgU ‡KvUv c×wZ‡Z ‡`k¸wj‡Z eivÏ Kiv nq Ges jUvwii gva¨‡g e¨w³‡`i g‡a¨ weZiY Kiv nq|

evsjv‡`‡ki ¯^vaxbZv, mve©‡fŠgZ¡ I MYZ‡š¿i AZ›`« c«nix weGbwc ‡Pqvicvm©b I wZbev‡ii wbe©vwPZ mv‡eK mdj c«avbgš¿x gv`vi Ae ‡W‡gv‡µwm ‡`k‡bÎx ‡eMg Lv‡j`v wRqvi Avï ‡ivMgyw³ I `xN©vqKvgbvq MZKvj 23 Ryb ev` AvQi c~e© jÛ‡bi we«K‡jb Rv‡g gmwR‡` hy³ivR¨ weGbwci D‡`¨v‡M wgjv` I ‡`vqv gvnwdj Abyw÷Z nq| weGbwc ‡Pqvicvm©‡bi Dc‡`óv I hy³ivR¨ weGbwci mfvcwZ Gg G gvwjK I ‡K›`«xq weGbwci wbe©vnx m`m¨ I hy³ivR¨ weGbwci mvaviY m¤úv`K KqQi Gg Avn‡g` Gi mvwe©K
ZË¡veav‡b Abyw÷Z wgjv` I ‡`vqv gvnwd‡j hy³ivR¨ weGbwc Ges A½ I mn‡hvMx msMV‡bi ‡bZ…e…›` mn KwgDwbwUi ‡bZ…e…›` Dcw¯’Z wQ‡jb| ‡`vqv c~e© msw¶ß e³‡e weGbwc ‡Pqvicvm©‡bi Dc‡`óv I hy³ivR¨ weGbwci mfvcwZ Gg G gvwjK gv`vi Ae ‡W‡gv‡µwm ‡eMg Lv‡j` wRqvi Avï ‡ivMgyw³ I `xN©vqy Kvgbvi Rb¨ gnvb iveŸyj Avjvwg‡bi Kv‡Q ‡`vqvi Rb¨ AvMZ gymwj‡`i c«wZ AvneŸvb Rvbvb| wgjv` I ‡`vqv gvnwd‡j knx` ‡c«wm‡W›U wRqvDi ingvb exi DËg I knx` AvivdvZ ingvb ‡Kv‡Kvi AvZ¥vi gvM‡divZ Ges weGbwci fvic«vß ‡Pqvig¨vb ‡`kbvqK Zv‡iK ingv‡bi `xN©vqy Kvgbv mn we‡k¦i gymwjg D¤§vi kvwš—i Rb¨ gnvb Avjvn& iveŸyj Avjvgx‡bi `iev‡i ‡`vqv Kvgbv Kiv nq | wgjv` gvnwd‡j ‡`vqv cwiPvjbv K‡ib we«K‡jb Rv‡g gmwR‡`i Bgvg e…›`| wgjv` I ‡`vqv gvnwd‡j weGbwc I KwgDwbwUi ‡bZ…e…‡›`i g‡a¨ Dcw¯’Z wQ‡jb weGbwc ‡Pqvicvm©‡bi Dc‡`óv I mv‡eK Avš—R©vwZK welqK m¤úv`K gvwn`yi ingvb, weGbwc ‡Pqvicvm©‡bi Dc‡`óv I evsjv‡`k mywc«g ‡KvU© evi G‡mvwm‡qk‡bi mfvcwZ e¨vwi÷vi gvneye DwÏb ‡LvKb, weGbwci Avš— R©vwZK welqK m¤úv`K e¨vwi÷vi e¨vwi÷vi Gg G mvjvg, hy³ivR¨ weGbwci mv‡eK mfvcwZ kv‡q¯—v ‡PŠayix KyÏyQ, UvIqvi ‡ng‡jUm KvDw݇ji KvDwÝjvi mv‡eK ‡WcywU ‡gqi Awn` Avn‡g`, hy³ivR¨ weGbwci wmwbqi mnmfvcwZ Aveyj
e¨vwi÷vi nvwg`yj nK Avwd›`x wjUb, Rvmvm BD‡iv‡ci mgš^qK BKevj ‡nv‡mb, hye`‡ji ‡K›`«xq m`m¨ evei ‡PŠayix, ‡K›`«xq ‡¯^”Qv‡meK `‡ji m`m¨ ‡`‡jvqvi ‡nv‡mb kvwnb, jÛb b_© I‡q÷ weGbwci mv‡eK mvaviY m¤úv`K wMqvm Avn‡g`, jÛb gnvbMi weGbwci mv‡eK mvsMVwbK m¤úv`K Lv‡j` ‡PŠayix, hy³ivR¨ AvBbRxex ‡dviv‡gi mvsMVwbK m¤úv`K A¨vW‡fv‡KU Aveyj nvmbvZ, hy³ivR¨ weGbwci QvÎ welqK m¤úv`K BgwZqvR Gbvg Zvwbg, ‡¯^”Qv‡meK welqK m¤úv`K Kvgvj wgqv, gyw³‡hv×v welqK m¤úv`K mvw`K nvIjv`vi, c«wk¶b welqK m¤úv`K Rvwn` MvRx, mn c«Pvi m¤úv`K gBbyj Bmjvg, mn hye welqK m¤úv`K ‡gv³vw`i Avjx, mn ‡¯^”Qv‡meK welqK m¤úv`K ‡ZŠwKi kvn, mn mvwnZ¨ welqK m¤úv`K K`i DwÏb, mn c«evmx Kj¨vY welqK m¤úv`K ‡gvnv¤§` Avwid Avn‡g`, mv‡eK mn µxov welqK m¤úv`K midivR Avn‡g` midy, Kvh©wbe©vnx m`m¨ Gbvgyj nK wjUb, Avãyj nvwg` Lvb ‡n‡fb, Avwgbyi ingvb AvKivg, bvRgyj ‡nv‡mb ‡PŠayix&, hye`‡ji wmwbqi mnmfvcwZ Avãyj nK ivR, mnmfvcwZ ‡`Iqvb Avãyj evwQZ, kvbyi wgqv, mv‡eK mvsMVwbK m¤úv`K ‰mq` jv‡qK ‡gv¯—dv, ‡gvkvid ‡nv‡mb, ‡¯^”Qv‡meK `‡ji hyM¥ m¤úv`K AvwRg DwÏb, Rv‡n` ZvjyK`vi, jÛb gnvbMi weGbwci mv‡eK mnmfvcwZ Avãym mvjvg AvRv`, Avãyj KÏym, ‡ivgvb Avng` ‡PŠayix, Zywnb ‡gvjv, weGbwc ‡Pqvicvm©b ‡eMg Lv‡j`v wRqvi Avï ‡ivMgyw³ I `xN©vqy Kvgbvq hy³ivR¨ weGbwci wgjv` I ‡`vqv gvnwdj

Kvjvg AvRv`, mnmfvcwZ, gywReyi ingvb gywRe, AvjnvR¡ ‰ZgyQ Avjx, ‡Mvjvg iveŸvwb ‡mv‡nj, ZvRyj Bmjvg, Av‡e` ivRv, Gg G gywKZ, wmwbqi hyM¥ m¤úv`K cvi‡fR gwjK, hyM¥ m¤úv`K e¨vwi÷vi gI`y` Avn‡g` Lvb, Lmi“¾vgvb Lmi“, ¸jRvi Avn‡g`, wgmevû¾vgvb ‡mv‡nj, myRvZyi ‡iRv, W±i gywReyi ingvb (`߇ii `vwq‡Z¡), mv‡eK hyM¥ m¤úv`K Kvgvj DwÏb, mn mvaviY m¤úv`K ‡di‡`Šm Avjg, Avmv`y¾vgvb Avn‡g`, eveyj Avn‡g` ‡PŠayix, mv‡jn Avn‡g` wRjvb, A¨vW‡fv‡KU Lwjjyi ingvb, ‡mwjg Avn‡g` (mn `߇ii `vwq‡Z¡), mvsMVwbK m¤úv`K kvwgg
Avn‡g`, wmwbqi m`m¨ kvgmyi ingvb gvnZve, dLi“j Bmjvg ev`j, Gm Gg wjUb, Gg G mvjvg, A¨vW‡fv‡KU Zvwni ivqnvb ‡PŠayix cv‡fj, ‡Kvlva¨¶ mv‡jn MRbex, ‡K›`«xq hye`‡ji mv‡eK Avš—R©vwZK welqK m¤úv`K (hyM¥ m¤úv`K c` gh©v`v) I hy³ivR¨ hye`‡ji mfvcwZ iwng DwÏb, ‡K›`«xq ‡¯^”Qv‡meK `‡ji Avš— R©vwZK welqK m¤úv`K (mnmfvcwZ c` gh©v`v) I hy³ivR¨ ‡¯^”Qv‡meK `‡ji mfvcwZ bvwmi Avn‡g` kvwnb, hy³ivR¨ hye`‡ji mvaviY m¤úv`K AvdRvj ‡nv‡mb, hy³ivR¨ ‡¯^”Qv‡meK `‡ji mvaviY m¤úv`K Aveyj ‡nv‡mb, AvBbRxex ‡dviv‡gi mvaviY m¤úv`K
gywneyi ingvb gvwbK Gi cª`Ë e³‡e¨i cªwZev‡` jÛ‡b msev` m‡¤§jb
‡W¯‹ wi‡cvU©t `w¶Y QvZK Dc‡Rjv ev¯—evqb‡K D‡c¶v K‡i mybvgMÄ5 Avm‡bi mvsm` gywneyi ingvb gvwbK msm‡` RvEqv evRvi Dc‡Rjv ev¯—evq‡b c«`Ë e³‡e¨i c«wZev‡` ‡mvgevi jÛb evsjv ‡c«m K¬v‡e GK msev` m‡¤§j‡bi Av‡qvRb K‡i `w¶Y Dc‡Rjv ev¯—evqb cwil` BD ‡K | msMV‡bi AvnŸvqK Rvgvj DwÏb gyKyÏy‡mi mfvcwZ‡Z¡ Gmgq wjwLZ e³e¨ cvV K‡ib,e¨vwi÷vi kvn wgQevûi ingvb | m‡¤§j‡b `w¶b QvZK Dc‡Rjv cwil` BD‡Ki c‡¶ Dcw¯’Z wQ‡jb, AvjZvdyi ingvb gyRvwn`, AvjvDwÏb Avn‡g` gy³v, GW‡f‡KU Avgxi DwÏb, wgqv ‡gvnv¤§` ‡njvj, byi“j Bmjvg ,gv÷vi i“¯—yg Avjx, gKmy` Avn‡g`,mBdyj Avjg mywdqvb, gwRi DwÏb c«gyL | wjwLZ e³‡e¨, ejv nq `w¶b QvZKevmxi `xN© w`‡bi `vwe `w¶b QvZK Dc‡Rjv ev¯—evqb, wKš‘ msm‡`i PjwZ Awa‡ek‡b mybvgMÄ5
Avm‡bi msm` m`m¨ gywneyi ingvb gvwbK,GwU‡K ‡K cvk KvwU‡q, RvDqv evRv‡i Dc‡Rjv ev¯—evq‡b GKwU c¶cvZ I AmsMwZg~jK, wØav wefw³Ki m¤ú~Y© A‡hŠw³K `vex msm‡` DËvcb K‡i QvZKevmxi g‡a¨

nZvkv Ges wefvRb m…wó K‡i‡Qb e‡j
D‡jL K‡ib | Zvuiv e‡jb, mybvgMÄ ‡Rjvaxb
QvZK Dc‡Rjv 13wU BDwbqb I 1wU ‡cŠimfv wb‡q MwVZ| Zb¥‡a¨ QqwU BDwbqb (‡`vjvi evRvi, ‰Qjv AvdRjvev`, ‡Mvwe›`MÄ ‰mq`i MvuI, `w¶Y Lyigv, wmsQvcBo I fvZMvuI) wbh‡় c…_K GKwU Dc‡Rjv MV‡bi
Rb¨ GjvKvi MY¨gvb¨ e¨w³eM© `xN©w`b hver c«‡Póv I Av‡›`vjb Pvwj‡q hv‡”Qb|
QvZK Dc‡Rjvi me© `w¶Y c«v‡š—i GB QqwU BDwbqb wb‡q MwVZ n‡q‡Q mybvgMÄ ‡Rjv cwil‡`i 15 bs IqvW©| G Iqv‡Wi« `w¶b c«vš— ‡_‡K QvZK Dc‡Rjv m`i c«vq 55 wK:wg `~‡i Aew¯’Z| G A‡ji ‡`vjvi evRvi, ‰Qjv AvdRvjvev` BDwbq‡bi c~e© `w¶Y cv‡k¦© wek¦bv_ I RMbœv_cyi Dc‡Rjv Ges `w¶Ycwðg c«v‡š—i fvZMvuI BDwbq‡bi mxgvbv ‡Nulv mybvgMÄ- RMbœv_cyi moK hv RMbœv_cyi Dc‡Rjvi mv‡_ mivmwi ‡hvMv‡hvM e¨e¯’v _vKvq wbR Dc‡Rjvi mv‡_ mvgvwRK I c«kvmwbK KvVv‡gv i¶v KwVb Zi n‡q c‡o‡Q| G A‡j wewfbœ bvMwiK myweav Abycw¯’wZi Kvi‡Y GLvbKvi RbmvaviY nvwc‡q D‡V‡Qb| AvqZb I RbmsL¨vi Abycv‡Z QvZK Dc‡Rjv A‡bK ‡ewk e…n`vKvi| c~e©cwð‡g ¯’vb‡f‡` 1520wKtwg c«¯’ n‡jI DËi-`w¶‡Y G Dc‡Rjvi ‰`N¨© 70wK:wgGiI ‡ewk| ‰`‡N¨i« w`K ‡_‡K eZ©gvb QvZK Dc‡Rjv‡K `ywU
As‡k wef³ Kiv AwaKZi hyw³ m½Z I ev¯—e m¤§Z| wm‡jU mybvgMÄ gnvmoKwU G e…nr Dc‡Rjv‡K ‡gvUvgywU fv‡e `yÕwU As‡k wef³ K‡i ‡i‡L‡Q| G Kvi‡Y me‡P‡q eo c«‡qvRb QvZK Dc‡Rjv‡K wØLwÊZ K‡i Gi `w¶Yvsk mybvgMÄ ‡Rjv cwil‡`i 15 bs Iqv‡Wi« GB QqwU BDwbqb wb‡q bZyb Dc‡Rjv MVb K‡i GB e…nr Rb‡Mvwôi ‡¶‡Î bvMwiK myweavw` c«`vb Kiv| c«vq 190 eM© wK‡jvwgUvi AvqZ‡bi mywe¯—…Z GB Rbc` wb‡q 1935 mvj ‡_‡K AÎ GjvKvi gvbyl `w¶Y QvZK Dc‡Rjv bv‡g c…_K m`i `ßi ¯’vc‡bi Rb¨ miKvwi mswkó `ßi eive‡i Av‡e`b wb‡e`b K‡i Avm‡Qb| GKwU c~Y©v½ c«¯—vweZ Ò`w¶Y QvZK Dc‡RjvÓ ev¯—evqb GjvKvi gvby‡li `xN©w`‡bi `vwe| wm‡jUmybvgMÄ gnvmo‡Ki `w¶YvÂj wb‡q MwVZ Ò`w¶Y QvZK Dc‡RjvÓ
wU‡Uv‡qw›U wek¦Kvc 2024 c«vq ‡kl c‡e© P‡j G‡m‡Q| PviwU `j dvBbv‡j ‡Ljvi Rb¨ evsjv‡`k mgq Abyhvqx e…n¯úwZevi ‡fv‡i I iv‡Z gv‡V bvg‡e|
‡fvi mv‡o QqUvq `w¶Y Avwd«Kv I AvdMvwb¯—vb gy‡LvgywL n‡e, wÎwb`v` A¨vÛ ‡Uve¨v‡Mvi Zv‡iŠev wµ‡KU ‡÷wWqv‡g|
Avi ivZ mv‡o AvUUvq fviZ I Bsj¨vÛ gy‡LvgywL n‡e Mvqvbvi c«wf‡WÝ ‡÷wWqv‡g|
`w¶Y Avwd«Kv I AvdMvwb¯— v‡bi Rb¨ we‡kl GKUv gÂ
GB ‡mwgdvBbvj, ‡hB wRZyK c«_gev‡ii g‡Zv dvBbv‡j DV‡e wU‡Uv‡qw›U wek¦Kv‡ci|
`w¶Y Avwd«Kv 2009 mv‡j cvwK¯—vb I 2014 mv‡j fvi‡Zi Kv‡Q ‡n‡i ‡mwgdvBbvj ‡_‡K wQU‡K c‡owQj|
AvdMvwb¯—vb ‡cQ‡b wd‡i ZvKv‡e bv, Zviv GLv‡b G‡m‡Q BwZnvm M‡o, mvg‡b hv n‡e meB BwZnv‡mi Ask n‡q _vK‡e| gvÎ 200405 mv‡ji w`‡K
Avš—R©vwZK wµ‡KU ‡Lj‡Z ïi“ Kiv `jwU A‡÷«wjqv‡K we`vq K‡i ‡mwgdvBbv‡j RvqMv K‡i wb‡q‡Q|
fviZ 11 eQi a‡i AvBwmwm B‡f‡›U Rq cvq bv| c«wZeviB ‡dfvwiU n‡q Av‡m, we‡k¦i ‡miv ‡evjvi I e¨vUvi‡`i wb‡q KLbI ‡mwgdvBbvj, KLbI dvBbvj g¨v‡P ‡n‡i hvq `jwU|
2022 mv‡ji wU‡Uv‡qw›U wek¦Kv‡ci Mªyc c‡e© `w¶Y
Avwd«Kv I ‡mwgdvBbv‡j Bsj¨v‡Ûi wec‡¶ 10 DB‡K‡U nv‡ii ci wek¦ B‡f‡›U GKgvÎ A‡÷«wjqvi wec‡¶ ‡n‡i‡Q fviZ, Iqvb‡W wek¦Kv‡ci dvBbv‡j|
‡mB ¯§…wZi ¶Z GLbI fvi‡Zi wµ‡KUvi ‡Zv e‡UB, mg_©K‡`i g‡bI ZvRv|
‡hgb 2023 wek¦Kv‡c ‡ivwnZ kg©v‡K AvDU Ki‡Z AmvaviY K¨vP wb‡qwQ‡jb U«vwfm ‡nW, Gev‡i mycvi GBU c‡e© U«vwfm ‡nW‡K AvDU Ki‡Z K¨vP ‡bb ‡ivwnZ kg©v| mvgvwRK ‡hvMv‡hvM gva¨‡g A‡b‡KB 7 gvm Av‡Mi ‡mB g¨v‡Pi K_v g‡b Kwi‡q ‡`b|
`w¶Y Avwd«Kvi wec‡¶ cvi‡e AvdMvwb¯—vb?
AvdMvwb¯—vb 20 eQ‡ii g‡a¨ Avš—R©vwZK wµ‡K‡U ‡h mgxn Av`vq K‡i wb‡q‡Q, A‡bK wµ‡KU `j ‡mUv 50 eQ‡iI cv‡iwb|
‡mwgdvBbv‡ji GB jovB‡q ‡KvbI we‡klKB AvdMvwb¯—

v‡bi wec‡¶ `w¶Y Avwd«Kv‡K GKKfv‡e ‡dfvwiU ej‡Qb bv, Avm‡j ej‡Z cvi‡Qb bv|
‡h `j c«_g ivD‡Û wbDwRj¨vÛ, wØZxq ivD‡Û A‡÷«wjqv‡K
nvwi‡q GLv‡b G‡m‡Q Zv‡`i wei“‡× `w¶Y Avwd«Kv‡K Kvq`v K‡iB jovB Ki‡Z n‡e|
Avi `w¶Y Avwd«Kvi wµ‡KU BwZnv‡m ‡mwgdvBbvj wb‡q ‡Zgb myL¯§…wZ ‡bB|
1992, 1999, 2009, 2015, 2014, 2023 Iqvb‡W I wU
‡Uv‡qw›U dig¨v‡U G‡Ki ci
GK ‡mwgdvBbvj G‡Ki ci
GK nvi| eo e¨eav‡b nvi, wRZ‡Z _vKv g¨v‡P nvi, Aí
Gw`‡K AvdMvwb¯—vb A‡bK ‡ewk wbf©vi, Zv‡`i g‡b hZ fvi wQj Zv evsjv‡`‡ki wec‡¶ S‡i ‡M‡Q|
eQi Q‡qK Av‡M ‡U÷ ÷¨vUvm cvIqv AvdMvwb¯—vb GLb wek¦Kv‡ci ‡mwgdvBbvj ‡Lj‡e, GB K_v Uyb©v‡g›U ïi“i Av‡M e‡jwQ‡jb ‡Kej I‡q÷ BwÛqvb wµ‡KU wKse`š—x e«vqvb jviv|
Z_¨wU Ac«vmw½K ev KvKZvjxq n‡Z cv‡i, Z‡e AvdMvwb¯— vb `w¶Y Avwd«Kvi wec‡¶ ‡mwgdvBbvj ‡Lj‡e e«vqvj jviv wµ‡KU GKv‡Wwgi gv‡V| AvdMvwb¯—v‡bi kw³i RvqMv
AvdMvwb¯—v‡bi ‡evjvi‡`i wec‡¶ `w¶Y Avwd«Kvi e¨vUvi‡`i jovB, GUv g‡b Ki‡Qb wbDwRj¨vÛ wµ‡KU `‡ji mv‡eK AwabvqK w÷‡fb ‡d¬wgs|
BGmwcGb wµKBb‡dv‡Z g¨v‡Pi Av‡Mi we‡kl‡Y ‡d¬wgs e‡jb, "dvi“wK AvdMvwb¯— v‡bi Rb¨ eo kw³i RvqMv, ‡h‡nZy AvdMvwb¯—vb w¯úb wbfi« `j|"
"dvi“wK Zv‡`i KvRUv mnR K‡i ‡`q, w¯úbviiv Avµg‡Y Avmvi Av‡MB Uc AW©v‡ii 1wU ev 2wU DB‡KU wb‡q Zv‡`i KvR mnR K‡i ‡`b dvi“wK|"
wb‡q‡Qb wZwb|
evunvwZ GB ‡cmv‡ii GLb Zyjbv nq wbDwRj¨v‡Ûi BwZnv‡mi Ab¨Zg ‡miv dv÷ ‡evjvi ‡U«›U ‡ev‡ëi mv‡_, `yRbB Wvb nvwZ I‡cbvi‡`i Rb¨ GKiKg Îvm| mv‡_ Av‡Q AvdMvwb¯—v‡bi GK SvuK w¯úbvi, hv‡`i ‡bZv ivwk` Lvb| wU‡Uv‡qw›U wµ‡K‡U c«vq me `jB ivwk` Lvb‡K `‡j PvB‡e, dª¨vÂvBwR wj‡Mi me‡P‡q Av‡jvwPZ wµ‡KUvi‡`i GKRb AvdMvwb¯—vb `‡ji GB AwabvqK|
Av‡Qb b~i Avn‡g`, whwb ivwk` Lv‡bi g‡ZvB ej K‡ib, Z‡e evu nv‡Z|

e¨eav‡b nvi, WvKIqv_© jyBm
‡g_‡W nvi, fyj wn‡me K‡i nvi
GmeB N‡U‡Q `w¶Y Avwd«Kvi ‡mwgdvBbv‡ji BwZnv‡m|
Zv‡`i ‡evwjs, `w¶Y Avwd«Kv Uyb©v‡g›U Ry‡o AjivDÛ cvidg© K‡i‡Q, KwVb n‡q Avmv g¨vP wR‡Z‡Q|GB g¨vPUv n‡Z hv‡”Q
wU‡Uv‡qw›U wek¦Kvc 2024Gi m‡e©v”P DB‡KU wkKvwi GLb ch©š— dRjnK dvi“wK, gvÎ 9 M‡o 7 g¨v‡P 16 DB‡KU
‡_‡KB AvdMvwb¯—v‡bi n‡q wµ‡KU ‡Lj‡Qb, 39 eQi eqmx GB AjivDÛv‡ii ‡Q‡jI Gev‡i AvdMvwb¯—v‡bi n‡q Ab~aŸ©-19 wµ‡KU ‡Lj‡eb| AvdMvwb¯—v‡bi e¨vwUs A‡bKUvB Uc AW©vi wbfi«, evsjv‡`‡ki wec‡¶ AvdMvwb¯— vb `j K‡i 115 ivb, `yB I‡cbvi K‡ib 59 ivb| GKB fv‡e A‡÷«wjqvi wec‡¶I AvdMvwb¯—v‡bi Kiv 148 iv‡bi g‡a¨ 118 ivb Av‡m I‡cbvi‡`i RywU ‡_‡K| ingvbyjvn ¸ievR I Be«vwng Rv`iv‡bi Ici GLb A‡bKUvB wbfi« Ki‡e AvdMvwb¯—v‡bi
AviI Av‡Qb AvdMvwb¯—v‡bi me‡P‡q AwfÁ wµ‡KUvi ‡gvnv¤§` bex| bex 2004 mvj
AvdMvwb¯—v‡bi ‡KvP Bsj¨v‡Ûi mv‡eK e¨vUvi Rbv_b U«U g‡b K‡ib m¤ú~Y© Pvc `w¶Y Avwd«Kvi Ici _vK‡e| U«U Rb¥MZfv‡e `w¶Y Avwd«Kvb, ‡KcUvD‡b Rb¥, wµ‡KU ‡L‡j‡Qb Bsj¨v‡Ûi n‡q, ‡Kwfb wcUvi‡m‡bi g‡Zv| `w¶Y Avwd«Kvi ‡KvP ie Iqvëvi e‡jb, "Uyb©v‡g›U Ggb GKUv RvqMvq Av‡Q ‡hLv‡b ‡KD hw` Pvc ‡bB e‡j ‡mUv wg_¨v ejv n‡e| Avgv‡`i gv‡S GLb `ywU Abyf~wZi wgk«Y Av‡Q wPš—v Av‡Q, mv‡_ Av‡Q D‡ËRbv!"`w¶Y Avwd«Kvi AvµgY dv÷ ‡evjvi wbfi«| KvwM‡mv ivev`v, gv‡K©v Bqvb‡mb, evU©gvb Av‡Qb, mv‡_ w¯úbvi ‡Kkvf gnvivR I ZveivBR kvgwm| e¨vUvi‡`i g‡a¨ d‡g© wd‡i‡Qb KyB›Ub wW KK, `y`©vš— d‡g© Av‡Qb ‡nBbwiL K¬v‡mb| K¬v‡mb nvW© wnUvi wn‡m‡e cwiwPZ wKš‘ ¸i“Z¡c~Y© gyn~‡Z© wZwb DB‡K‡Ui gvb I cwiw¯’wZ ey‡S ‡Lj‡Z cv‡ib| w÷‡fb ‡d¬wgsGi g‡Z, K¬v‡mb Kxfv‡e AvdMvwb¯—v‡bi w¯úbvi‡`i mvgjvb GUvi Ici GB ‡mwgdvBbvj A‡bKUv wbfi« Ki‡Z cv‡i|
GQvov Av‡Qb ‡WwfW wgjvi, wiRv ‡nbwW«·|
c«avbgš¿x ‡kL nvwmbvi fviZ mdi, we‡kl K‡i fviZ‡K ‡ij U«vbwRU ‡`qvi welqwU‡K eo ai‡bi ivR‰bwZK
Bm¨y‡Z cwiYZ Ki‡Z PvB‡Q we‡ivax weGbwcmn mggbv `j¸‡jv| Gme
`‡ji ‡bZviv g‡b Ki‡Qb mvg‡bi w`b¸‡jv‡Z 'GwUB n‡e me‡P‡q
¸i“Z¡c~Y© ivR‰bwZK Bm¨y'|
ÒmiKvi Gfv‡e me wKQy fvi‡Zi nv‡Z
Zy‡j w`‡Z cv‡i bv| Avgiv mevi mv‡_ ‡hvMv‡hvM KiwQ| RbMY‡K mv‡_ wb‡q Avgiv Gi wei“‡× ‡mv”Pvi n‡ev,Ó wewewm evsjv‡K ejwQ‡jb weGbwci gnvmwPe wgR©v dLi“j Bmjvg AvjgMxi|
Gw`‡K ‡ij U«vbwRU Bm¨y‡Z mvgvwRK gva¨‡g Zxe« mgv‡jvPbv ‡`Lv hv‡”Q miKv‡ii wei“‡×| hw`I AvIqvgx jxM ej‡Q G¸‡jv we‡ivax‡`i ÔcwjwUK¨vj ‡c«vcvMvÛvÕ, hvi mv‡_ mvaviY gvby‡li m¤ú…³Zv ‡bB|
AvIqvgx jx‡Mi hyM¥ mvaviY m¤úv`K gvneye Dj Avjg nvwbd e‡j‡Qb, we‡ivax `j¸‡jv ‡Póv Ki‡Z cv‡i wKš‘ Zv‡Z RbM‡Yi mg_©b _vK‡e bv e‡j wZwb g‡b K‡ib| Zvi g‡Z fvi‡Zi mv‡_ ÔKv‡bw±wfwUi Kvi‡YÕ gvbyl DcK…Z n‡”Q e‡j ivRbxwZi gv‡V ÔfviZ Bm¨yÕi GLb Avi ‡Kvb ¸i“Z¡B ‡bB|
c«m½Z, evsjv‡`‡ki c«avbgš¿x ‡kL nvwmbvi fviZ mdiKv‡j m¤cÖwZ ‡h `kwU mg‡SvZv ¯§vi‡K mB n‡q‡Q, ‡m¸‡jvi GKwU n‡”Q ‡ij U«vbwRU|
Gi Av‡M ‡gvsjv I PÆM«vg mgy`« e›`i e¨env‡ii gva¨‡g c‡Y¨i U«vbwRU I U«vÝwkc‡g›U wb‡q fvi‡Zi `xN©w`‡bi ‡Rviv‡jv `vwe c~iY K‡iwQ‡jv evsjv‡`k| G¸‡jvi wewbg‡q evsjv‡`k KZUv A_© Avq Ki‡Q Zv wb‡qI eo c«kœ Av‡Q|
c«avbgš¿x ‡kL nvwmbv g½jevi Aek¨ msev` m‡¤§j‡b e‡j‡Qb, fviZ‡K ‡ij U«vbwRU ‡`qvi wm×v‡š— evsjv‡`‡ki ‡KvbI ¶wZ n‡e bv|
we‡ivax `j¸‡jv Kx Ki‡Z Pvq fvi‡Zi mv‡_ ¯^v¶wiZ mg‡SvZv ¯§viK ev¯—evqb n‡j evsjv‡`‡ki f~LÊ e¨envi K‡i ‡ij‡hv‡M ‡`‡ki
GK Ask ‡_‡K Av‡iK As‡k mivmwi wb‡R‡`i cY¨ cwien‡bi myweav cv‡e fviZ, hv `xN©w`b a‡iB ‡`kwU ‡P‡q AvmwQ‡jv e‡j c«Pvi Av‡Q|
weGbwc I mggbv `j¸‡jvi ‡bZv‡`i mv‡_ K_v e‡j ‡h aviYv cvIqv ‡M‡Q Zv n‡jv Zviv g‡b K‡ib fviZ‡K ‡ij U«vbwRU ‡`qvi Le‡i mviv‡`‡k Zxe« c«wZwµqv ‰Zwi n‡q‡Q|
we‡kl K‡i mvgvwRK gva¨gmn wewfbœ gva¨‡g Zxe« mgv‡jvPbvi ‡c«¶vc‡U GwUB AvMvgx w`‡bi eo ivR‰bwZK Bm¨y n‡e e‡j Zv‡`i aviYv|
weGbwci RvZxq ¯’vqx KwgwUi mfv‡ZI welqwU wb‡q we¯—vwiZ Av‡jvPbv

n‡q‡Q|
weGbwc gnvmwPe wgR©v dLi“j
Bmjvg AvjgMxi e‡j‡Qb, fviZ G hveZKvj a‡i hv hv PvBwQ‡jv Zvi meB
G miKvi w`‡q w`‡q‡Q| `iKlvKwli
Rb¨ ‡h `y GKwU Uyjm nv‡Z ivL‡Z nq ‡mwU ch©š— iv‡Lwb|
ÒA_P G m‡ei wewbg‡q evsjv‡`k wKQyB cvqwb| eis cvwb I mxgvš— nZ¨vi g‡Zv welq¸‡jv Av‡jvPbv‡ZB ‡bB| ‡`‡ki c«wZwU gvbyl ¶yä| Avgiv me `‡ji m‡½ K_v ejwQ| Gi wei“‡× RbMY‡K wb‡q ‡mv”Pvi n‡ev,Ó wZwb e‡jb|
Gi Av‡M g½jeviB GK msev` m‡¤§j‡b wZwb Rvwb‡qwQ‡jb ‡h ïµevi
G wel‡q we¯—vwiZ e³e¨ Zviv Zy‡j ai‡eb| aviYv Kiv n‡”Q ‡mLvb ‡_‡KB
G wel‡q c«wZev` Kg©m~wPi ‡NvlYv w`‡Z cv‡i `jwU|
`jwU Aek¨ c‡i GKvwaKevi e‡j‡Q Zv‡`i Kg©m~wP ev e³e¨ evsjv‡`‡ki ‡kL nvwmbvi ‡bZ…Z¡vaxb miKv‡ii wei“‡×, fvi‡Zi wei“‡× bq| `jwUi ‡bZviv e‡j‡Qb eis Zviv Pvb fviZ evsjv‡`‡ki ‡Kvb we‡kl `j bq, eis ÔRbM‡Yi mv‡_ m¤úK©Õ `…p Ki“K|
GLv‡b D‡jL Kiv ‡h‡Z cv‡i ‡h, PjwZ eQ‡ii Rvbyqvwii msm` wbe©vP‡b fvi‡Zi f~wgKv wb‡q ‡¶vf Av‡Q weGbwcmn we‡ivax `j¸‡jvi| Zviv g‡b K‡ib Ôfvi‡Zi f~wgKvi Kvi‡YÕB we‡ivax `j¸‡jvi eR©b m‡Ë¡I wbe©vPb Ki‡Z m¶g n‡q‡Q ‡kL nvwmbvi ‡bZ… Z¡vaxb miKvi|
GLb ‡ij U«vbwRU Bm¨y‡ZI weGbwc I mggbv `j¸‡jvI Zxe« mgv‡jvPbv Ki‡Q| wecex IqvK©vm© cvwUi« mvaviY m¤úv`K
nv‡Z wd‡i‡Qb| ‡ij U«vbwRU Bm¨y‡K wVKg‡Zv e¨envi bv K‡i GKZidv ‡Q‡o w`‡q‡Q miKvi| GwU ‡KD gvb‡e bv,Ó ejwQ‡jb wg. nK| Bmjvgx Av‡›`vjb evsjv‡`‡ki wmwbqi bv‡q‡e Avgxi ‰mq` gynv¤§` dqRyj Kixg `‡ji GK mgv‡e‡k e‡j‡Qb, miKvi fvi‡Zi mv‡_ ‡Mvjvwg Pyw³ K‡i‡Q, ‡hLv‡b evsjv‡`‡ki ¯^v_© mswkó wKQyB ‡bB| ÒwZ¯—vi K_v ‡bB| cvwbi K_v ‡bB| mxgvš— nZ¨v wb‡q Pyw³ ‡bB| Pyw³ n‡q‡Q evsjv‡`‡ki ey‡Ki Ici w`‡q ‡U«b fvi‡Z hv‡e| ‡bŠ e›`i fviZ‡K e¨envi Ki‡Z w`‡Z n‡e| G Pyw³ ev¯— evqb Ki‡Z ‡`qv n‡e bv,Ó wZwb ‡NvlYv K‡ib|
Rvgvqv‡Z BmjvgxI GK wee…wZ‡Z fvi‡Zi mv‡_ ¯^v¶wiZ mg‡SvZv ¯§viK¸‡jvi Zxe« mgv‡jvPbv K‡i

Gi Av‡M weGbwci mggbv `j¸‡jv fviZxq cY¨ eqK‡Ui ‡h Kg©m~wP w`‡qwQ‡jv Zv‡ZI `jwUi wmwbqi hyM¥ gnvmwPe AvbyôvwbKfv‡e msnwZ c«Kvk K‡iwQ‡jb, hv ivR‰bwZK A½‡b e¨vcK Av‡jvPbvi Rb¥ w`‡qwQ‡jv|
mvBdyj nK wewewm evsjv‡K e‡j‡Qb
‡h, wZwb g‡b K‡ib GwUB n‡e AvMvgx w`‡bi eo ivR‰bwZK Bm¨y Ges Gi wei“‡× gvbyl iv¯—vq ‡b‡g Avm‡e|
Òcvwb eÈb, mxgvš— nZ¨v me fywj‡q w`‡q‡Q| c«avbgš¿x Lvwj
e‡j‡Q, AvIqvgx jxM c«wZeviB c«nm‡bi wbe©vPb Av‡qvRb K‡i fvi‡Zi n¯—‡¶‡c evievi ¶gZvq Av‡m| Òd‡j Rbmg_©bnxb AvIqvgx jxM miKvi‡K eiveiB fviZ‡K Zyó Ki‡Z nqÓ| ‡`‡ki ¯^v_© msi¶Y Pvq RvZxq cvwU©
Z‡e ‡ij U«vbwRUmn c«avbgš¿xi fviZ md‡i ‡hme mg‡SvZv ¯§viK ¯^v¶wiZ n‡q‡Q ‡m¸‡jvi wel‡q mZK© c«wZwµqv e¨³ K‡i‡Qb RvZxq cvwUi« ‡Pqvig¨vb wR Gg Kv‡`i| wewewm evsjv‡K wZwb e‡j‡Qb ‡h, Pyw³‡Z wK Av‡Q we¯—vwiZ ‡KD Zv Rv‡b bv Ges miKviI
Ki‡Z n‡e,Ó ejwQ‡jb wg. Kv‡`i| RbM‡Yi mg_©b cv‡e bv we‡ivaxiv: AvIqvgx jxM c«avbgš¿x ‡kL nvwmbv wb‡RB g½jevi XvKvq GK msev` m‡¤§j‡b e‡j‡Qb ¶gZvq wU‡K _vKvi Rb¨ wZwb ‡`k‡K wewµ K‡ib bv|
ÒAvwg me mgq ‡`‡ki ¯^v_© i¶v K‡i Pwj| ‡kL nvwmbv G ‡`k‡K wewµ K‡i bv| KviY Avgiv G ‡`k ¯^vaxb K‡iwQ,Ó e‡j‡Qb wZwb| wZwb e‡jb, ÒhZ ‡QvU ‡nvK, GUv Avgv‡`i mve©‡fŠg ‡`k| ‡mB mve©‡fŠgZ¡ i¶v I ¯^KxqZv eRvq ‡i‡L eÜyZ¡c~Y© m¤úK© ‡i‡L KvR KiwQÓ|
‡`‡ki gvby‡li Kj¨v‡Yi K_v gv_vq ‡i‡LB fvi‡Zi m‡½ ‡ij ‡hvMv‡hvM evov‡bv n‡”Q e‡j Rvbvb c«avbgš¿x| wKš‘ Gic‡iI welqwU eo ivR‰bwZK Bm¨y n‡q DV‡Z hv‡”Q wK bv Ggb c«‡kœi Rev‡e AvIqvgx jx‡Mi hyM¥ mvaviY m¤úv`K gvneye Dj Avjg nvwbd e‡j‡Qb, we‡ivax `j¸‡jv ‡h ‡Kvb Bm¨y wb‡qB G¸‡Z cv‡i wKš‘ ‡mUv‡Z RbM‡Yi mg_©b ‡Zv ‡c‡Z n‡e|
Ò‡hUvi mv‡_ gvby‡li ‡Kvb m¤úK© ‡bB ‡mB Av‡›`vj‡b gvbyl hv‡e ‡Kb? GLv‡b fv‡jv wKQy n‡Z ‡`L‡jB GK ‡k«wYi ‡jvK mgv‡jvPbv K‡i| GUv Zv‡`i ivRbxwZ| G¸‡jvi g~j¨ RbM‡Yi Kv‡Q ‡bB,Ó wewewm evsjv‡K ejwQ‡jb wZwb| we‡klK‡`i A‡b‡K g‡b K‡ib, ‡ij U«vbwR‡Ui welq ivR‰bwZK gq`v‡b eo ‡Kvb Bm¨y n‡q DV‡e wK bv, ‡mUv A‡bK wKQyi Ici wbfi« Ki‡Q|
Rywjqvb A¨vmvÄ ‡K Ges wZwb ‡Kvb ‡Mvcb bw_ dvum K‡iwQ‡jb?
gvwK©b KZ©…c‡¶i mv‡_ mg‡SvZvi ci
Av`vj‡Z ‡`vl ¯^xKvi K‡i `xN© 14 eQi c‡i
gy³ n‡q‡Qb DBwKwjK‡mi c«wZôvZv Rywjqvb
A¨vmvÄ|
hy³ivó« miKv‡ii ‡Mvcb mvgwiK Z_¨, bw_cÎ
c«Kvk K‡i 14 eQi Av‡M e¨vcK Av‡jvPbvq
G‡mwQ‡jb wg. A¨vmvÄ| ‡mB mgq ‡_‡K wZwb hy³iv‡ó«i Iqv‡›UW ZvwjKvq wQ‡jb|
myB‡W‡b GKwU al©Y gvgjvq ‡M«dZvi Gov‡Z mvZ eQi a‡i jÛ‡bi GKy‡qWi `~Zvev‡m Avk«q wb‡q jywK‡q wQ‡jb wg. A¨vmvÄ| c‡i 2019 mv‡j hy³iv‡R¨i cywj‡ki Kv‡Q ‡M«dZvi nIqvi ci ‡m‡`‡ki KvivMv‡i wQ‡jb|
gvwK©b Av`vj‡Z ‡`vl ¯^xKvi Ki‡j GB Kvivevm‡KB Zvi kvw¯— wnmv‡e MY¨ Kiv n‡e, Avi Kviv‡fvM Ki‡Z n‡e bv, gvwK©b miKv‡ii wePvi wefv‡Mi mv‡_ GiKg GKwU mg‡SvZvi ci we«‡Ub ‡_‡K wZwb gyw³ cvb| Zv‡K gyw³ w`‡Z A‡bKw`b a‡i Aby‡iva K‡i AvmwQj wg. A¨vmv‡Äi ‡`k A‡÷«wjqv|
Gici c«kvš— gnvmvM‡ii gv‡S b`©vb gvwiqvbv Øxccy‡Äi GKwU Av`vj‡Z nvwRi n‡q ‡`vl ¯^xKvi Kivi ci Zv‡K gy³ ‡NvlYv Kiv nq|
Rywjqvb A¨vmvÄ ‡K Ges DBwKwjKm Kx? wK‡kvi eq‡mB Kw¤úDUvi ‡c«vM«vwgs‡qi Rb¨ ‡ek L¨vwZ AR©b K‡iwQ‡jb wg. A¨vmvÄ|
Zv‡K 1995 mv‡j n¨vwKs Kivi Aciv‡a Rwigvbv K‡iwQj Zvi Rb¥f~wg A‡÷«wjqvi
GKwU Av`vjZ Ges ‡m mgq Avi KLbI GgbUv bv Kivi c«wZk«ywZ w`‡qB ‡KejgvÎ Kviv`Ê Gov‡Z ‡c‡iwQ‡jb|
cieZ©x‡Z 2006 mv‡j, DBwKwjKm I‡qemvBU c«wZôv K‡ib wg. A¨vmvÄ| I‡qemvBUwUi `vwe, hy×, ¸ßPie…wË Ges `yb©xwZ m¤úwK©Z A‡bK ‡Mvcbxq miKvwi c«wZ‡e`bmn GK ‡KvwUiI ‡ewk bw_ c«Kvk K‡i‡Q GwU|
Gici 2010 mv‡j, DBwKwjKm GKwU gvwK©b mvgwiK ‡nwjKÞvi ‡_‡K Kiv Ggb GKwU wfwWI c«Kvk K‡i, hv‡Z Biv‡Ki ivRavbx evM`v‡` 18 Rb ‡emvgwiK ‡jvK‡K nZ¨v Kivi `…k¨ ‡`Lv hvq|
wfwWI‡Z GKwU KÉ ‡kvbv ‡M‡Q| ‡mB KɇK ej‡Z ‡kvbv ‡M‡Q, 'mevB‡K Rvwj‡q `vI|'
GiciB wewfbœ e¨w³‡K j¶ K‡i ‡nwjKÞvi ‡_‡K ¸wj ‡Qvov nq|
AvnZ‡`i D×v‡i GKwU Mvwo GwM‡q
G‡mwQ‡jv| ‡mwU‡K j¶ K‡iI ¸wj ‡Qvov n‡qwQ‡jv|
‡mB nvgjvq iqUv‡mi« GKRb Av‡jvKwPÎx I Zvi mnKvix gviv wM‡qwQ‡jv|
GQvovI DBwKwjKm gvwK©b ‡mbvevwnbxi c«v³b ‡Mv‡q›`v we‡klK ‡Pjwm g¨vwbh‡qi mieivn Kiv nvRvi nvRvi ‡Mvcbxq bw_ c«Kvk K‡i|
Gme bw_‡Z ejv n‡q‡Q ‡h AvdMvwb¯—v‡b hy‡×i mgq gvwK©b mvgwiK evwnbx K‡qKkÕ ‡emvgwiK bvMwiK‡K nZ¨v K‡i‡Q hv wi‡cvU© Kiv nqwb|

BivK hy× m¤úwK©Z Z_¨ dvum Kivi ci Zv‡Z ‡`Lv ‡M‡Q 66 nvRv‡ii ‡ewk ‡emvgwiK
bvMwiK nZ¨v Kiv n‡q‡Q|
BivwK ‡mbv‡`i Øviv ew›`‡`i wbh©vZ‡bi Z_¨
Ges gvwK©b K~UbxwZK‡`i Av`vb c«`vb Kiv
AvovB jvL evZ©v dvum Kiv n‡qwQ‡jv|
2001 mv‡ji ‡m‡Þ¤^i gv‡mi 11 ZvwiL wbD
Bq‡K© UyBb UvIqv‡i nvgjvi w`b G‡K Ac‡ii
Lei wb‡Z gvbylRb ‡hme ‡cRvi evZ©v c«`vb
K‡iwQ‡jb Zvi g‡a¨ ‡_‡K c«vq Qq jvL evZ©v
c«Kvk K‡iwQ‡jv DBwKwjKm|
H nvgjvi c«wZ miKvwi bvbv `߇ii
c«wZwµqvI wQj|
mePvB‡Z D‡jL‡hvM¨ evZ©vwU wQj gvwK©b
‡c«wm‡W›U m¤úwK©Z|
Zv‡Z ‡jLv wQj, "‡c«wm‡W‡›Ui Mgbc_ cwieZ©b K‡i ‡`qv n‡q‡Q| wZwb IqvwksU‡b
wdi‡Qb bv| Z‡e ‡Kv_vq hv‡eb ‡mwb‡q wZwb wbwðZ bb|"
2015 mv‡j gvwK©b Pjw”PÎ wbg©vZv c«wZôvb mwb wcKPvim-Gi c«vq `yB jvL B‡gBj I Kywo nvRvi bw_ dvum Kiv n‡qwQ‡jv|
‡mme B‡gB‡j Rvbv hvq Gb‡Rwjbv ‡Rvwj
mn weL¨vZ ZviKv‡`i m¤ú‡K© ‡Kv¤úvwbwUi
‡c«vwWDmvi wKiKg KU~w³g~jK K_vevZ©v
e‡j‡Qb|
‡mLv‡b D‡V Av‡m GKwU Pjw”P‡Î Awfbq
Ki‡Z ivwR bv nIqvq nwjDW ZviKv wjIbv‡W©v
wW K¨vwc«I‡K Kxfv‡e Mvwj ‡`qv n‡q‡Q Ges
Av‡gwiKvb nvmj Pjw”P‡Î Awfb‡qi Rb¨
Awf‡bÎx ‡Rwbdvi j‡iÝ I Gwg A¨vWvgm‡K
cyi“l Awf‡bZv‡`i Zyjbvq KZ Kg
cvwik«wgK ‡`qv n‡q‡Q|
2016 mv‡j gvwK©b ‡c«wm‡W›U wbe©vP‡bi
‡W‡gvKª¨vU c«v_©x wnjvwi wK¬bU‡bi c«PviYv
welqK c«avb Rb ‡cv‡W÷vi B‡gBj A¨vKvD›U n¨vK Kiv K‡qK nvRvi B‡gBj dvum Kiv
n‡qwQ‡jv|
Zv‡Z ‡W‡gvKª¨vU cvwU© ‡_‡K g‡bvbq‡bi Av‡M `‡ji g‡a¨ wnjvwi wK¬bU‡bi c«wZØb&Øx
m¨vÛvm© m¤ú‡K© KU~w³ Kiv n‡qwQ‡jv| wbe©vP‡bi Av‡M c«v_©x‡`i g‡a¨ ‡h weZK© ‡Uwjwfk‡b c«Pvi Kiv nq Zv‡Z wmGbG‡bi mvsevw`K wnjvwi wK¬bUb‡K GKwU c«kœ m¤ú‡K© Av‡MB Rvwb‡q w`‡qwQ‡jb|
GB weZ‡K© c«v_©xiv ‡Kgb Reve w`‡jb Zv ‡fv‡Ui Dci c«fve ‡d‡j e‡j g‡b Kiv nq|
DBwKwjK‡mi wel‡q gvwK©b miKv‡ii c«wZwµqv gvwK©b wePvi wefvM 2019 mv‡j GB bw_ dvu‡mi NUbv‡K "gvwK©b hy³iv‡ó«i BwZnv‡m Z‡_¨i ‡MvcbxqZv i¶vi ‡¶‡Î me‡P‡q eo
Avcm¸wji g‡a¨ GKwUÓ wn‡m‡e eY©bv K‡i|
gvwK©b KZ©…c‡¶i AvBbRxexiv e‡jb ‡h, Gme Z_¨ c«Kv‡ki d‡j AvdMvwb¯—vb I Biv‡Ki A‡bK bvgx e¨w³‡K "gvivZ¥K ¶wZ, wbh©vZb ev GgbwK g…Z¨yi SyuwK‡Z" ‡d‡j‡Q|
wg. A¨vmvÄ Aek¨ ‡Rvi w`‡q e‡jwQ‡jb ‡h
Gme bw_ gvwK©b mk¯¿ evwnbx KZ©…K ¸i“Zi
Ab¨v‡qi Z_¨ c«Kvk K‡i‡Q Ges Zvi wei“‡× Kiv gvgjv ivR‰bwZKfv‡e D‡Ïk¨c«‡Yvw`Z|
Zvi wei“‡× ms‡e`bkxj Z_¨ msM«n Ki‡Z mvgwiK evwnbxi ‡WUv‡e‡R c«‡ek Kivi lohš¿ Kivmn 18wU Aciv‡ai Awf‡hvM Avbv nq|
gvwK©b KZ©…c¶ wg. A¨vmvćK hy³iv‡ó« wdwihq Avbvi Rb¨ c«Z¨c©‡Yi c«wµqv ïiæ K‡i|
Zvi AvBbRxexiv ej‡Qb, ‡`vlx mve¨¯— n‡j wg. A¨vmv‡Äi 175 eQi ch©š— Kviv`Ê n‡e|
Z‡e hy³ivó« miKvi ej‡Q, Zvi Pvi ‡_‡K Qq eQ‡ii mvRv nIqvi m¤¢vebvB ‡ewk|
Rywjqvb A¨vmvćK ‡Kb hy³iv‡ó« cvVv‡bv nqwb?
GKvwaK Av`vj‡Zi ïbvwbi ci 2019 mv‡ji hy³iv‡ó«i c«Z¨c©‡Yi Aby‡ivawU gÄyi Kiv nh‡়wQj, Z‡e wg. A¨vmvÄ ‡mB wm×vš— D‡ë
‡`Iqvi Rb¨ ‡ek K‡qK eQi a‡iB jovB K‡i‡Qb| c…_K GKwU Aciv‡ai Rb¨ Zv‡K 2019 mv‡j jÛ‡bi D”P wbivcËv m¤úbœ ‡ejgvk© KvivMv‡i cvVv‡bv nq| cjvZK _vKvi BwZnv‡mi Kvi‡Y
hy³iv‡ó« c«Z¨c©‡Yi gvgjv PjvKvjxb Zv‡K ‡mLv‡b ivLv nq| gvbwmK ¯^v‡m&n¨i AebwZi Kvi‡Y hy³iv‡ó«i KvivMv‡i wZwb AvZ¥nZ¨v Ki‡Z cv‡ib, Ggb `vwe LvwiR K‡i w`‡q 2021 mv‡j we«‡U‡bi nvB‡KvU© ivq ‡`q ‡h Zv‡K c«Z¨c©Y Kiv DwPZ| Gici 2022 mv‡j, mywc«g ‡KvU© ‡mB wm×vš— envj iv‡L Ges we«‡U‡bi ZrKvjxb ¯^ivó«gš¿x c«xwZ c¨v‡Uj c«Z¨c©‡Yi Av‡`kwU wbwðZ K‡ib|
Av`vj‡Zi c~e©eZ©x GKwU iv‡qi ch©v‡jvPbv Ki‡Z ïbvwbi Rb¨, ‡hwU Zvi Avwcj Kivi AbygwZ c«Z¨vL¨vb K‡iwQj, wg. A¨vmvÄ 2024 mv‡ji 20 I 21‡k ‡de«yqvwi nvB‡Kv‡U© ïbvwb‡Z Ask ‡bb| Zvi mg_©Kiv ej‡Qb GwU nq‡Zv Zvi ‡kl AvBwb P¨v‡jÄ n‡Z cv‡i| hw`I, Zvi AvBbRxexiv c«Z¨c©YwU AvU‡K ‡`qv DwPZ e‡j ivq ‡`qvi Rb¨ BD‡ivwcqvb ‡KvU©
Ae wnDg¨vb ivBUm ev gvbevwaKvi welqK BD‡ivcxq Av`vj‡Z Av‡e`b K‡i‡Qb| wKš‘ hy³iv‡ó« ‡diZ cvVv‡bvi cwie‡Z© we«‡U‡bi ga¨¯’Zvq Ggb GKwU mg‡SvZv nq ‡h, wg. A¨vmvćK Avi hy³iv‡ó« wM‡q Kviv‡fvM Ki‡Z n‡e bv| eis wZwb gvwK©b GKwU Av`vj‡Z wb‡Ri ‡`vl ¯^xKvi K‡i ‡b‡eb|
wewbg‡q G‡Zw`b a‡i KvivMv‡i _vKvi welqwU Zvi kvw¯— wnmv‡e MY¨ n‡e Ges wZwb gy³ e¨w³ wnmv‡e A‡÷«wjqvq wd‡i ‡h‡Z cvi‡eb|
Kxfv‡e mg‡SvZv n‡qwQ‡jv ‡kl ch©š— GwU n‡jv K~UbxwZ, ivRbxwZ I AvB‡bi GKwU wgk«Y, hvi d‡j wg. A¨vmvÄ A‡÷«wjqv ‡h‡Z I gyw³ cvIqvi j‡¶¨
‡mvgevi hy³iv‡R¨ jÛ‡bi GKwU wegvbe›`‡i wM‡q c«vB‡fU wegv‡b DV‡Z m¶g nb| BKy‡qWi `~Zvev‡m mvZ eQ‡ii ‡¯^”Qv e›`x Ges cvuP eQi AvUK _vK‡Z eva¨ _vKvi ci ‡h mg‡SvZvq Zvi gyw³ G‡jv ‡mwU n‡Z
GKwU `j IqvwksU‡b wM‡q mivmwi hy³iv‡ó«i Ks‡M«‡m G wb‡q Z`wei K‡i| c‡i c«avbgš¿x wb‡RB mivmwi welqwU ivó«xq md‡i wM‡q ‡Rv evB‡W‡bi Kv‡Q DÌvcb K‡ib|
Gici cvj©v‡g‡›U GK ‡fv‡U GKwU c«¯—v‡e hy³ivó« I hy³iv‡R¨i Kv‡Q Av‡e`b Rvbv‡bv nq hv‡Z K‡i wg. A¨vmvÄ A‡÷«wjqvq wdi‡Z cv‡ib|
Gici bvbv ZrciZv ‡k‡l AvB‡bi welqwU Av‡m| hy³iv‡R¨i nvB‡KvU© GK wb‡`©kbvq e‡j ‡h wg. A¨vmvÄ bZyb K‡i Av‡e`b Ki‡Z cvi‡eb| mg‡SvZvi wel‡q Bw½Z Av‡m Av‡gwiKvb‡`i w`K ‡_‡KI| Gwc«‡j ‡Rv evB‡Wb Rvbvb wZwb wePvi c«wµqv evwZj Ki‡Z A‡÷«wjqvi Aby‡iva we‡ePbv Ki‡Qb| hy³iv‡ó«i K~UbxwZKiv A‡÷«wjqvi mv‡_ m¤úK© myi¶vq AvM«nx| aviYv Av‡Q ‡h evB‡Wb c«kvmb b‡f¤^‡ii wbe©vP‡bi Av‡MB welqwUi wb®úwˇZ AvM«nx wQ‡jb| Rywjqvb A¨vmvÄ ‡Kb GKy‡qW‡ii `~Zvev‡m _vK‡Zb? myBwWk KZ©…c¶ 2010 mv‡j wg. A¨vmvćK ‡`‡k _vKvKvjxb GKRb bvix‡K al©Y Ges Ab¨ GKR‡bi kxjZvnvwbi `v‡q Awfhy³ K‡i Ges Zvi wei“‡× ‡M«ßvwi c‡ivqvbv Rvwi K‡i|
Desk Report: